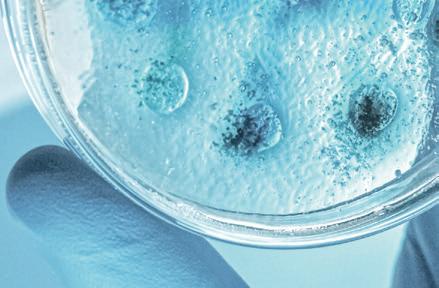
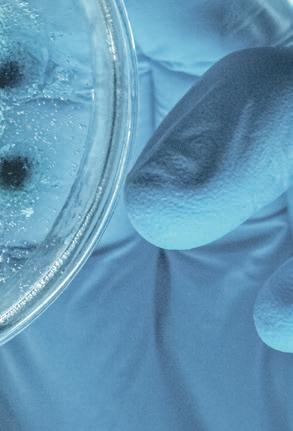

Grün-undParkanlagenfallenunterdiesogenanntenfreiwilligenLeistungen–hierkönntedieKommunalaufsichtden Rotstiftansetzen.Foto:FlorianHelfert

VonFlorianHelfert› „Sameprocedureaseveryyear.“OberbürgermeisterAdolfKesselstellte amDonnerstagnachmittagim StadtratdiewichtigstenEck-






























WORMS:





















punktefürdieHaushaltsplanung2023vor:Nachwievorwird gegendasGebot,einenausgeglichenHaushaltvorzulegen,verstoßen.„Berücksichtigtmandie
Fehlbeträgeseit2012bis2021“, sodasStadtoberhauptinderAuladerHochschulealsSitzungsort,„ergibtsicheindurchschnittlicherFehlbetraginHöhevon

circazehnMillionenEuro“.AktuellplantdieStadtimErgebnishaushaltbeiGesamterträgenvon rund325,6MillionenEuround Gesamtaufwendungenvonrund 336,5MillionenEuroeinenvoraussichtlichenJahresfehlbetrag 2023vonungefähr10,9MillionenEuro.MittelsdesneugeregeltenKommunalenFinanzausgleichskönnteihmzufolgemit voraussichtlichenMehrerträgen von32MillionenEurogegenüberdemVorjahrgerechnetwerden.„WärendieunszustehendenZuweisungendesLandesbereitsfrühergeflossen,hättedie StadtWormsbereitsinderVergangenheitausgeglicheneHaushalteausweisenkönnen“,befand AdolfKessel.











LesenSieweiteraufSeite4















DiemagischfunkelndeWeihnachtsshow


mantischeundfeierlicheVorstellunggefasstmachen.Auchder Zelt-PalastmiteinerHöhevon22 MeternlädtzumStauneneinund bildetdurchseineaufwendige KonstruktioneineneindrucksvollenRahmenfürdiezahlreichen Darbietungen.TicketsfürdieweihnachtlichinszenierteShowgibtes imInternetunterwww.circusCircusCristallogastiertvom22.Dezemberbiszum8.Januar2023aufdemFestplatz
cristallo.de,beiderCircus-TicketHotlineunter0176/32307374,bei allenbekanntenReserviX-Vorverkaufsstellen,unterderReserviXHotline01806/700733(0,20€inkl. MwSt.proAnrufausallendeutschenNetzen)sowieseitdem1. Dezembertäglichvon12bis19 UhranderCircuskasseaufdem WormserFestplatz.








DieGratis-ZeitungfürdasNibelungenland Samstag,17.Dezember2022,50.Woche,39.Jahrgang|Auflage:59.225verteilteExemplarePrinz-Carl-Anlage20·67547Worms·Tel.(06241)9578-0·www.nibelungen-kurier.de Zahnmedizin st Vertrauenssache Deshalb nehmen wir uns in ruhiger Umgebung viel Zeit für ausführliche Beratung und Behandlung. JETZT TERMN VEREINBAREN Lindenallee 16 | 67549 Worms | 06241 / 7288 | termine@dentisanum.de Qualität und Kompetenz in Sachen Immobilien Seit über 40 Jahren vermitteln wir erfolgreich für unsere Kunden. Auf das stets hinzu gewonnene Know How können Sie sich verlassen. Möchten Sie verkaufen oder vermieten dann legen Sie Ihre Immobilien vertrauensvoll in unsere Hände. Wir beraten Sie gerne und freuen uns auf das Gespräch mit Ihnen. Herzlich willkommen. Mitglied im Immobilienverband Deutschland Neumarkt 7 • Worms • Tel. 06241 6961 WWW.DENSCHLAG.DE Ihr Makler für Rheinhessen wünscht einen schönen 4. Advent Zuverlässiger Partner für Verkauf, Vermietung und Verwaltung Ihrer Immobilie. Wir freuen uns auf Ihren Anruf. 22_50s Wir suchen für Sie: · Einfamilienhäuser · Mehrfamilienhäuser · Eigentumswohnungen · Bauplätze · Mietwohnungen Sachverständige für Immobilienbewertung D2 seit 1974 IMMOBILIEN Rebenich-Tiesler 22_50s Telefon (06241)2000835od.(0179)6939780 www.rebenich-worms.de·rebenich-tiesler@t-online.de Wirwünschen Ihnenbesinnliche Weihnachtstage. NicoleundHansTiesler Worms·Kämmererstraße 42· Nähe Ludwigsplatz 22_50s Wirhabenreduziert! WirdankenallunserenKundinnenundwünschenEuch schöneundharmonischeWeihnachten. www.dexheimer-worms.de WEITERE GERÄTE AUF Heiligabend kann kommen! MIT VOLLER KRAFT ABGESÄGT ... Fahrweg 100 67547 Worms Tel. 06241 45603 DE HEIMER Nutzfahrzeuge und Kleingeräte-Fachbetrieb GmbH & Co.KG JAHRE z.B. Polstergarnitur 3sitz, 2sitz,1 Sessel Abholpreis € 398,00 Sonderverkauf - Polstermöbel OFFICE SHOP Büromöbel Abholmarkt MÖBEL CHMIDT DamitRückenschmerzen erstgarnichtauftreten! Telefon(06241)7111 Mo.–Fr.,8.30–12.00Uhrund14.00–18.00Uhr 22_50s Marktplatz 21 . 67547 Worms . www.lichtbox-worms.de Marktplatz 21 . 67547 Worms . www.lichtbox-worms.de Dankefür2022 22_50s Treppen und Geländer für Neu- und Altbau Dirolfstraße 31 67549 Worms Tel. 06241 - 50 56 252 Fax 06241 - 50 56 253 info@treppenwelt-hormuth.de cf.26sa16 DerheutigenAusgabeliegen–inTeilenbzw.inderGesamtauflage–folgendeProspektebei: WirbittenumfreundlicheBeachtungunsererBeilagenkunden. DerCircusCristallogastiertvom 22.Dezemberbiszum8.Januar 2023miteinermagischfunkelndenWeihnachtsshowaufdem WormserFestplatz.Mitdabeihat ereineerleseneAuswahlanher-
nenGästekönnensichaufeinige ÜberraschungenimProgramm derweihnachtlichinszenierten Showfreuen.OhnegroßeTiere, abermitausgezeichnetenArtisten
vorragenden,internationalausgezeichnetenArtistenundClowns, diealleFansderManegebegeisternwerden.Diegroßenundklei-
sorgtderCircusCristallofürpure Unterhaltungundunvergessliche Momente.DieBesucherdürfen sichalsoaufeinespannendeund atemberaubende,aberauchro-
RundzehnMillionenEuroneueSchuldenproJahr
WORMS: StadtratverabschiedetHaushalt2023/ZehnGroßbetriebezahlenmehralsdieHälftederGewerbesteuer
TERMINE
Konzertder Versöhnungsgemeinde
Dieev.VersöhnungsgemeindeNeuhausenlädtein zuMusikzumviertenAdvent amheutigenSamstag,dem 17.Dezember,um18Uhrin dieev.KircheinderStiftstraße.MitwirkendesindVoxAngelicaErdmuteRuff,Orgel, HeikeBüchler,Saxophon, BandderFreienevangelischenGemeindeWorms,PosaunenchorderStadtmission,OlgaLasarev,Klavier.
LetzteChancenfür UNICEF-Grußkarten
AmDienstag,dem20.Dezember,von10bis12Uhr werdenimUNICEF-Büro zumletztenMalvorWeihnachtendiebeliebtenUNICEF-Weihnachtskartenverkauft.
Weiterhingibtesdanach nocheinekleinereAuswahl anWeihnachtskartenbeiBürobedarfBetz,Buchhandlung ThaliaundinderPostfiliale inderKaiserPassage.
Bürgersprechstunde MdBJanMetzler
DerBundestagsabgeordneteJanMetzlerlädteinzuseinernächstenBürgersprechstundeamMittwoch,dem21. Dezember,von10bis12Uhr imBürgerbüroWorms,Weckerlingplatz1.EineAnmeldungistnotwendigunterTelefon030/227-72179,perMail an jan.metzler@bundestag.de oderonlineunter www. janmetzler.de/sprechstunde
Vorsorge-Sprechstundedes Betreuungsvereines
JeweilsamzweitenDonnerstageinesMonatsfindet inderZeitvon15bis18Uhr imMGHMonsheimdiekostenloseSprechstundedurch denBetreuungsvereindesDiakonischenWerkesWormsAlzeye.V.,statt.Dernächste Terministam12.Januar 2023.BittenurmitVoranmeldung(telefonischoderper Mail)überdasMGH-Büro (Mail: mgh.monsheim@ekhn. de oderTel.06243/6165). WährendderWeihnachtspausekanndieAnmeldungper E-Mailerfolgenodereskann eineNachrichtaufdemAB hinterlassewerden.AbMontag,dem9.Januar2023wird danneineAntworterfolgen.
„OffenerGesprächskreis Pflege“
Der„OffeneGesprächskreisPflege“findetjeden zweitenMontagimMonat von16bis18UhrindenRäumendesMGHMonsheim (Hauptstraße111,67590 Monsheim,OrtsteilKriegsheim,Raum„AlterKindergarten“)statt.DerGesprächskreiswirdvoneinererfahrenenFachkraftdesPflegestützpunktesOsthofengeleitet.
InFortsetzungdesDezemberterminswirdamMontag, dem9.Januar2023,nocheinmalandasThema„Demenz bzw.Gedächtnis-undOrientierungsstörungen“fürBetroffeneangeknüpft.
BeiRückfragenkannman sichnachderWeihnachtspauseabdem9.Januar2023 andieKoordinatorinSabine Bayerwenden(mgh.monsheim @ekhn.de oder06243/6165 (AB)oder015756789149).EineAnmeldungistnichterforderlich.
Hospiz-DachterrasseerreichtZielsumme
gehtumeineUmgebungdie LebensqualitätfüreinenunheilbarkrankenMenschen schafft.WirdankenjedemUnterstützerunddemFördervereinfürseinbemerkenswertes Engagement.“DieÖkumenischeHospizhilfebietetabsoforteineTrauerbegleitungvon KindernundJugendlichenan. WenneinFamilienmitglied verstirbt,istesimmereinebelastendeSituation.„Gerade KinderundJugendlichesind damitoftüberfordertundmüssendenUmgangmitTrauer ersterlernen“,sagtDr.Ulrike Löffler,2.VorsitzendedesFördervereinsderÖkumenischen HospizhilfeundInitiatorindes neuenBereichesderÖkumenischenHospizhilfe.
AUSDEMPOLIZEIBERICHT
MithilfederEWR-Crowd konntenfürdieAusstattungder barrierefreienDachterrasseder Hospizhilfemehrals5.000Eurogesammeltwerden.Aufder neuenDachterrasseundder ZimmererweiterungdurcheinenBalkonerhaltendiePatienteneinenPanoramablickweit überdieStadtgrenzenhinaus. „AndiesemOrtsinddieGäste biszumEndeumgebenvonLeben“,erzähltKathrinAnklamTrapp,VorsitzendedesFörder-

vereinsÖkumenischeHospizhilfe.VomgespendetenGeld überdieEWR-CrowdsollenaußerdemMöbelangeschafftwerden.
EWR-PressesprecherDominikNagelfreutsichmitdem Verein,dassmitUnterstützung zahlreicherSpendendensowie EWRdasAngebotimstationärenHospizimHochstiftweiter wachsenkann:„Hinterdem Projektstecktvielmehralsnur eineschöneDachterrasse.Es
DieCrowdfunding-Plattform desregionalenEnergiedienstleistersEWRAGhatbereits über1.000Unterstützerinnen undUnterstützererreicht.Die digitaleCrowdfunding-PlattformstarteteimApril2022und erreichtnachsiebenMonaten eineSpendensummevon 100.000Euro.DieEWRAGunterstütztdieregionalenProjektemiteinemmonatlichenFördertopfinHöhevon1.000Euro. DamitwerdenabeinemSpendenbetragvon10Euroweitere 10EuroausdiesemTopfdazugegeben.Zudemunterstützt derEnergiedienstleistermiteinemStarterbonusvon500Euro fürdieersten30erfolgreichabgeschlossenenProjekte.
SchaufensterundGlastür beschädigt
POL-PDWO:Worms(ots)–ImZeitraumvonDienstag, dem13.,um18.30Uhr,bis Mittwoch,dem14.Dezember, um4.30Uhr,wurdediegläserneEingangstüreinerBäckereifilialeinderVon-Steuben-StraßedurcheinenSchlagoder denWurfeinesunbekannten Gegenstandesbeschädigt.Am MittwochwurdeimZeitraum
zwischen2und3Uhrdie SchaufensterscheibeeinesGeschäftesinderKämmererstraßebeschädigt.
WersachdienlicheHinweise gebenkann,wirdgebeten,sich unterTelefon06241/852-0zu melden.Hinweisekönnen auchperE-Mailan piworms @polizei.rlp.de übermitteltwerden.
Taschendiebstahlauf offenerStraßeinWorms
Worms(ots)–InderMainzerStraßeinWormskames amMittwoch,dem14.Dezember,gegen22.30Uhr,zum DiebstahleinerTascheaufoffenerStraße.
Eine55JahrealteFrauaus Wormsliefzusammenmit ihrer52JahrealtenBegleiterin dieMainzerStraßeentlang,als sievonzweiMännernzuFuß überholtwurden.
Kurzdaraufverabschiedeten sichbeideFrauenetwaaufHöhederHeidenhainstraße,als
dieunbekanntenMännernun wiederaufsiezukamen.Im Vorbeilaufenentrisseinerder Männerder55JahrealtenFrau eineUmhängetaschemiteinemschnellenGriffvomKörper,sodassdiesenichtreagierenkonnte.BeideMännerflohenanschließendinRichtung Heidenhainstraße.WerHinweisezurTatoderdenunbekanntenMännerngebenkönnen,wirdgebeten,sichmitder PolizeiinspektionWormsin Verbindungzusetzen.
EinbruchinEinfamilienhaus inOsthofen
Osthofen(ots)–BislangunbekannteTätersindamMittwoch,dem14.Dezember,in derZeitzwischen18.15und20 UhrineinEinfamilienhaus „AufderRosselshecke“eingebrochen.
DeroderdieTätermachten sichaneinerzumrückwärtigenGartengelegenenTerrassentürzuschaffenundgelangtensoinsInnere.
Dortdurchsuchtensiealle RäumedesHausesnachWertgegenständen.NacherstenErkenntnissenwurdenSchmuckstückeinnochunbekanntem
Wertentwendet.DieWormser KriminalpolizeihatdieErmittlungenaufgenommenundbittetumMithilfe.
WerimbesagtenTatzeitraum„AufderRosselshecke“ verdächtigeWahrnehmungen gemachthat,wirdgebeten, sichmitderKriminalinspektionWormsunterTelefon 06241/852-0inVerbindungzu setzen.Hinweisekönnenauch perE-Mailan kiworms@polizei. rlp.de andiePolizeiübermittelt werden.derPolizeiinspektion WormsinVerbindungzusetzen.
UnfallfluchtnachKollision mitVerteilerkasteninEich
Seitdem24.Septemberlockt dieSonderausstellung„Spiel umdieMacht.VonCanossa nachWorms“imMuseumder StadtWormsimAndreasstift durchihreVielseitigkeitBesucherunterschiedlicherZielgruppenan:EineGraphicNovel,einEscapeGameundeindrucksvolleLeihgabenbeleuchtendieunterschiedlichenFacettendesInvestiturstreitsund vermittelnspielerischundmodernZugängezumWormser Konkordat.
HohesInteresse
Am30.DezembersolltenBesucherdieletzteGelegenheit haben,sichaufeinespannende Entdeckungsreisezubegeben, dochnunstehtfest:DieAusstellungwirdbiszum12.März 2023verlängert.Besondersder positivenResonanzunddem hohenInteresseandemwichtigenstadtgeschichtlichenThemamöchtendieVerantwortlichendadurchnachkommen.
AuchwertvolleLeihgabenwie beispielsweisederSarkophag KaiserHeinrichsV.ausdem Dom-undDiözesanmuseum imHistorischenMuseumder PfalzinSpeyeroderderRing desMainzerErzbischofsAribo ausdemBischöflichenDomundDiözesanmuseumMainz, werdenwährendderVerlängerungweiterhinzusehensein.
DerwissenschaftlicheLeiter desMuseumsderStadtWorms imAndreasstift,Dr.OlafMückain,betontdieguteZusammenarbeitmitallenPartnern:„Wir sindwirklichsehrdankbardarüber,dassalleLeihgebereiner Verlängerungzugestimmthaben.BesondersSchulklassen möchtenwirdadurchdieMöglichkeitbieten,auchweiterhin dasmoderneundinnovative Ausstellungskonzeptzuerleben.“VerwaltungsleiterinUlrikeBreitwieserergänzt:„NachdemdiePlanungfürdasJahr 2023nunfeststeht,freutesuns sehr,aufgrundderdurchweg positivenResonanzdieAusstel-
lungverlängernzukönnen.Die AusstellungwurdemitvielAufwandkonzipiertundsowohldie AbwicklungdesLeihverkehrs alsauchdieEinbautenerfordertenvieleRessourcen.DieVerlängerungderSonderausstellungistdaherganzimSinne derNachhaltigkeit.“

ÖffentlicheFührungen
AuchimneuenJahrteilendie WormserGästeführerbeiden ÖffentlichenFührungenaninsgesamtdreiTerminenihrFachundHintergrundwissenmitinteressiertenBesuchern.Dabei gebensieauchdieeinoderandereAnekdotezumBesten.Kosten:4EurozuzüglichEintritt. Termine:8.Januar2023,5.Februar2023und5.März2023, jeweilsum11.30Uhr.Ticketsfür dieFührungengibtesander Museumskasseundunter www. museum-andreasstift-tickets. de.FürdieNutzungdesEscapeGamessindeinSmartphonesowieKopfhörernotwendig.
Eich–EinbislangunbekannterUnfallverursacherbefuhramMittwochdieGernsheimerStraße,alseraufHöhe derEinmündung„ImWäldchen“witterungsbedingtins Rutschenkamundmiteinem angrenzendenVerteilerkasten kollidierte.
EineZeuginkonntedaraufhinbeobachten,wiedrei„jungeMänner“kurzausstiegen undsichdenSchadenamVerteilerkastenansahen,bevorsie
schließlichvonderUnfallstelle flüchteten.BeidemFahrzeug sollessichumeinengrauen Kombigehandelthaben.
WersachdienlicheHinweise zumUnfallverursacher,den InsassenoderdemFahrzeug machenkann,wirdgebeten, sichmitderPolizeiinspektion WormsunterTelefon06241/ 852-0inVerbindungzusetzen.

Hinweisekönnenauchper E-Mailan piworms@polizei.rlp. de übermitteltwerden.
Worms–AmMittwochgegen13Uhrwareine36-jährige WormserininderGaustraße unterwegs.Alssievorder KreuzungGaustraße/Eckenbertstraßeverkehrsbedingt bremsenmusste,kamihr FahrzeugaufgrundderStraßenverhältnisseinKombinationmitvorhandenenSommerreifeninsRutschen.
InderFolgekollidiertesie miteinemvorihrzumStehen
gekommenenPkw,welcher aufeinweiteresFahrzeugaufgeschobenwurde.DieFahrerindesmittlerenPkw,eine41jährigeWormserin,wurde durchdenAufprallleichtverletzt.
Die36-jährigeUnfallverursacherinmusssichnunineinemStrafverfahrenwegen fahrlässigerKörperverletzung verantworten.DieWeiterfahrt wurdeihruntersagt.
2 LOKAL-NACHRICHTEN NIBELUNGENKURIER| Samstag,17.Dezember2022
EWR-CROWD: Mehrals5.000EurofürbarrierefreieGrünzonegesammelt TrauerbegleitungfürKinderundJugendlichestartet
ANDREASSTIFT: „SpielumdieMacht.VonCanossanachWorms“verlängertbis12.März
ImMuseumderStadtWormsimAndreasstiftlädtdieverlängerteSonderausstellungrundumdenInvestiturstreitunddas WormserKonkordatnunbiszum12.März2023ein.Foto:BernwardBertram
PositiveResonanzzurSonderausstellung SteffenBurdack,AnikaHammundDr.UlrikeLöfflervomFördervereinÖkumenischeHospizhilfeWormse.V.übernehmendie„Finisher-Urkunde“derEWR-
CrowdvonPressesprecherDominikNagel(vonlinks).Foto:EWR
Strafverfahrenwegen fahrlässigerKörperverletzung
KaffeeklatschmitBingo
AmMittwoch,dem21.Dezember,von16bis19Uhr,lädtder HamburgerTor-Vereinzueinem Weihnachtsmarkt-Specialindie Bärengasseein.ZudiesemletztenKaffeeklatschdesJahressind



allerechtherzlicheingeladen.Es gibtnebenKaffeeundKuchen andiesembesonderenMittag auchwiederdasbeliebteBingoSpielmitkleinenÜberraschungen.
Anliegenmitteilen
DienächsteSprechstundedes Behindertenbeauftragtenfindet amMontag,dem19.Dezember, 11bis13Uhr,imRathaus,Raum 23,statt.EinevorherigetelefonischeTerminvereinbarungisterforderlich.„WeranderSprechstundeam19.Dezemberteilnehmenmöchte,meldetsichbitte


telefonischunter06241/8535718, hinterlässtNamenundRückrufnummeraufdemAnrufbeantworterundichrufezurVereinbarungeinesTerminsumgehend zurück“,soBehindertenbeauftragterWolfgangSchall.AufdiesemWegkönnenInteressierte jederzeitihreAnliegenmitteilen.






WESTHOFEN
Spendenbeim Weihnachtsmarkt
BeimWeihnachtsmarktin WesthofensindvieleSpendenzusammengekommen. DurchdenErlösdesFlohmarktesderev.KirchengemeindekonntenandieHospizhilfeEppelsheimundden GnadenhofinWormsjeweils 700Euroüberwiesenwerden.
Dieverbleibenden700EurogehenzugunstenderOrgelrestaurierung,diedieKirchengemeindezumgroßen Teilalleinetragenmuss.

HOCHSCHULE: AlumniundStudierendetauschtensichaus Terminfür2023schonnotiert
PositiveResonanzbeim Alumni-Treffen

InKontaktzukommen,damit hatteniemandSchwierigkeiten. DieserTagisteinGarantfür schöneBegegnungen,WiedersehenmitaltenFreunden,Austauschundzugleichaucheine innovativeSchnittstelle.Schon mitEintreffenderGästeliefen dieGesprächeaufHochtouren. Unddas,obwohlsicheinige AbsolventinnenundAbsolventen wieauchProfessorenundLehrbeauftragtevieleJahrenicht mehrgesehenhatten.Inihren BegrüßungswortenhießenProf. RobertMünscherundProf.Olaf Rieckdie80Gästeherzlichwillkommenunddanachübernahm dieModerationindiesemJahr MarcusJacob,einehemaliger IBA-Student.AlsReferentinnen undReferentendesAbendswarenIBAAlumniSabineMeierer, KemalKösemehmetoglu,Lea BackundCorinnaHaasaufder Bühne.Auchwennnichtselbst vorOrtanwesend,sowurdevon AlumnusAyferGonulzumAbschlussdesoffiziellenTeilsein beeindruckendesVideoaus Istanbuleingespielt.DieBerich-

tederReferentenzeigen,auf welchunterschiedlicheArtund WeisesichdiejungenMenschen nachihremStudiumander HochschuleWormsberuflich entwickelthaben.EsgabEmpfehlungenundTippsauserster Hand.DieEhemaligeninformiertendieaktuellStudierenden,eingroßerMehrwertdieser wichtigenVeranstaltung.

Terminfür2023 schonnotiert
DassdieVeranstaltungeinvollerErfolgwar,wirddurchdiepositiveResonanzdeutlich.Gerade odertrotzderherausfordernden ZeitensinddieseRäumefürBegegnungenbesonderswichtig. SchonjetzthabenalledenTerminfürdasWiedersehenin2023 inihreKalendereingetragen, dennam11.Novemberwirdes wiederdenAußenwirtschaftstag geben.GanzbesondererDank galtallenBeteiligten,diedas EventmitihremEngagement überhaupterstmöglichgemacht haben.




KindertreffOffsteinöffnetwieder
DerKindertreffOffsteinimEv. GemeindehausistabMontag, dem9.Januar2023,jeweilsmontagsvon16bis18Uhr,geöffnet.
ALZEY-WORMS
Wohngeldstelle
eingeschränkterreichbar
DieEinführungdesneuen WohngeldsabJanuar2023 stelltdieWohngeldstellenvor organisatorischeHerausforderungen.Daheristdie WohngeldstellederKreisverwaltungAlzey-Wormsnur eingeschränkterreichbar. Vonmontagsbismittwochs sinddieMitarbeiterlediglich vormittagstelefonischzuerreichen.WerinderKreisverwaltungpersönlicherscheinenmöchteodermuss,wird dringendgebeten,vorabeinenTerminzuvereinbaren. MittwochsbleibtdieWohngeldstellegeschlossen.
VorverkaufNarrhallaDamensitzungen
DievorbestelltenEintrittskartenfürdieNarrhalla-Damensitzungen2023liegenseitdem15. Dezemberbeim„ShopamDom“ amNeumarkt14zurAbholung bereit.FürdieSitzungenam28. Januar,5.,10.und11.Februar sindebenfallsnochRestkarten
zumPreisvon22Euroimfreien Verkauferhältlich.Diesekönnen perE-Mailüber info@wormsernarrhalla.de,überdasTicketportal unter www.tickets.wormser-narrhalla. de odertelefonischunter06241/ 8549127sowieim„Shopam Dom“erworbenwerden.

Samstag,17.Dezember2022| NIBELUNGENKURIER NIBELUNGENKURIER 3 Außerdem:WEIHNACHTSBÄUMEzumSelbstschlagen am2.,3.und4.AdventswochenendeinSchönbornbeiRockenhausen! Großer Christbaum-Verkauf auf dem Festplatz! Deutsche EDEL-TANNEN UNSEREeigenenBäume–sind garantiert ungespritzt,unbehandelt und frisch geschlagen EDEL-TANNEN ab 5,–EUR Worms, Am Festplatz seit Freitag, 2.Dezember 2022 UnsereÖffnungszeiten: Mo.–Sa.9–17.30Uhr So.10–16Uhr 22_48s Landmetzgerei Kratz Friedrich-Ebert-Str. 18 · 67574 Osthofen Tel. (0 62 42) 79 15 · Fax (0 62 42) 6 09 28 www.landmetzgerei-kratz.de Unsere Öff nungszeiten: Mo.–Fr.: 6.30–18 Uhr · Sa.: 6.30–13 Uhr * Nur solange Vorrat reicht – Irrtum vorbehalten pro Portion UnsereAngebote:Do.22.12.bisMi.28.12.2022*
Frische Leberwurst –herzhaft–Frisches Schweinehackfleisch Hausmacher Grillschinken ausdermagerenNuss je100g €0,99 je100g €0,89 je100g €1,49 22_50s BittebeachtenSieunsergesondertes WEIHNACHTSANGEBOT! WIR WÜNSCHEN UNSEREN KUNDEN UND FREUNDEN FROHE FESTTAGE UND EIN GESUNDES 2023 Worms-Pfiffligheim, Alzeyer Straße 242–244 Tel. (0 62 41) 97 54 90, Öffnungszeiten: Mo.-Sa. : 8–21 Uhr UNSERE ÖFFNUNGSZEITEN am 24.12.: 7 bis 13.30 Uhr | 31.12.: 8 bis 15 Uhr 22_50s JUWELIER GOLDBÖRSE Am Römischen Kaiser 8 · 67547 Worms Telefon (0 62 41) 3 09 56 70 · www.goldankauf-24.eu ANKAUF von Goldschmuck | Altgold Bruchgold | Zahngold | Goldmünzen | Goldbarren Zinn | Silber und versilbertes Besteck Seit 1957 22_22m AutoGreiss www.auto-greiss.de Wir wünschen Ihnen allen ein frohes Weihnachtsfest, glückliche Momente mit Ihren Familien und vor allem ein gesundes sowie erfolgreiches Jahr 2019! Fahrzeugservice & Reifenhandel Westhofen Karosserie- & Lackierzentrum Dittelsheim-Heßloch WirwünschenIhnenalleneinfrohesWeihnachtsfest, glücklicheMomentemitIhrenFamilienundvorallem eingesundessowieerfolgreichesJahr2023! Piercing Ink Cooperation since 1 April 1992 Piercing·Piercingschmuck· Tunnels DermalAnchors· SkinDivers ·O´DonnellMoonshine ·Spirituosen Öffnungszeiten:Mo , 14 bis 21 Uhr•Di bis Do., 12 bis 19 Uhr• Fr 10 bis 16 Uhr· Sa 11 bis 16 Uhr Piercing Ink Cooperation· Gaustraße 32 67547 Worms·Fon(062 41) 97 38 54 BesuchenSieunsauf www facebook com/ piercingstudio1, www piercingstudio1 com 2 _47s !!!Gutscheinewerdenaufgewertet!!! aus€50,–werden€55,–aus€100,–werden€115,–Am24.12und31.12bleibt dasStudiogeschlossen Gültigbis30.12.2022 CrazyX-MasDays AllePiercings€25,–auchalsGutschein O´DonnellSpecials 700ml statt€24,90 nur€22,–350ml statt€14,90 nur€13,–RATHAUS: SprechstundedesBehindertenbeauftragten am19.Dezember
UnserMittagstischvom19.bis21.12.2022ab11.30Uhr Mo.GrobeBratwurst mitSchwenkkartoffelnundRahm-Karotten €6,90 Di.Gyros mitPommes,TsatzikiundKrautsalat €6,90 Mi.Putengeschnetzeles mitReisundSalat €6,90 Do. KeinMittagstisch Fr. KeinMittagstisch
Weihnachtsmarkt-Special am21.Dezembervon16bis19Uhr
HAMBURGERTOR-VEREIN:
SpannenderfachlicherAustauschunddieidealeGelegenheit,dieNetzwerkezu pflegen,dasmachtdenAußenwirtschaftstagaus.Foto:NesibeÖzer
DasHaushaltsjahrbezeichneteerals„Ausnahmejahr“:Noch immervonCoronabeeinflusst, würdenjetztzudemdiefinanziellenFolgeneines„sinnlosen Eroberungskrieges“sichtbar.
Unteranderemrechnetdie VerwaltungmitPreissteigerungenvonrundneunMillionen EurobeiderBauunterhaltung. „DieAufwendungensteigensomitauf29,2MillionenEuro,die wirdringendinvestierenmüssen“,erklärteKessel.
Klumpenrisikobeider Gewerbesteuer
AuchdieGewerbesteuerbereitetSorgen:„Beiderwichtigsten kommunalenEinnahmequelle rechnenwirmitcircaachtMillionenEurogeringerenErträgen“, soKesselweiter.Von1.998gewerbesteuerpflichtigenBetriebenzahlenzehnGroßbetriebe mehralsdieHälftederGewerbesteuer.„WennnureinesderUnternehmeninSchieflachegerät“,warnteer,„bekommenwir dasunmittelbarzuspüren“.
Argusaugenwachenüber Haushalt
„SpätestensbeimHaushalt 2024werdenwirunserneutmit derHebesatzerhöhungbeschäftigenmüssen“,führtederOberbürgermeisteranschließend aus.DieseErwartungseiihm seitensderKommunalaufsicht
kommuniziertworden–essei denn,eswürdenandereWege füreinenausgeglichenenHaushaltgefundenwerden.Hiervon ausgehendnahmdasStadtoberhauptan,dasskünftignochviel stärkerabgewogenundKompromissegefundenwerden müssten.
„Vielleichtmüssenwiruns auchvonStandardsverabschiedenundunsinVerzichtüben.“ RegelmäßigimFokusderKommunalaufsichtsinddiefreiwilligenLeistungenderLutherstadt.Hierunterfallenzum BeispielGrün-undParkanlagensowieInstitutionenwieetwaBibliothek,Musik-und Volkshochschule.Veranschlagt wurdenhierfürknappüber23 MillionenEuro.Allerdingsbleibeesabzuwarten,wiedieAufsichtsbehördediesangesichts desdefizitärenHaushaltesbewertenwerde.
WenigerBrachenim Stadtbild

„Wirhattenimvergangenen JahrinZeitenvonCoronagehofft“,eröffnetesodannCDUFraktionsvorsitzenderDr.Klaus KarlindieDebattederFraktionen,„diewirtschaftlichundgesellschaftlicheinschneidende Krisezuüberwinden“.StattdessenlebemanaufgrunddesrussischenAngriffskriegesineiner Zeitenwende.AngesichtskommunalerKämpfemitsteigenden
PreisenundeinemwirtschaftlichenEinbruchäußerteersein Missverständnisgegenüberder Bundesregierungundihrer „Wohltaten“wieeiner„üppigen“ RentenerhöhungundBürgergeld.
EbensowienachfolgendeRednerbeklagteerchronischunterfinanzierteKommunen.„Statt Kommunenzugängelnundzu strangulieren,müssenPflichtaufgabenangemessenfinanziertwerden“,forderteer.Ganz konkretaufWormsbezogenlobteerunteranderem,dassesgelänge,BrachenwieetwadenAltenSchlachthof,dasLicht-Luftbad-oderauchdasDomquartier abzubauen.
KitasinPlanung
FürdieSPDstelltederenFraktionsvorsitzenderDirkBeyer ebenfallsaußergewöhnliche Rahmenbedingungenfest.Doch dankderNeuregelungdeskommunalenFinanzausgleichs durchdasLandkönneWorms mit32MillionenEurodeutliche erhöhteZuweisungenerwarten.
„AlsFraktionsindwirfroh, dassunsereDezernentenWaldemarHerderundTimoHorst sichbeimKita-Ausbausehreng abstimmen“,soBeyerweiter. DieKitasinderCarl-VillingerStraße,inRheindürkheimoder amBIZführteerbeispielhaft an.
Mehrgestaltenalsnur verwalten
RichardGrünewad,FraktionsvorsitzenderderGrünen,skizzierte,dassinAnbetrachtdes KlimawandelsenormeInvestitionenan-undausstündenwie beispielsweiseimFallederKanalisation.„WennwirÖPNV undRadwegeausbauenmöchten“,soGrünewaldergänzend, „müssenwirGeldindieHand nehmenundinderInnenstadt RaumfürKraftfahrzeugewegnehmen“.
ImHaushaltsahFWG-FraktionsvorsitzenderMathiasEnglert einWerkderVerwaltung,nicht desStadtrates,überwelches
dannauchnochdasDamoklesschwertderKommunalaufsicht schwebe.Erneutbekräftigeer seineAussagederDebatteim vergangenenJahr,dassder Oberbürgermeister,stattwievon ihmselbstangekündigtzugestalten,leidernurverwalte.
„Zubefürchtenist,dassdas, waswirverabschieden,nurein Wunschkonzertbleibt“,merkte LudgerSauerbornfürdieAfD alssechsterRednermitBlickauf dieKommunalaufsichtsowie immerwiederbereitgestellter, außerplanmäßigerMittelan.
SprudelndeSteuereinnahmen vorerstpassé
DieZeitsprudelnderSteuereinnahmenistausSichtdes FDP-FraktionsvorsitzendenDr. JürgenNeureuthervorbei.Entscheidendseies,bestehendeArbeitsplätzezusichernundneue zuschaffen.Zugunstendes Standortesseieszudemnötig, dieVerkehrsinfrastrukturinklusivegegebenenfallsderKrankenhaustangenteauszubauen–auchumdieInnenstadtvon Verkehrzuentlasten.
DerlangenAusspracheentzog sichFranzLieffertzalsMitglied desStadtrates;zumZeitpunkt seinesAufrufesalsRednerfür dieLinkenwarerscheinbarbereitsgegangen.BeisechsGegenstimmenundvierEnthaltungenverabschiedetedasGros desStadtratesdenHaushalt.
FÖRDERUNG: BildungsministerinHubigbewilligtmehrals 4,5MillionenEurofürbestefrühkindlicheBildung
meint„nichtperseisterdaerreichbar,abereinidealerZeitpunktihnindieHerzenzutragen!“
„ErstmalsgebenwirdasFriedenslichthierbeiSchneeweiter“ beschreibtSebastianBesierden kaltenAbendvormDom.Zukalt auch,umliveundvorOrtGitarre zuspielen.DemZeitgeistentsprechendsingenallevomausgeteiltenLiedblattmit,denndie Instrumentierung–inkl.Leadstimme–kommtvonderkabellosenBluetooth-Box.
BrauchausÖsterreich
JörgBürgisvom„Verband ChristlicherPfadfinderinnen undPfadfinder“beschreibtnoch einmaldenWegdesFriedenslichtes,dasssieinSpeyer„abgeholt“haben.DasORF-FriedenslichtausBethlehemistein Weihnachtsbrauch,der1986im ORF-LandesstudioOberösterreichinLinzimZusammenhangmitderORF-Hilfsaktion „LichtinsDunkel“insLebengerufenwurde.
„Ichfreuemich,dasswirzum JahresendedenAusbauderKindertagesbetreuunginunserem Landerneutmit4.792.121Eurounterstützenkönnen“,sagteBildungsministerinDr.StefanieHubiganlässlichderBekanntgabeder Förderungen.„Durchdie16AusundNeubaumaßnahmenwerden mehrals550neueBetreuungsplätzegeschaffen,daruntermehrals 80Kita-PlätzefürKinderunter2 Jahren.SowirddieguteVereinbarkeitvonFamilieundBerufgewährleistetunddieKleinsteninunseremLandbestmöglichgefördert undbetreut“,sodieMinisterin weiter.
KitainAlsheim wirdgefördert
VonRudolfUhrig› Nachdemdas FriedenslichtausBethlehem OberbürgermeisterAdolfKessel imRathausübergebenworden war,trafensichvieleJugendliche undjungeErwachseneamDonnerstagabendvordemSüdportal desDomes,umesineinerAndachtanalleMenschenguten Willensweiterzugeben.Inden nächstenTagenwirdalsobis WeihnachtendasLichtanverschiedenenOrteninWormsund imWonnegauübernommen–undnachHausegetragen–werden.DieFriedenslichtaktion 2022stehtunterdemMotto: „FriedenbeginntmitDir“.
EsbrauchtMut
Frieden–imGroßenwieim Kleinen–kannnurgelingen,
wennalleMenschenmitmachen. VordemSchrittzumHandeln stehendieFragen:Werbinich? Wasmöchteicheinbringen?Wie siehtesinmiraus?Sichfürden FriedeneinzusetzenisteineEntscheidung,diejedernurfürsich persönlichtreffenkann,dennjederkenntsichselbstambesten. MitjederEntscheidungfürden FriedenwächstdieChancedaraufweiter.DamitausdemFriedeninjedemEinzelneneinFriedeninallenMenschenwerden kann,brauchtesdenMut,sich aufdenWegzumachen.Diesen Mutmussjederinsichselbst finden.DeshalbbeginntFrieden miteinerEntscheidungundmit jedemeinzelnenMenschen. Mut,derunsjedenTagüberdie Medienerreicht,denIranerinnenaufbringen,Ukrainer,Af-
ghanenundja,bestimmtauch Klimaaktivisten.
„WasistFrieden fürdich…“?
DaherstelltauchAndreasBaadendieFrageindieRunde:„Was istFriedenfürdich…“?Ersagt „keineAngst,esisteineoffene Frage“!Vielesindgekommen, haltendasentzündendeFriedenslichtnuninHändenund antworten–freiundinFreiheit…!Ja,esistderWunschder Initiatorenunddasineinem Jahr,wo„derFrieden“sichvielerortsinunerreichbareWeitenentfernthat.“
DerBegriffFriedentrittimmer großundplakativinderAdventsundWeihnachtszeitauf“sagt AndreasBaadenweiterund
EserinnertandieBotschaft vomWeihnachtsfrieden,derbei derGeburtChristiinBethlehem verkündetwurdeundleuchtet amHeiligenAbendbeiMillionenMenscheninallerWelt.

AnderVerteilungdesFriedenslichtsausBethlehembeteiligensichinWormsderBund derDeutschenKatholischenJugend(BDKJ)imDekanat Worms,derBundderPfadfinderinnenundPfadfinder(BdP), StammBundschuh,Pfeddersheim,dieChristlichePfadfinderschaftDeutschlands(CPD), StammNibelungen,Hochheim undderVerbandChristlicher PfadfinderinnenundPfadfinder (VCP),StammNibelungen,Luthergemeinde,undStammGrafenvonEberstein,Horchheim.
„BereitsseiteinigenJahrensehenwir,dassimmermehrSorgeberechtigtevonihremRechtauf KindertagesbetreuungGebrauch machen.DerAusbauvonKindertageseinrichtungeninRheinlandPfalzistdeshalbindenvergangenenJahrenstetigvorangeschritten undgenießtweiterhinhöchstePriorität.TrägerundKommunenhabendafürgroßeKraftanstrengungenunternommen,dennimRahmenderkommunalenSelbstverwaltungisteseinePflichtaufgabe derKommuneneinbedarfsgerechtesAngebotanKindertagesbetreuungsplätzenbereitzustellen.Der Platzausbaumussundwirdinden kommendenJahrenweitergehen, damitderRechtsanspruchaller rheinland-pfälzischenKindernohneEinschränkungenerfülltwerdenkann.DaBildungabereine gesamtgesellschaftlicheAufgabe ist,sehenwiresalsunserePflicht, aberauchalsdiedesBundesan, dieKommunendabeibestmöglich
zuunterstützen“,ergänztdieMinisterin.ImLandeshaushaltfür dasJahr2022sindmehrals900 MillionenEurofürfrühkindliche Bildungvorgesehen.DamitwerdennebenPersonalkostenauch Aus-undNeubautenvonKitasfinanziellunterstützt,umgute räumlicheVoraussetzungenfür diebestefrühkindlicheBildung undBetreuungderrheinland-pfälzischenKinderzuschaffen.
NichtnurderquantitativeAusbauderKindertageseinrichtungen wirdinRheinland-Pfalzforciert, auchdiequalitativeWeiterentwicklungderKindertagesbetreuung stehtimVordergrund.Vormehr alseinemJahristdasneueKitaGesetzvollständiginKraftgetreten.DasbedeutetmehrQualität, mehrGeldundmehrGebührenfreiheit.„MitdemKita-Zukunftsgesetzlegenwireinenklaren Schwerpunktaufdiefrühkindliche Bildungundarbeitenjetztundin denkommendenJahrendaran,die Kindertagesbetreuunginunserem LandgemeinsammitallenBeteiligtenweitervoranzubringen“,so dieMinisterin.„KindertagesbetreuungistfürdiegesamteGesellschaftrelevant:Kinderbrauchen Bildung,ErziehungundBetreuung,aberauchdieKitaalsOrtdes sozialenMiteinanders,andemsie mitihrenFreundinnenundFreundespielenundtobenoderErzieherinnenundErzieheralsBezugspersonentreffen.Elternbrauchen eineguteBetreuungfürihreKinder,damitsieFamilieundBeruf vereinbarenkönnen.Daszeigtzugleich,wiewichtigdietäglicheArbeitderErzieherinnenundErzieherist,diesieindenEinrichtungenleisten,undfürdiewiruns sehrherzlichbedanken“,soHubig abschließend.
4 LOKAL-NACHRICHTEN NIBELUNGENKURIER| Samstag,17.Dezember2022
FRIEDENSLICHTAKTION2022: WormserPfadfindergruppenundBDKJWormsludenzuAndachtvordemWormserDomein „FriedenbeginntmitDir“
Ev.KitaSterntaler erhält453.000Euro MitdererstmaligenÜbergabedesFriedenslichtesimSchneefandamDonnerstagaucheinekleinePremierestatt. Foto:RudolfUhrig EineKitainderPrinz-Carl-AnlageistweiterhininderPlanung.Gleichesgiltu.a.auchfüramFischmarkt,amBIZoderim WormserWesteninderCarl-Villinger-Straße.Foto:FlorianHelfert FortsetzungvonSeite1
RundzehnMillionenEuroneueSchuldenproJahr
STADTBIBLIOTHEK: ComputerspieleimWertvon1.300Euro
„GamesmadeinWorms“




























DieWormserComputerspieleentwicklervonKalypsoMedia habendenkurzenDienstweggenutztunddieStadtbibliothekbeschert.MitimGepäckhattensie einegroßePaletteihrerGames wieetwa„Tropico6“oder„Railway Empire“fürdiegängigstenSpielekonsolenineinemGesamtwert von1.300Euro.Diesekönnenab demkommendenJahrausgelie-










































henwerden.Alternativkönnen Kindervonzwölfbis16Jahrenim „GamingClub“jedenzweiten DonnerstagimMonat,15bis16.30 Uhr,direktinderderStadtbibliothekspielen.DasUnternehmen mitSitzinderWilhelm-Leuschner-StraßeundStandortenu.a.in denUSAmöchtedieKooperation mitderStadtbibliothekkünftig ausbauen.
SITZUNGSTERMIN
Nachwahlenund Bauangelegenheiten
AmDienstag,dem20.Dezember,um19.30Uhr,findet imDorfgemeinschaftshaus Hohen-SülzendieSitzungdes OrtsgemeinderatesHohenSülzenstatt.AufderTagesordnungdesöffentlichenTeiles stehenu.a.dieVerpflichtung desRatsmitgliedesBernd Christen,dieNachwahlordentlicherMitgliederfürden Haupt-undFinanzausschuss, dieNachwahlstellvertretenderMitgliederfürdenBauundDorferneuerungsausschuss,dieNachwahleines ordentlichenMitgliedesfür denLandwirtschafts-und Weinbauausschuss,diePrüfungderJahresrechnung2021 sowiedieSatzungüberdieErhebungvonVerwaltungsgebührenundAuslagenersatzin Selbstverwaltungsangelegenheiten.

LUTHERKIRCHE: WeihnachtlicheKonzerteam26.Dezember
WerkealterMeistererklingen
AmzweitenWeihnachtstag, dem26.Dezember,ladendas evangelischeStadtkantoratund dieEvangelischeLuthergemeindeWormszueinemdreimalaufgeführtenweihnachtlichenKonzertindieLutherkirche,Karlsplatz5,67549Worms,ein.SowohlzurGottesdienstzeitum10 UhralsauchinzweiWiederholungskonzertenamNachmittag um15sowieum18UhrerklingenweihnachtlicheWerkealter MeisterwieMichaelPraetorius, WolfgangCarlBriegel,Franz
XaverBrixi(u.a.Orgelkonzert Nr.1),JohannTheileundGeorg PhilippTelemann(Konzertfür Oboed’amore).
Vokalquartettdes Stadtkantorats
DieAusführendensinddas VokalquartettdesStadtkantorats mitUlrikeNaumann-Rothe(Sopran),KatharinaSchmitt(Alt), AndreasStavenhagen(Tenor) undChristianSchmitt(Bass)sowieweitereMusikerderDalber-
gerHof-Capelle,dieaufhistorischemInstrumentariummusizieren:AlexandruNicolescu(Barockoboe),OlgaNodelundLiubaPetrova(Barockvioline)sowie YuichiYazaki(Barockviola).Die DauerderVeranstaltungbeträgt etwaeineStunde.DerEintrittist frei,eswirdumeineKollektegebeten.
DerKirchenraumerlaubtin allendreiAufführungengebührendeAbständebeiderWahldes Sitzplatzes.DerRaumwirdauf mindestens15°Cbeheizt.
SGDSüdgeschlossen
DieStruktur-undGenehmigungsdirektionSüd(SGD Süd)istvom27.bis30.Dezembergeschlossen.Die FunktionsfähigkeitinbestimmtenBereichenistdurch Bereitschaftsdienstesichergestellt.
WEIHNACHTSMARKT: Versteigerungam20.Dezember um18Uhrbeim„KlooseHelmut“


DienächsteSitzungdesOrtsgemeinderatesBechtheimfindetamMontag,dem19.Dezember,um18.30Uhr,inder Sport-undKulturhalle,HeßlocherStraße17,67595Bechtheim,statt.AufderTagesordnungdesöffentlichenTeilsstehenu.a.dieProtokollevon


Gremiensitzungen,derJahresabschluss2020,derJahresabschluss2021,dasWohnbaugebiet„AufderHeck“,derNeubaueinerKindertagesstättesowiederBaueinerFreizeit-und Sportanlage.DerInhaltderBekanntmachungistauchauf www.vg-wonnegau.de einsehbar.











Kinderbildersollen Ausflugermöglichen
ImRahmeneinesKunstprojektsmitgeflüchtetenKindern ausderUkrainesindzahlreiche Bilderentstanden,dieamDienstag,dem20.Dezember,aufdem WormserWeihnachtsmarkterworbenwerdenkönnen.Die Werke,diezuvorinderWormser Kinder-undJugendbibliothek ausgestelltwaren,werdenanei-
nerderWechselbudenvonder EvangelischenJugendWormsWonnegauverkauft.Höhepunkt derVeranstaltungistdieVersteigerung.Losgehtesum18Uhr amGlühweinstandvom„Kloose Helmut“amRömischenKaiser. DerErlöswirdfüreinenbesonderenAusflugmitdenKindern verwendet.
AnderIGSOsthofenzumAbitur



FüralleOberstufen-InteressiertenbietetdieIGSOsthofen am28.Januar2023einen „SchnuppertagMSS"mitInformationsvorträgen,ProbeunterrichtundGelegenheitzum

diesem Weihnachtsgrußmöchten wir unseren Dank für die guteund angenehme Zusammenarbeit verbinden. Wirwünschen Ihnen eine frohe und glückliche Weihnachtszeit sowie ein gesundes und erfolgreiches NeuesJahr.


SITZUNGSTERMIN
MitHaushalts-und Stellenplan
IndiesemJahrunterstützenwirdasMotto: „ZukunftderVGEich“mitBaumspenden. Vom23.12.2022bis8.1.2023istunserBetriebgeschlossen, nurdringendeReparaturenwerdenindieserZeitausgeführt.
AmMontag,dem19.Dezember,um19Uhr,findetin deraltenGüterhalleMonsheimdieSitzungdesOrtsgemeinderatsMonsheimfür dieWahlperiode2019–2024 statt.AufderTagesordnung desöffentlichenTeilesstehenu.a.Einwohnerfragen, dieHaushaltssatzung2023 mitHaushaltsplanundStellenplanderOrtsgemeinde Monsheim,dieHaushaltssatzung2023mitHaushaltsplanundStellenplander OrtsgemeindeMonsheim, dieSatzungüberdieErhebungvonVerwaltungsgebührenundAuslagenersatz inSelbstverwaltungsangelegenheiten,Beratungenund BeschlussfassungenzurKita Monsheim,verschiedene Bauangelegenheitensowie MitteilungenundAnfragen.

persönlichenAustausch.BesonderheitenbezüglichSchulstandort,Arbeitsweisen,UnterrichtsangeboteundeineVorstellungderFächerfindetman auchunter www.igs-osthofen.eu.




Samstag,17.Dezember2022| NIBELUNGENKURIER NIBELUNGENKURIER 5 Guntersblum •WormserStraße55•Tel.:062414004-94/-51 Westhofen •Raiffeisenstraße6•Tel.:062414004-94/-51 E-Mail:energie-festbrennstoffe@rwz.de•www.rwz.de IhreRaiffeisen-Märkte Premium Holzpellets DIN/EN PLUS ä Abb. 15 kg 65 Sack e Palette 9,49 beiPalettenabnahme je15kg-Pack 1kg=0,63 PreisbeiEinzelabnahme 9,99 (1kg=0,67) 259,Reine Buche, getrocknet, 33cm je1rm KAMINHOLZ-VERKAUF! HartholzMix getrocknet,33cm, je 1rm 239,In den Weißen Aspen 2 68642 Bürstadt-Bobstadt Telefon: 06245-6245 Mail: info@holz-bluem.de Wilhelm Blüm –Holzhandlung GmbH www.holz-bluem.de Besuchen Sie unsere Ausstellung! Böden Türen Terrassen Decken / Wand Bauholz Verehrte Kunden, noch keine Geschenkidee? Wie wäre es mit einem Präsentkorb oder einem Einkaufsgutschein? Ab 22.12. möchten wir Ihnen zu den bevorstehenden Festtagen anbieten: Friedrich-Ebert-Straße 18 · 67574 Osthofen · Telefon (0 62 42) 79 15 · Fax (0 62 42) 6 09 28 Öff nungszeiten: Mo.–Fr.: 6.30 bis 18 Uhr Sa.: 6.30 bis 13 Uhr Festtagsröllchen gefüllt mit Croûtons, Dörrfleisch und Champignons (ca. 400 g) 100 g € 1,49 Pfiffiges Filet gefüllt mit Pfifferlingen, herzhaft abgeschmeckt (ca. 700 g) 100 g € 1,79 Maronenbraten vom Kamm oder Rücken, auf Wunsch im Bratschlauch 100 g € 1,39 Prager Schinken vorgegart, nur noch ca. 40 Minuten backen 100 g € 1,39 Weihnachtspfännchen Schweinemedaillons in Pilzsoße, ofenfertig in der Aluschale 100 g € 1,89 (bitte Personenzahl angeben) Steinpilz-Braten ofenfertig mit Soße, für ca. 2 Personen / Stück 100 g € 1,49 Vom Landschwein Putenbrust mit Waldpilz- oder Bratapfelfüllung, ofenfertig in der Bratfolie 100 g € 1,59 Frische Maishähnchen Stück für 2 Personen, bitte vorbestellen 100 g € 0,89 Vom Geflügel Glühweinschmorbraten vom Jungrind, in Rotwein gebeizt, weihnachtlich gewürzt 100 g € 1,49 Rumpsteaks oder Rostbraten vom Jungrind, auf Wunsch gewürzt 100 g € 2,49 Sauerbraten küchenfertig 100 g € 1,49 Kalbsschnitzel oder Kalbsbraten, Kalbsbrust, Kalbsbratwurst 100 g € 1,49 Vom Rind Pfälzer Wildschweingulasch pfannenfertig, mariniert 100 g nur € 1,49 Zu Silvester: Wir bitten um Vorbestellung! Große Würstchenauswahl, Fonduefl eisch, Sauerkraut vom Fass, zarte Rippchen und vieles mehr Separate Abholstation ausschließlich für Vorbesteller! Selbstverständlich bieten wir auch alle anderen bekannten Braten von Rind, Schwein, Kalb und Pute an. Frohe Weihnachten wünschen Ihnen Ihre Familie Kratz und alle Mitarbeiter! 22_49s Achtung: Am 24.12.2022 von 8 bis 13 Uhr geöffnet. Mit
Frohe WEIHNACHTEN
06249 4245 www.hg-oswald.de Neustraße22+24+28•67578Gimbsheim/Rhein
Ihr Fachbetrieb
„AufderHeck“undKita-Neubau
67551 Worms-Pfeddersheim • Pfiffligheimer Straße 7 • Tel. 06247 9047926 67577 Alsheim • Gimbsheimer Straße 73 • Tel. 06249 674652 Herausgeber: Wolf Alban Röß e.K., Pfiffligheimer Str. 7, 67551 Worms-Pfeddersheim Röß Heiligabend 24.12. von 7 bis 13.30 Uhr Silvester 31.12. von 8 bis 15 Uhr Wir wünschen allen ein frohes Weihnachtsfest und ein gesundes und glückliches 2022! Wolf Röß und Team Straße • 06249 Wirwünschenalleneinfrohes Weihnachtsfestundeingesundesund glückliches2023!WolfRößundTeam HolenSiesich IhreGeschenkideen vomReisebüro! z.B.ZumRheinlandpfalztagnachBadEms€40,–MehrIdeenimneuenBus-Reisekatalog2023 Jetztanfordernunter06245-7130u.0621-102051
FürdieSanierungderBergkirche
AmSamstag,dem17.Dezember, um17Uhr,gibtderChor„JazzAffair“einweihnachtlichesBenefizkonzertinderBergkircheim StadtteilHochheim.Mitdiesem KonzertinderAdventszeitkehrt dermodernegemischteChorder „Liedertafel“ausPfiffligheimzurückzueinerbeliebtenTradition. WiederVorsitzendeFrankSchneiderankündigt,wird„JazzAffair“ „dasPublikumaufeinemusikalischeReisemitweihnachtlichen KlängenausallerWeltbishinzu

modernenA-cappella-Arrangementsmitnehmen“.DamitmöchtederChordemPublikumeine stimmungsvolleAuszeitbescheren.DaessichumeineBenefizveranstaltunghandelt,wirdauf denKartenverkaufverzichtet.


StattdessenbittetderChorum eineSpende,welchefürdieDachsanierungderBergkirchebestimmtist.BeidernotwendiggewordenenSanierungdesDachgebälksderrund1.000Jahrealten KirchesollendieBalkenausge-
tauschtwerden,ohnedasDachabzudecken.EinenTeilderdamit verbundenenKostenmussdieGemeindeauseigenenMittelnleistenundistfolglichauchaufSpendengelderangewiesen.Sohatsich dieGemeindeüberdasJahreine ReihevonAktioneneinfallenlassen,mitdenenSpendengeneriert werdenkonnten.MitdemBenefizkonzertmöchte„JazzAffair“der Gemeindedankenundaufseine WeiseeinenBeitragzumErhalt derKircheleisten.
WORMS: SPD-OrtsvereinSüdübergibtSpiel-undLernstubeWeihnachtsüberraschung
Schokonikoläusefürdie Vorstadtkrokodile
60TütenmitSchokonikoläusenübergabenBennoFalzund TobiasKlosterimNamender SPDWorms-SüdanGerold Hirschler,demLeiterderSpielundLernstube„DieVorstadtkrokodile“.
DievonderDiakonieRheinhessengetrageneEinrichtung imWormserSüdenmachtsich fürdieKinderundJugendlichenvorOrtstarkundsorgtbei demNachwuchsdurchkontinuierlicheundlangfristigeFörderungfüreinewichtigeStruktur.SobietendieBetreuerinnenundBetreuernichtnureinemittäglicheVerpflegung undeineGanztagsbetreuung fürdie2-bis6-Jährigen,sondernunteranderemauch Hausaufgabenbetreuung, Sprachförderungsprogramme, Sport-undKreativangebote,Ferienprogramme.Gemeinsam lernendieKinderwichtigesozialeKompetenzenundden spannendeninterkulturellen Austauschvonkleinaufkennen.FürdieSPDWorms-Süd
PünktlichzurWeihnachtsfeierbrachtendieSozialdemokratenausdemWormser SüdendieWeihnachtsüberraschungvorbei.

istdieUnterstützungderEinrichtungselbstverständlich: „Wirsindbegeistertvondem Engagement,dasdieMitarbeitendenderEinrichtunganden Taglegen“,erklärtTobiasKloster,VorsitzenderdesWormser SPD-Ortsvereins.Bereitsim vergangenenJahrunterstütztendieSozialdemokratendie


EinrichtungderDiakoniemit NikoläusenzurWeihnachtsfeier.„Esfreutuns,auchindiesemJahreineKleinigkeitzur Weihnachtsfeierbeisteuernzu können–dieÜbergabederNikoläuseandieVorstadtkrokodilekönntesichtatsächlichzueinerkleinenTraditionentwickeln“,fügtKlosterhinzu.
NABU: Vom6.bis8.Januarfindetdie13.„StundederWintervögel“statt


Eicheln,Eckern,Zapfensatt–Bleiben WaldvögeldemFutterhausfern?
InNadelwäldern,aberauchinnadelholzreichenParkanlagenundGärtenfühlt sichdieHaubenmeisewohl.KannsiezurNABU-Aktion„StundederWintervögel“ gesichtetwerden?Foto:F.Derer/NABU
VögelzählenabdemDreikönigstag:Vom6.bis8.Januar2023 findetzum13.Maldiebundesweite„StundederWintervögel“ statt:DerNABUundseinbayerischerPartnerLBV(Landesbund fürVogel-undNaturschutz)rufendazuauf,eineStundelang dieVögelamFutterhäuschen,im Garten,aufdemBalkonoderim Parkzuzählenundzumelden.
„ImvergangenenJanuarhabenfast9.500Menschenin Rheinland-Pfalzmitgezählt, deutschlandweitwarenessogar über176.000.Wirfreuenuns überdieanhaltendhoheBeteiligunganunserenAktionen.Auch dieAppNABUVogelwelt,über diemanauchanderZählungteilnehmenkann,hatinzwischen dieZwei-Millionen-Markebei denDownloadsgeknackt.Dasalleszeigt,wiegroßdasInteresse anderheimischenNaturist“, sagtCosimaLindemann,LandesvorsitzendedesNABURheinland-Pfalz.„WerVögelnetwas Gutestunmöchte,sollteausseinemGartenoderBalkoneinMini-Naturschutzgebietmachen unddiesemöglichstwildundmit heimischenGehölzen,Stauden undKräuternnaturnahgestalten.“
AuchdasFütternmitSaaten undungenetztenMeisenknödeln nehmenWintervögelgernean. WobeiesindiesemWinterwenigerBetriebamFutterhausgeben
könnte.Denn2022isteinMastjahr.Dasbedeutet,dassEiche, Buche,FichteundCo.außerordentlichvieleFrüchtegebildet haben.Lindemann:„Kleiber,Eichelhäher,KernbeißerundBuntspecht,Buchfinkundauchder BergfinkalsWintergastsowieder ErlenzeisiglebenvondenBaumfrüchten.FürsieistderTischin diesemWinterüberreichgedeckt.“
IndenletztenJahrensind Mastjahreungewöhnlichhäufig aufgetreten.DasscheinteineFolgedesKlimawandelszusein. Warme,trockeneSommerbegünstigeneinenhohenBlütenansatz.AuchdieSpätfröste,die durchdenKlimawandelvermehrtauftreten,fördernein MastjahrimFolgejahr.Dadurch kommtesimWaldzuStressblühereignissenundMassenfruchten.„Interessantwirdsein,wie sichdietypischenWaldvogelartendiesenWinterverhaltenwerden“,soLindemann.„MöglicherweisebleibensieeherimWald undkommennichtsooftindie Siedlungen.Daswürdebedeuten,dasswirwenigerFutterhausgästesehenundzählen.“Allerdingshängedasauchimmer vomWetteramZählwochenende ab,soLindemannweiter.Die „StundederWintervögel“ist DeutschlandsgrößtewissenschaftlicheMitmachaktionund findetbereitszum13.Malstatt.
Wermitmachenwill,beobachtet eineStundelangdieVögelam Futterhäuschen,imGarten,auf demBalkonoderimParkund meldetdieErgebnissedemNABU.VoneinemruhigenBeobachtungsplatzauswirdvonjederArt diehöchsteAnzahlVögelnotiert, dieimLaufeeinerStundegleichzeitigzusehenist.DieBeobachtungenkönnenperAppunter www.NABU.de/vogelwelt,unter www.stundederwintervoegel.de oder unter www.NABU.de/onlinemeldung biszum16.Januargemeldetwerden.ZudemistfürtelefonischeMeldungenam7.und8. Januarjeweilsvon10bis18Uhr diekostenloseRufnummer0800/ 1157-115geschaltet.„Werden Postwegbevorzugt,kannsichdie beliebtenFaltblättermitMeldebogenbesorgen“,soMatthias BöslvomNABUWorms-Wonnegau.SieliegenabsofortinfolgendenGeschäftenbereit:InWorms beimSamengeschäftSchwemler, inHorchheiminderBäckerei Seiler,inWeinsheimbeiZooHufnagel,inGundheiminder BäckereiWeberundbeiEllas DubbesinOsthofen.InderNABU-InfoboxaufdemHauptfriedhofundindenBeobachtungshüttenEichundRheindürkheim sindebenfallsFaltblättervorhanden.
Schulstundeder Wintervögel
DieNAJUlädtmitder„SchulstundederWintervögel“vom9. bis13.Januar2023alleKinder ein,dieheimischenWintervögel spielerischkennenzulernen,zu beobachtenundeineStundelang aufdemSchulhof,imParkoder imGartenzuzählen.WelcheVögelverbringendenWinterin Deutschlandundwiekönnen sichschonKinderfürihren Schutzeinsetzen?DasBegleitheftzurSchulstundeliefertzahlreicheAnregungen,einPoster stelltdiehäufigstenWintervogelartenvorundeinekindgerechte ZählkarteerleichtertdieTeilnahmeanderVogelzählung.Alle Infosunter www.NAJU.de/sdw
6 NIBELUNGENKURIER NIBELUNGENKURIER| Samstag,17.Dezember2022 SiemöchtenindieserRubrikinserieren? 4WochenWerbungfürnur119,–Euro zzgl.MwSt.odermitOnline-Bannerfür169,–Eurozzgl.MwSt. Tel.(06241)9578-0,Prinz-Carl-Anlage20,67547Worms anzeigen@nibelungen-kurier.de,www.nibelungen-kurier.de DIE KLEINE GESCHÄFTLICHEEMPFEHLUNG SCHROTTHANDEL Entsorgungen aller Art Haushaltsauflösungen Autoverwertung MICHÉL BAUMGÄRTNER www.schrott-metallhandel-worms.de Kostenlose Schrott Abholung 0176 - 87 99 19 22 22_45s Sofortdruck Dinger & Müller Binger Str. 67 67549 Worms Tel. 06241-78733 Offset-Digital-DrucksachenTextil-Druck aller Art Geschenkartikel Reifen & Autoservice Mast Ludwigstr. 66 • 67547 Worms Tel. (0 62 41) 2 50 32 www.reifenmast.de Riesenauswahl Alufelgen · Kompletträder · Reifen cf.27sa21 Harald HM Müller Verputzarbeiten Vollwärmeschutz Fassadenanstrich Innenausbau Harald Müller Höhlchenstr. 52 67551 Worms Mobil: (01 78) 6 87 56 76 E-Mail: hm-worms@t-online.de cf.14sa16 GbR 24-STD.-NOTDIENST 0 62 41 / 3 09 40 59 lr49sa16 R. SCHÄFER Stuckateurfachbetrieb • Altbausanierung • Trockenbau • Vollwärmeschutz • Malerarbeiten • Innen- u. Außenputz • Dekoputz WO-PFEDDERSHEIM (0 62 47) 9 00 05 39 rh13sa20 Hebenstreit Elektroservice Elektro-Installateurmeister Tel. (01 62) 4 77 45 39 info@hebenstreit-elektroservice.de www.hebenstreit-elektroservice.de Bl25sa16 Bestens beraten & betreut IMMOBILIENSERVICE DENSCHLAG Tel. (0 62 41) 69 61 Sachverständige für Immobilienbewertung D2 Mitglied im Immobilienverband Deutschland Seit 1974 Ihr Makler für Worms und ganz Rheinhessen 22_16s Mainzer Straße 89, 67547 Worms Tel. (0 62 41) 3 79 79, Mobil (01 73) 7 22 25 35 AUSFÜHRUNG SÄMTLICHER MALERARBEITEN lr28sa16 06241 / 31 92 www.kraftbau.eu BAUEN UND SANIEREN – SEIT 1875 Tel. (0 62 41) 31 92 www.kra bau.eu cf.28sa21 In den Weißen Aspen 2 68642 Bürstadt-Bobstadt Telefon: 06245-6245 www.holz-bluem.de Wilhelm Blüm – Holzhandlung GmbH Böden - Türen - Terrassen Haushaltsauflösungen Mike Köppel Worms Tel. (01 76) 70 74 97 52 Mike’s 22_48s Renovierung,Malen& Tapezieren,Fliesen-& Laminat-Verlegung 22_48s BüchersindLebensmittel BuchhandlungLanz Osthofen,Sickingenstr.1 Tel.(06242)3433 www.buchhandlung-lanz.com IhrLebensmittelhändler Tel.(06244)679 OsthofenerLandstraße8•67593Westhofen zwischen Osthofen& Westhofen 22_48s Weihnachtlichschön, immereineguteIdee!
BENEFIZKONZERT: „JazzAffair"singtamheutigen17.Dezemberum17UhrinHochheim
DIE KLEINE GESCHÄFTLICHE EMPFEHLUNG
Hoffnungsvollbeganndas Jahr2022,dieAussichtaufrückläufigeCoronafallzahlenunddamiteinhergehendweitereLockerungenderpandemiebedingten Einschränkungenließendie Kultur-undTourismusakteure nichtnurinWormsspürbaraufatmen.Spätestensalsklarwurde,dassIn-undOutdoorveranstaltungenindenbevorstehendenMonatentatsächlichstattfindenkönnen,wardieStimmung derBeteiligtenoptimistisch.AllerdingsdämpftederUkrainekriegunddiedamiteinhergehendeweltweiteEnergie-und WirtschaftskrisesamtgaloppierenderInflationdieErwartungenderTouristiker.Einmal mehrwurdeklar,wiesehrsich dieFolgenderGlobalisierung aufAngebotundNachfragein

diesemsonstvonWachstumverwöhntenWirtschaftszweigauch inWormsauswirken.


FinanzielleUnterstützung

PositiveSignalefürdenTourismussendetedasLandRheinland-PfalzMittedesJahres:Wie bereitsindenJahren2020und 2021legtedasWirtschaftsministeriumauchin2022einFörderprogrammfürtouristischeMarketingmaßnahmenzurAbmilderungderAuswirkungender Coronapandemieauf.
Mit„ReStartIII“beschertedas LandderStadtWormsneben weiterengroßenStädtenFördermittelinHöhevon80.000Euro beieinerhundertprozentigen Förderquote.„Einegroßartige finanzielleUnterstützung,die
wirfürMarketingmaßnahmen bisJuni2023verwenden.Neben AusgabenfürstadteigeneProjektesinddieMittelfüreinegemeinsameMarketingkampagne derStädteMainzundWormssowiederRegionRheinhessenverplant“,erläutertBerndLeitner, ChefderTouristInformation. „ImRahmender'ReStartIII' FörderunghabenwirunsindiesemJahrfüreinenMixausContentproduktionfürPrint-und OnlinemediensowieeinMediabudgetfürunsereSocialMedia KanäleaufFacebookundInstagramentschieden“,erläutert SandraKirchner-Spies,stellvertretendeLeiterinundverantwortlichfürdiedigitalenAngebotederTouristInfo.Nebender ProduktionvonKurzvideos,so


genanntenReels,wurdenFotoshootingszuVeranstaltungen wieBackfischfestundJazz&Joy, aberauchzuEvergreen-Themen wieStadtführungenundden KulturprofilenderStadtbeauftragt.EbendieseKulturprofile standenauchbeiderErstellung neuer,ansprechenderTexteeinerversierten,externenAutorin fürdietouristischeWebseite worms-erleben.desowiedieNeuauflagederThemenflyerimMittelpunkt.„AlleMaßnahmen zahlenaufdieTourismusstrategiedesLandessowiederenWirtschaftsstandortmarke'Rheinland-PfalzGold'ein“,soKirchner-Spiesweiter.

DenvollständigenBerichtlesen Sieunterwww.nibelungen-kurier.de
NEUESZUHAUSEGESUCHT

FürAlli,einenjungenLabrador, geb.imJuni2021,geimpft,gechipt,kastriertsuchtdieHundevermittlungsstationFellosophie desVereinsProAnimaleeinliebevollesZuhause.Alliwurdevon TierschützernausdemHundeschlachthausinShanghaigerettet undinderFellosophieaufgenommen.ErhateinvölligunkompliziertesWesenunderfreutsichan seinerFreiheit,ganzbesonders, obseinerzuvorerlebtenPein.Mit seinemsanftmütigen,freundlichenCharakterundsozialenVerhalten,istAllisehrgutalsFamili-


enhund(auchalsZweithund)geeignet.FürseinneuesZuhause, dasihmeinenGartenbietensollte,sowieausgedehnteSpaziergängebeiseinemausgeprägten Bewegungsdrang,wirderder treuesteBegleitersein.

ProAnimalefürTiereinNote.V.–FellosophieWorms, Telefon0172/9740936oder0151/12409552



Samstag,17.Dezember2022| NIBELUNGENKURIER NIBELUNGENKURIER 7 GOLDANKAUF Vertrauen Sie Ihrem 1 a Juwelier – Der Endpreis zählt! für ALTGOLD BRUCHGOLD GOLDMÜNZEN SILBER ZINN ZAHNGOLD GOLDUHREN GOLDBARREN SILBERBESTECKAUFLAGE für Gold wird zu Geld –PROFITIEREN SIE VOM GESTIEGENEN GOLDPREIS! UHREN & SCHMUCK – GOLDANKAUF + TRAURINGSTUDIO Hafergasse 9 • 67547 Worms • Telefon (0 62 41) 82292 Öffnungszeiten: Montag bis Freitag von 10 bis 18.30 Uhr, Samstags von 10 bis 16 Uhr Sofort BARGELD Sofort BARGELD Wiedereröffnung GOLDANKAUF + TRAURINGSTUDIO cf.06sa19 JUWELIER SAFAK · Hafergasse 9 · 67547 Worms WiedereröffnungUHREN und Schmuck Batteriewechsel WIR KAUFEN IHRE MARKENUHREN WIE ROLEX, BREITLING UND OMEGA WORMS: TouristikerziehenBilanz/FörderprogrammfürtouristischeMarketingmaßnahmen/AusblickinsneueJahr Erste„normale“SaisonnachderPandemie
NebenderProduktionvonKurzvideoswurdenFotoshootingszuVeranstaltungen wieBackfischfestund„Jazz&Joy“beauftragt.Fotos:KatiNowicki Mehrals700WormsernahmenandemAktionstag„WormsfürWormser“teil. 22_50s Foto:Rike/pixelio.de Chemiestraße5•68623Lampertheim Tel.06206/4146•Fax:06206/59871 UnserBetriebistvonDo.,22.12.22biseinschl.Sa.,07.01.2023geschlossen. AbMontag,09.01.2023sindwirwiederfürSieda.
AutohausChristmannmachtRhein-NeckarLöwenmobil

mitunserenFahrzeugenund unseremServicezuunterstützen“,sagtChristopherNeidig, MarkenverantwortlicherderAutohausChristmannGmbH.„Im RahmenunsererPartnerschaft erhaltenwireinKontingentan FreikartenfürSpielederLöwen, mitdemwirunteranderemJugendvereinederRegionunterstützen.“
AuchFansderRhein-Neckar LöwenprofitierenvonderZusammenarbeitmitdemAutohaus Christmann:DerKiaHändlerbietetnämlichanlässlichderKooperationattraktiveLeasingangebote fürdievielfältigeModellpalette deskoreanischenMobilitätsdienstleistersan.



zunächstalsReparaturwerkstatt fürAutomobilegegründetwurde,istseitJahrzehnteneinverlässlicherMobilitätspartnersowieeinwichtigerArbeitgeberder gesamtenRhein-Neckar-Region/ Weinstraße.AnvierStandorten mitrund80Mitarbeiternistdas Autohausaktiv.Seit2013istes Kia-VertragspartnerinLudwigs-
hafenundWorms.InGrünstadt wird2023einweitererStandort fürdieMarkeKiaeröffnet.InsgesamtverfügtdasUnternehmen über30.000QuadratmeterAusstellungsfläche,aufderstetseine Auswahlvon400Neuwagen,TageszulassungenundGebrauchtfahrzeugenzurBesichtigungbereitsteht.
DieRhein-NeckarLöwensetzenaufKia:AbsofortistdasAutohausChristmannneuerAutomobilpartnerdesHandball-BundesligistenundzweifachendeutschenMeisters.SeitBeginnder aktuellenSpielzeithatderKia HändlerbereitsüberzehnSpieler undOffiziellerundumCheftrai-
nerSebastianHinzemitunterschiedlichstenModellendeskoreanischenMobilitätsanbieters ausgestattet.


DieFlotte,bestehendausModellenwiedemKiaSportage, demKiaSorentosowiedemvollelektrischenEV6wirdkontinuierlicherweitertundmachtdie

Löwenmobil.AlsMobilitätspartnersindKiaunddasAutohaus Christmannunteranderembei denHeimspielendesBundesligistenpräsent.
„WirfreuenunsüberdieMöglichkeiteinesderbestendeutschenHandballteams,dasnoch dazuausunsererRegionkommt,
WeitereInformationenüberdie „Löwen-Angebote“unter https:// autohaus-christmann.com/loewen/ ÜberdasAutohaus



Christmann









DasAutohausChristmannfeierteindiesemJahrsein100-jährigesFirmenjubiläum.DasUnternehmen,das1922inKirchheim

8 AUSWIRTSSCHAFTUNDGESCHÄFTSWELT NIBELUNGENKURIER| Samstag,17.Dezember2022 Wunschzettel Anzeigensonderveröffentlichung von 5Schlemmerblöcken gewinnen! einen MitetwasGlück FindenSieinunseremKreuzworträtsel dasrichtigeLösungswort. SchreibenSiedasLösungswortaufeinePostkarte undsendenSiediesebiszum27.Dezember2022 mitAngabeIhrerTelefonnummer unterdemStichwort„Wunschzettel“anden NibelungenKurierVerlagGmbH, Prinz-Carl-Anlage20,67547Worms. DieGewinnerwerdentelefonischbenachrichtigt. EsgiltdasDatumdesPoststempels. DerRechtswegistausgeschlossen. WEIHNACHTSBUFFET Am25.Dezembervon12bis14Uhrinder GaststätteHorchheim(Horchheimer Bahnhofstr.47).UmReservierungwirdgebeten: (0176)21414671 Wir wünschenallenGästenfroheWeihnachten undeinengutenStartinsneueJahr! 22_49s 22_50s Gutenbergstraße23–25|67549Worms Mo–Fr.,11–18Uhr,Sa.,10–16Uhr NurnochkurzeZeitgeöffnet! Leder-undDaunenmode ABSOFORTBISZU 70% REDUZIERT TOTAL RÄUMUNG WIRSCHLIESSEN! LedermodefürSie&Ihn radikalreduziert! Geschenkideen? FindenSiebeiuns! Foto:SilviVatter,edita-verlag.de Weckerlingplatz1 67547Worms (06241)–3025523 Hauptstraße12 67575Eich www.eicherkaffee.de InunsererRöstereifindenSieerleseneKaffeespezialitäten, bekömmlichundaromatisch,ganzvonNaturaus.Wirverwendenbiologisch angebautenRohkaffeeundachtenauffairenHandel. Öffnungszeiten: Worms: Di.-Fr.,10-18UhrSa.,9-16Uhr Eich: Do.undFr.,14-18Uhr+Sa.,9-13Uhr Onlinebestellen:www.eicherkaffee.de 22_50s Geschenkidee: Wunschkaffee inderGeschenkedose! Wormser Fischgeschäft Gewerbeschulstraße17 67549Worms Tel.(06241)3049930 Di.–Fr.,8–18Uhr&Sa.,8–13Uhr seit16Jahren www.wormser-fischgeschaeft.de Kabeljau-&Lachsfilet Zander-&Rotbarschfilet Schollen-&Saiblingfilet Fischplattenservice JETZT SCHON AN WEIHNACHTEN DENKEN o ixab a com WirsindfürSieda: vom19.–23.12.von8–18Uhr vom27.–30.12.von8–18Uhr am24.&31.12.von8–12Uhr 22_48s Anze gensonderverö en lichung
KiaHändleristneuerAutomobilpartnerdesHandball-Bundesligisten
AUTOHAUSCHRISTMANN:
Vonlinks:AnneCorell(AutohausChristmannGmbH),LukasNilsson(RheinNeckarLöwen),ChristopherNeidig(AutohausChristmannGmbH),ManuelWeber (KiaDeutschlandGmbH),DraganJerkovic(Rhein-NeckarLöwen),OliverRoggisch (Rhein-NeckarLöwen),MichaelJacobsen(Rhein-NeckarLöwen) Vonlinks:AnneCorell(AutohausChristmannGmbH),ManuelWeber(KiaDeutschlandGmbH),LukasNilsson(Rhein-Neckar Löwen),ChristopherNeidig(AutohausChristmannGmbH),OliverRoggisch(Rhein-NeckarLöwen),DraganJerkovic(RheinNeckarLöwen),MichaelJacobsen(Rhein-NeckarLöwen)
Flächendeckend dienstbereit





DerNacht-undNotdienstan WochenendenundFeiertagen isteinDienstderApothekenfür dasGemeinwohl.Auchrund umWeihnachtenunddenJahreswechselwerdenwiederApothekenflächendeckendtäglich inRheinland-PfalzfürNotfälle zurVerfügungstehen.BesondersFamilienprofitierenvom flächendeckendenNacht-und NotdienstderApotheken.
Leichterreichbar


„MehralseinDrittelaller ApothekenkundenholtimNotdienstMedikamentefürKinder“,soPharmazieratPeter Stahl,PräsidentderLandesapothekerkammerRheinlandPfalz.„Deshalbisteswichtig, dassauchinländlichenRegionenvonRheinland-Pfalzund beiwidrigenWitterungsverhältnissendienächstedienstbereite Apothekeleichterreichbarist“. FürsichselbstnutzendenNotdienstetwa40ProzentderApothekenkunden,fürdenPartner undandereFamilienangehörige 24Prozent.




ÜberdienächstedienstbereiteApothekekönnensichApothekenkundeninRheinlandPfalzaufverschiedenenWegen informieren:AmsicherstenunterderRufnummer01805/ 258825plusPostleitzahldes

Standortes(Festnetz:0,14Euro/ Min.,Mobilfunknetzmax.0,42 Euro/Min.).Dortwerdendie nächstendreidienstbereiten ApothekenmitKontaktdaten angesagt.











FürbundesweiteAnsagenstehenfolgendeWegezurVerfügung:KostenlosausdemFestnetzunter0800/0022833,eine SMSmit„apo“an22833(69ct/ SMS).DieserHandy-Service funktioniertdurchdieAngabe vonPostleitzahlund/oderOrt oderperOrtungsowieimmobilenWebunter22833.mobi(bei InternetflatkeineExtrakosten).





















ImInternetkanndienächste dienstbereiteApothekeüber www.lak-rlp.derecherchiertwerden.InLokalzeitungenoder Apothekenschaufensternsind dieNotdienstpläneebenfallszu finden.



„Auch,wennmitdiesemAngebotdieflächendeckendeVersorgungandenFeiertagengesichertist,solltebeidenWeihnachtsvorbereitungenauchan dieHausapothekegedachtund sierechtzeitigmitdenwichtigstenMedikamentenausgestattet werden",empfiehltKammerpräsidentStahlundwünscht allseitsfroheFesttageundeinen gutenStartindasneueJahr.
MehrInformationenunter: wwwa.lak-rlp.deoderwww.abda .de























ImGlanzvontausendLichtern








EndlichkannindiesemJahr dastraditionelleTurmblasen derWormserBarockbläserim WechselspielvomTurmder MagnuskircheundvomDomturmwiederstattfinden.
DamitverbundenistseiteinigenJahrenauchdieEinladung, denDomindiesenvorweihnachtlichenTagenganzanders zuerleben,wennerimAnschlussandasTurmblasenam Abenddes4.Adventssonntags wiederimGlanzvontausend

Lichternerstrahlt.DieDomgemeindelädtvon19.45bis20.30 Uhrein,denDomnurim ScheinvielerHundertKerzen zuerleben.
AndiesemAbendwirddann auchdieKrippeimWestchor desDomeserstmalszugänglich sein.
DomküsterMarkusLöhrund seinTeamhabensieindenvergangenenWocheninliebevoller Arbeitwiederneuarrangiert. „Allesistschonbereit,dieHir-
ten,dieSchafe,dieTiere;nur dieHeiligeFamiliefehltnoch, denndiekommtbekanntlich erstinderHeiligenNachtan“, erklärtderKüster.Undauchdie HeiligenDreiKönigekommen traditionellerstam6.Januardazu.
DomkantorDanZerfaßlädt imAnschlussandasTurmblasenmitadventlicherOrgelmusikzumInnehaltenein.„Esist eineEinladung,indiesenletztenTagenvorWeihnachtenein-
facheinmalzurRuhezukommenundsichinnerlicheinzustimmenaufdieGeburtdesErlösers“,soderPropst.InderbesonderenAtmosphäredesDomesimLichterglanzwürdeeinemdasHerzeinfachweitwerden.VorhergestaltetdieDomgemeindeum17.30Uhrbereits einenadventlichenBußgottesdienst.„AusderAngstinsLeben“–unterdiesemLeitthema stehtindiesemJahrderBußgottesdienstamviertenAdvent.
AmTagvordenHerbstferien habendieSchülerdessechsten SchuljahresderIGSOsthofen einenSchülerlaufveranstaltet undsovonihrenSponsoren insgesamt3.284Eurogesammelt.














































































































































































































































































































































































DieeineHälftewirdtraditionellfürdieUnterstufenabschlussfahrtverwendet,dieanderezugunstenderUNICEFNothilfeinderUkraine.






AuchindiesemJahrhießes anderIGS-Osthofenwieder: „WirlaufenfürUNICEF“.


AlleSchülerinnenundSchülerdes6.Jahrgangshabenauf derSportanlageamSommerriedihrBestesgegebenumbenachteiligtenKindernzuhelfen.


NachdemindenFamilien undBekanntenkreisender SchülereifrigSponsorenfürdie Laufrundengeworbenworden sind,waresamletztenSchultag vordenHerbstferienendlichso weit,stattwieüblichimKlassensaalzubüffeln,einfachmal draußenzuseinundsichsportlichfüreinengutenZweckzu
messen.BeiallerAnstrengung wurdeaberderSpaßunddas leiblicheWohlnichtvergessen. DieElternsorgtenmitGetränkenundeinemabwechslungsreichenBuffetfürgenügend Kraft,ummöglichstvieleRundenzuschaffenunddasErste Hilfe-Teamstandselbstverständlichbereitfüreventuelle Hilfeleistungen.
Dringendbenötigte humanitäreHilfe







































































































Undwernichtgeradeselbst lief,halfdenSchulkameraden dieGummiringeauszuteilen, umanderenAnzahlfestzustellen,wievieleRundengeschafft wurden.
DasErgebnisdesTageskann sichsehenlassen:InsgesamterliefendieKinderderIGS-OsthofeneinenSpendenbetragvon 3.284Euro.DieeineHälftedes GeldesgehtalsSchulanteilan dieUnterstufenfahrtfürdie Läufer,wennsieinder7.Klasse sind,unddieanderezugunsten fürUNICEFfürdieUNICEF-
NothilfeinderUkraine.„Gut7 MillionenMenschensindinnerhalbderUkraineaufderFlucht und7,6Millionensindoffiziell außerLandesgeflohen.Mehr als18MillionenMenschen brauchendringendhumanitäre Hilfe,besondersjetzt,wennder Winterbeginnt“,kannDorothea SpillevonderUNICEF-ArbeitsgruppeWormsberichten,die sichfürdieSpendenmiteinem VortragüberdieArbeitvon UNICEFbeidenLäufernherzlichstbedankt.

ImAnschlusszudemVortrag gabesdanneinenFilmüber denSpendenlaufbevoresdann zurVerleihungderMedaillen undUrkundenging.
Spendenkonto






























































Spendenkonto:IBAN DE41370205003031722560,Bank fürSozialwirtschaft–Kennwort „UNICEF-NothilfeUkraine“.Bei vollständigerAngabederAdressewirdbeiSpendenbeträgen über25EurogerneeineSpendenquittungausgestellt.






































Samstag,17.Dezember2022| NIBELUNGENKURIER NIBELUNGENKURIER 9 Alzeyer Str. 121 . 67549 Worms www.blackandwhite.de WEITERE INFOS AUF: EINER PERSON EINER PERSON VERTRAG ABSCHLIESSENVERTRAG ABSCHLIESSEN && 2 WOCHEN TRAINING SCHENKEN 2 WOCHEN TRAINING SCHENKEN 4. ADVENTS WOCHE 4. ADVENTS WOCHE 18.-23.12.2022 18.-23.12.2022 Kämmererstraße35 (gegenüberehem.Kaufhof) Worms • Tel.0 62 41/230 94 Mo.– Sa. 9 45bis 18 Uhr Hafergasse6 • Worms • Tel062 41/82292 www.juwelier-safak de Mo.– Sa 10bis 18 Uhr &
Fest!
UNICEF: SchülerderIntegriertenGesamtschuleinOsthofenerlaufen1.642Euro Spendenquittungkannausgestelltwerden „WirlaufenfürUNICEF“ LANDESAPOTHEKERKAMMER: Apothekennotdienstzu WeihnachtenunddemJahreswechsel
Dasbesondere Geschenk zum
NacheigenerVorlage gefertigt
DorotheaSpille(2.vonlinks,vorne)freutsichfürUnicefüberdasEngagementderSchülerinnenundSchüler. Foto:MircoMetzler/DieKnipser WORMS: Domam18.Dezemberab19.45UhrimKerzenscheinerleben/KrippeimWestchorwiederzugänglich
KURZNOTIERT
„WinterMomente“mit
AngelikaMilsterentfällt!
DerVeranstalter„RGV EventGmbH“hat„Angelika Milster–WinterMomente“ amDonnerstag,dem5.Januar2023,um19.30Uhr,in derWormserDreifaltigkeitskirche,abgesagt.
Diebereitserstandenen EintrittskartenkönnenabsofortinderVorverkaufsstelle zurückgegebenwerden,in dersiegekauftwurden.
Lincoln-Gastspieldes
„Duos Mimikry“entfällt
DasGastspieldesDuoMimikryamFreitag,dem6. Januar2023,imWormser LincolnTheater,mussindie kommendeSpielzeitverlegt werden.DerErsatztermin wirddannzeitnahbekanntgegeben.
Kreishaushaltbleibtstabil

„DerLandkreisAlzey-Worms istbisherrobustdurchdieKrise gekommen“,sagtLandratHeiko SippelimRückblickaufdas Haushaltsjahr2022.IndenZeitenderKriseseidaskeine Selbstverständlichkeit.Unter diesenVorzeichenblicktSippel mitvorsichtigerZuversichtauf denHaushaltfürdaskommendeJahr.
Voraussichtlicher Jahresüberschussfür2023
Sowieindenvergangenen siebenJahrensiehtderKreishaushaltauchfürEnde2023einenJahresüberschussvor–solltenkeineunvorhersehbaren Kosteneintreten.„Wirplanen weiterhinvorsichtigundrealistisch“,kommentiertderKreischefdieseEntwicklung.InKrisenzeitenzukalkulieren,seikeineleichteAufgabe.
InmittengroßerHerausforderungengibtesmehreregute Nachrichten.2013lagdieVerschuldungbeidenKassenkreditendesLandkreisesbei92MillionenEuro,zehnJahrespätersind esmittlerweile44,5MillionenEuro.Esistgeplant,dassdieLiquiditätsverschuldungbisEnde2023 auf39MillionenEurosinkt.Ein Erfolg,dervorallemdurchdie gutewirtschaftlicheEntwicklung imLandkreisaberauchdurcheisernesSparenerzieltwurde.
DerKreisumlagesatzbleibt unberührt,dieserbeträgtseit 201744,90Prozent.
AuchdieMüllgebührbleibtwie indenvergangenenneunJahren unverändert.DieWichtigkeitvon Wertstoffhöfenhatsichauchin diesemJahrgezeigt.DiegewissenhafteMülltrennungderBürger/innenhatunteranderemdazu geführt,dass2022alleinbeider PapierverwertungmiteinemGe-
winnvonrund1,3Millionengerechnetwerdenkonnte.Grund hierfürsinddiesteigendenAltpapierpreise.„WertstoffhöfesindsowohleineUmwelt-alsaucheine Kostenentlastung“,soLandrat Sippel.FürdasnächsteJahrwurdenPapiererlösebeivermutlich etwassinkendenPreisenvon rund900.000Eurokalkuliert.
Für2023hatderLandkreis17,4 MillionenEurofürInvestitionen eingeplant.Hiervonwerden7,8 MillionenEuroindiekreiseigenenSchuleninvestiert.Hier konntebereitsvielessaniertund erneuertwerden,vonFachsälen biszuSanitäranlagen.BarrierefreiheitSchulen,Brandschutz undDigitalisierungsindThemen dieinderkommendenZeitim Mittelpunktstehenwerden.
AberauchinKitas,diekreiseigenenStraßenundindenGlasfaserausbauwirdimkommendenJahrinvestiert.

DASWORMSER: Die„JoeCockerStory“istam14.Januarum 20Uhrlivezuerleben/KartenbeimNK
MitreißendeShowüber dasLebenderRocklegende
WasmachtedenMannausder englischenStahlstadtSheffieldzu dem,waserwurde?WerbegleitetedieseLegendemusikalisch,geschäftlichundprivataufseinem WayofLifebisinsNirvana?VerpacktineineGeschichte,diedas extremeAufundAbeinesstets umseinLebenundseineKarriere kämpfendenStarsrealaufzeigt, entstehtfürdenBetrachterdieser MusikrevueamSamstag,dem14. Januar,um20Uhr,imWORMSER,eineperfekteIllusion.DieserDarstellungLebeneinzuhauchen,musikalischwieschauspielerisch,stellensichinderMusikrevue
Die„JoeCockerStory“keine geringerenalsdieimRuhrgebiet beheimatetenundmittlerweile kultigen„Komm’MitMann!s“.In
dermitreißendenShowwirddem BesuchervielWissenswertesaus demLebenvonJoeCockervermittelt,natürlichbegleitetvonseinen weltweitbekanntenSongsund SzenenausseinemLeben.Diese RevuekommtmitwenigBühnenbildundRequisiteausundselbst eingefleischteFanswerdenviel NeuesüberihrIdolerfahren.
EintrittskartenfürdiesesmusikalischeHighlightgibtesimVorverkaufu.a.beimNibelungenKurier,Prinz-Carl-Anlage20,67547 Worms,beimTicketService Worms,Rathenaustraße11,67547 Worms,beiallenanderenTicketRegional-VVK-Stellensowieunter www.das-wormser.de.DerEintrittspreisbeträgtzwischen23und31 Euro,anderAbendkassejew.2 Eurohöher.
(spp-o) ObdurchSchokolade oderObst:ZuckerausderNahrungwirdimMunddurchbestimmteBakterien(Plaquebakterien)inSäurenumgewandelt, diesichalsBelagaufdieZähne legen.DiesegreifendenZahnschmelzan.MitderZeitkann dadurchKariesentstehen,wobeidieZahnsubstanzzerstört wird.MitgründlicherMundhygieneundeinerzuckerarmen Ernährungkannmanvorbeugen.ZusätzlichkönnenbestimmteMikronährstoffeden Zahnschmelzstärken.MindestenszweimaltäglichZähneputzen,idealerweisemiteinerfluo-
ridhaltigenZahnpasta,istein MussfürgesundeZähne.FluoridistimSpeichelenthalten undverhindert,dassMineralstoffeausderZahnsubstanz herausgelöstwerden.GleichzeitigmachtesdenZahnschmelz widerstandsfähiger.FluoridbindetinderMundhöhlezahnschädigendeSäurenundträgtdamit zuderenNeutralisierungbei–wirddabeiaberauchausdem Zahnschmelzherausgelöst.Es istdahersinnvoll,regelmäßig kleineMengenFluorid,zum BeispieldurchdieZahnpasta, aufzunehmen. MehrInfosunter www.vitamindoctor.com/karies

GeradeimAlterundbeiMenschenmitBeeinträchtigungenist dieFragedeskomfortablenWohnenssehrwichtig.Rheinhessenlift beliefertseit2012Menschenmit verschiedenenHilfsmitteln,welcheaufgrundvonKrankheitund AlteraufHilfeangewiesensind.
Treppenlifte,Plattformlifteund Homeliftesindsicher,zuverlässig, preiswertundsehreinfachzubedienen.DasMarkenzeichenseit10 Jahren:KompetenterServiceso-
wohlvoralsauchnachdemKauf. SeiteinigenJahrenisteinPflegekassenzuschussvonbiszu4.000 Euromöglich!AufWunschwird derBetragdirektmitderPflegekasseverrechnet.
Rheinhessenlift GisbertLoos Neugasse24 55234Wendelsheim Telefon06734/913668 www.rheinhessenlift.de
Pflege
Grundpflege(Körperpflege)

Behandlungspflege Verhinderungspflege FörderungderFähigkeitendesPflegebedürftigenzurselbstbestimmten GestaltungdesAlltags
Beratung nach§37,3SGBXI Beratung/SchulungamKrankenbett Demenzberatung KursefürpflegendeAngehörige
Betreuung
inderHäuslichkeit Entlastung vonpflegendenAngehörigen inverschiedenenBereichen Hauswirtschaft Zusatzangebote SAPV=spezialisierteambulantePalliativversorgunginKooperationmitdem FördervereinderambulantenPalliativversorgungRheinhessen/Pfalze.V.


22_46s
PflegehilfsmittelgratisbeieinemvorliegendenPflegegrad (40-Euro-Regelung)–diesemonatlicheLeistungderPflegekassenfürPflegebedürfnissesetzt dieAnhaltGmbHausFlörsheim-DalsheimeinfachundohneBürokratiefürdenPatienten um.EsgenügtdieZusendung desAntragsaufKostenübernahme(nur1Blatt),allesandere (EinholungderGenehmigung derPflegekasse,Beratungund LieferungderPflegeartikel)wird kostenloserledigt.Auchein WechseldesAnbietersistproblemlosmöglich.
DieAnhaltGmbHistauch LeistungserbringerallerPflegeundKrankenkassenmitSchwer-
punktRezeptezurGrundversorgungbeiInkontinenz.Patienten wünschensichoftzurbesseren gesellschaftlichenTeilhabeProduktemithöhererSaugkraft, kaumsichtbarodergeräuschlos. MitguterBeratunginkl.kostenloserBemusterungundgeringerAufzahlungsinddiese ProdukteallerführendenAnbieterwieTena,SenioderHartmannerhältlich.DieAnhalt GmbHliefertauchHilfmittel wieEss-SchutzfürErwachsene oderKatapultsitzfürleichtes Aufstehen.
WeitereInformationenunter: www.günstiger-pflegen.de Telefon06243/90360



10 NIBELUNGENKURIER NIBELUNGENKURIER| Samstag,17.Dezember2022 Beate Biegi · Vertragspartner der Kranken- und Pflegekassen Tel. (0 62 47) 2 71 33 79 www.marbea-pflege.de • Zellertalstraße 8 • 67551 Worms Krankenpflege Seniorenpflege • Betreuung • Hauswirtschaft ck42sa21 Pflegedienst Wir pflegen von . Im ganzen Kreis Alzey/Worms! A-Z Krankenpflege Seniorenpflege Betreuung Fußpflege Familienbetreuung Hauswirtschaft FriseurHeimdienst Vertragspartner der Kranken- und Pflegekassen Tel. 06247 / 271 33 79 + Mobil 0152 - 53 64 50 48 www.marbea-pflege.de - Enzingerstr. 2 - 67551 Worms Pflegedienst GmbH GRATIS PFLEGEHILSMITTEL SICHERN! Anhalt GmbH · Willy-Brandt-Ring 12 · 67592 Flörsheim-Dalsheim Telefon: (0 62 43) 90 36-0 · Fax: (0 62 43) 90 36-28 Produkte für Gesundheit, Fitness und Altenp ege Dienstleister aller Kranken- und P egekassen www.günstiger-p egen.de 22_22s Bereits ab Pflegegrad 1! In nur 5 Minuten Antrag auf Kostenübernahme ausfüllen: 30 Jahre www.moving-krankenfahrdienst.de info@moving-krankenfahrdienst.de Montag 06:00••• WORMS ALZEY MAINZ MOVING WORMS ALZEY MAINZ KRANKENFAHRDIENST MOVING - 06242 9009977 www.moving-krankenfahrdienst.de 06131 - 2056606 info@moving-krankenfahrdienst.de Montag - Sonntag 06:00 bis 23:00 Uhr (Telefonzentrale) Partner gesetzlichen Krankenkassen aller - Tragestuhlbeförderung • - Rollstuhlbeförderung • - Liegendbeförderung • Anzeigensonderverö en lichung DASLEBENIMALTER Worms Brauereistraße16 Tel.06241/9702693 Hangen-Weisheim Johanniterhofstraße10 Tel.06735/9415585 AufenthaltohneAbzugamPflegegeld! KostenloserProbetagmöglich. •eigenerFahrdienst•volleVerpflegung Tagespflege 6 m 21
ANHALTGMBH: PartnerinderhäuslichenPflege Kompetentundortsnah KARIES:
ZahnpflegeundgründlicheMundhygiene RHEINHESSENLIFT: VomAnbieterausderRegionprofitieren 10JahreRheinhessenlift–jetztMobilitätsichern Foto:bernardbodo/stock.adobe.com/vitamindoctor.com/akz-o
„DasLebenimAlter“
TippsfürgesundeZähne
DernächsteRatgeber
erscheintam Samstag, 14.Januar2023
KREISALZEY-WORMS: KreistagbeschließtdenHaushaltfürdasJahr2023
GeschenketippsfürjedesBudget
DieWeihnachtsmärktelocken endlichwiedermitGlühweinund gebranntenMandelnundsogar dieerstenFlockensindmancherortsschongefallen–sichereZeichendafür,dassesmitgroßen SchrittenaufWeihnachtenunddie GeschenkeuntermBaumzugeht. UmdemGeschenkestressvorzubeugen,sorgtMediaMarktWorms fürjedeMengeInspirationen.Ob fürdenPartner,dieEltern,Kinder oderFreunde,dieMitarbeitenden vorOrtgebenfürjedesBudget undjedenWunschgernHilfestellung,umdasPassendezufinden.
DiealljährlicheFrage,welche PräsentefürdieLiebstenunter demWeihnachtsbaumliegensollen,sorgtschnellfürHektikund Anspannungindergemütlichen Vorweihnachtszeit.Dochkeine Sorge,wernochkeineGeschenke besorgthat,kannsichaufdenMediaMarktWormsverlassen.„Ob GadgetszumStromsparen,Fit-

nesstracker,Smartphonesoder Küchenmaschinen–auchindiesemJahrfindetmanbeiunsviele tolleTechnik-Highlightsfürjedes Budget“,versprichtGeschäftsführerMarkusFleck.„Undwersich nichtsicherist,kannaufdieUn-
DASLEBENIMALTER
MEDIKAMENTESICHEREINNEHMEN
terstützungunsererFachberaterinnenund-beraterzählen.SofindetsicherlichjedernochdiepassendenGeschenkefürseineLiebsten.“
StrahlendeAugenfürkleine undgroßeKinder
Kinderfreuensichübereine neueTonieFigur,dieAction,AbenteueroderauchWeihnachtsstimmunginsKinderzimmerbringt–derThemenvielfaltsindkeine Grenzengesetzt.DieHörfiguren werdeneinfachaufdieToniebox gestelltundlosgehts.
KreativeBeschäftigungfürdie Kleinenbringendievielfältigen SpielideenvonLego.ObBausätze vonLegoFriendsoderFahrzeuge vonLegoTechnik–hieristfürjedenkleinenEntdeckeretwasdabei.AbwechslungfürGamerbietet zumBeispielZubehörwieeinRacingLenkrad,einneuerGaming-
StuhlodereinemobileKonsole wiedieNintendoSwitchLite.Klein undleichtkannmandieKonsole überallmithinnehmenundunterwegsinvirtuelleWelteneintauchen.
Durchstartenund Entspannen
AuchWeihnachtenkannman schonandieZeitnachden Schlemmereiendenken:MiteinemFitnesstrackersindallegut beraten,diedieFüßenichtnur hochlegenwollen.AuchgünstigereModellemachenrichtigSpaß undhelfen,denAlltagaktiverzu gestalten.
FürwenigerBewegung,aberdafürmehrEntspannungaufdem SofasorgteinStreamingPlayer wiebeispielsweisederGoogle Chromecast,derbestesEntertainmentmitschnellemStreaming undeinemkristallklarenBildmit
leuchtendenFarbeninbrillanter HD-Qualitätliefert.Praktischbeim Sportoderunterwegssindauch dieAppleAirPodsPro.Aufder einenSeitebietensieaktiveGeräuschunterdrückung,lassenaber imTransparenz-ModusAußengeräuschezu.DasperfekteGadget füralleiPhoneNutzer,umendlich denKabelsalatderKopfhörerhintersichzulassen.
Küchenzauber
Hobbyköchefreuensichimmer übertatkräftigeUnterstützungin derKüche.VielseitigeKüchenmaschinensindderoptimaleBegleiteramHerd:DieZutatenwerden geknetet,verquirltodergeraspelt. MitdementsprechendenAufsatz könnenmancheModellesogarzu einerEis-oderNudelmaschine werden.
SilvesterwäreschonderperfekteAnlass,umeinenKlassikerim
modernenGewandauszuprobieren:EinRaclettemiteinerVielzahl anPfännchensorgtfürkulinarischenGenussangeselligenAbendenmitFamilieundFreunden.

AufdieSocken,fertig,los!
Füralle,diejetztdochnoch nichtdasRichtigegefundenhabenoderdenendieEntscheidung schwerfällt,hatMediaMarkt Wormsnocheinenoriginellen Tipp:Sockenschenken!WasbisherderabsoluteKlassikerunter denGeschenkefailswar,wirdin diesemJahrmitMediaMarktzum Must-have.
DieMediaMarktGutschein-SockebietetnichtnurWeihnachtsstimmungfürdieFüße,sondern überraschtTechnikfansmiteinemGuthabenbis150Eurofür ihrennächstenEinkauf.Einfach Sockengrößeauswählen,Guthabenaufladenundverschenken.
InderEngels-Bäckerei
Wechselwirkungenvermeiden
en-Weisheim terhofstraße10 35/9415585
mPflegegeld! möglich.
Verpflegung
ge 6 m 21
(spp-o) ObSchmerztabletten, MittelgegenSodbrennenoder gegenBluthochdruck:Rund25 ProzentderBundesbürgerhaben imJahr2021regelmäßigdreioder mehrMedikamenteeingenommen.DieEinnahmeunterschiedlicherArzneimittelkannjedoch zuWechselwirkungenführen: „DieWirkungeinzelnerMedikamentekannsichverstärkenoder soabschwächen,dasssieunwirksamwerden“,sagtDr.Johannes Schenkel,ärztlicherLeiterderUnabhängigenPatientenberatung Deutschland(UPD).
InsbesondereältereMenschen oderPersonenmiteinerchronischenErkrankungsindhäufig aufdieEinnahmemehrererMedikamenteangewiesen.„Wechselwirkungenkönnendabeisowohlbeiärztlichverordneten MedikamentenalsauchbeiArzneimittelnauftreten,dieohne RezeptinderApothekeerhältlich sind“,sagtDr.Schenkel.Beispielsweisekönnenbestimmte
SchmerzmitteldieWirkungvon Medikamentenverstärken,welchedieBlutgerinnunghemmen sollen.MittelgegenSodbrennen könnenwiederumdieWirkung vonAntibiotikaverringern.

VorderEinnahmeeinesneuen MedikamentessolltenSieIhren ArztoderApothekernachmöglichenWechselwirkungenfragen. InformierenSieihndarüber,welcheanderenArzneimittelSieeinnehmen.BestehtdieGefahrvon Wechselwirkungen,könnenSie gemeinsamLösungenfinden.
Manchmalreichtesaus,bestimmteBlutwerteimBlickzu behalten.„InanderenFällen kanndiegleichzeitigeEinnahme vonMedikamentenjedochgefährlichsein.DerArztoderApothekerwirddannnachgeeignetenAlternativensuchen.“SiehabenFragenzumThemaWechselwirkungen?DieUPDberätSie professionellundkostenfreiunter0800/0117722sowieunter www.patientenberatung.de
EinkleinesTheaterstück,dargestelltvondenMitarbeiterndes AGAPLESIONSophienstifts,verzauberteBewohnerundGäste. EngelschwirreninderBackstube umher,rollenTeigaus,wiegen Mehlundschiebengroße BackblechemitfrischausgestochenenPlätzchenindenOfen. EinEngelallerdingssitztnurin derEckeunddarfnichtmitmachenundsollnursaubermachen –alleEngelsindüberzeugt:Der kanndasnicht.SchließlichkommendasChristkindundder Weihnachtsmannvorbei,umdas fertigeGebäckfürdasWeihnachtsfestabzuholen.Siesehen dentraurigenEngelinderEcke
undmachendenanderenEngeln deutlich,dassjederinderGemeinschaftwichtigist,auch wennernichtallesbesondersgut kann.DieEngelsehenihrenFehlereinundlassendenkleinen Engelbeiallemmitmachen,alle sindglücklich. DasPublikumbedanktesichmit einemlanganhaltendenApplaus,Engel,Christkindundder Weihnachtsmannverteiltennoch TütenmitGebäckanBewohner undGäste.Einrichtungsleiter HaraldOswaldwarbegeistert undbedanktesichbeidenDarstellernundauchfürdastolle Bühnenbild,dasfüreineweihnachtlicheAtmosphäresorgte.
ZUHAUSE IN CHRISTLICHER GEBORGENHEIT
ZUHAUSE IN CHRISTLICHER GEBORGENHEIT

AGAPLESION ist einer der bundesweit führenden Gesundheits- und Pflegedienstleister für Senioren. Als christliches Unternehmen ist tätige Nächstenliebe
• Stationäre Pflege, Kurzzeitpflege, Tagespflege






• Vielfältige Freizeit- und Betreuungsangebote
• Aktivierende ganzheitliche Versorgung
• Gottesdienste (ev./kath., Andachten, Hausseelsorge) Sprechen Sie uns an. Wir sind gerne für Sie da.






uns an. Wir sind gerne für Sie da.




Römerstr. 18-22 67547 Worms T (06241) 904 - 0
Odenwaldstr. 1 67551 Worms-Pfeddersheim T (06247) 104 - 1




















AGAPLESION ist einer der bundesweit führenden Gesundheits- und Pflegedienstleister für Senioren. Als christliches Unternehmen ist tätige Nächstenliebe unser Auftrag. Und genau das macht den Unterschied. www.hdv-darmstadt.de


Samstag,17.Dezember2022| NIBELUNGENKURIER NIBELUNGENKURIER 11 Rheinhessenlift eK, Neugasse 24, 55234 Wendelsheim, Tel. (06734) 91 36 68 www.rheinhessenlift.de info@rheinhessenlift.de Profitieren Sie von dem Anbieter aus Ihrer Region Aktuell: Treppenlift für gerade Treppen ab € 2.998,–Pflegekassenzuschuss von bis zu € 4.000,– möglich! jg.16mi16 Wir helfen hier und jetzt Auch wenn die Welt verrückt spielt. Wir sind für Sie da! Ambulante Pflege - Tagespflege Hausnotruf - Essen auf Rädern Jetzt informieren unter Tel.: 06241 / 978790 www.asb-worms.de • Stationäre Pflege, Kurzzeitpflege, Tagespflege • Aktivierende ganzheitliche Versorgung • Vielfältige Freizeit- und Betreuungsangebote • Gottesdienste (ev./kath., Andachten, Hausseelsorge) Sprechen Sie
AGA_Sophienstift_MLH_AZ_143x60_220211.indd
12:45:06 Uhr
1 22.02.2011
unser Auftrag. Und genau das macht den Unterschied. www.hdv-darmstadt.de Odenwaldstr. 1 67551 Worms-Pfeddersheim T (06247) 104 - 1 Römerstr. 18-22 67547 Worms T (06241) 904 - 0 AGA_Sophienstift_MLH_AZ_143x60_220211.indd 1 22.02.2011 12:45:06 Uhr www.hdv.agaplesion.de 22_06s ZUHAUSE IN CHRISTLICHER GEBORGENHEIT www.hdv.agaplesion.dewww.hdv.agaplesion.de Stationäre Pflege, Kurzzeitpflege, Tagespflege • Vielfältige Freizeit- und Betreuungsangebote Aktivierende, ganzheitliche Versorgung AGAPLESION MARTIN LUTHER HAUS Odenwaldstraße 1, 67551 Worms T (06247) 90 45 00 - 0 AGAPLESION SOPHIENSTIFT Römerstraße 18-22, 67547 Worms T (06241) 904 - 0 AGAPLESION DIETRICH BONHOEFFER HAUS Hospitalstraße 1, 68623 Lampertheim T (06206) 955 - 0 Hausseelsorge, Gottesdienste und Andachten (ev. kath.) • Täglich frisch zubereitete Mahlzeiten aus der eigenen Küche Mitten im Leben: Zentrale Lage im Ortszentrum Zuhause in christlicher Geborgenheit · In der über 100-jährigen Tradition des Hessischen Diakonievereins In Trägerschaft der HDV gemeinnützige GmbH, Darmstadt. Im Verbund der AGAPLESION gAG. Stationäre Pflege, Kurzzeitpflege, Tagespflege • Vielfältige Freizeit- und Betreuungsangebote Aktivierende, ganzheitliche Versorgung AGAPLESION MARTIN LUTHER HAUS Odenwaldstraße 1, 67551 Worms T (06247) 90 45 00 - 0 AGAPLESION SOPHIENSTIFT Römerstraße 18-22, 67547 Worms T (06241) 904 - 0 AGAPLESION DIETRICH BONHOEFFER HAUS Hospitalstraße 1, 68623 Lampertheim T (06206) 955 - 0 Hausseelsorge, Gottesdienste und Andachten (ev. kath.) • Täglich frisch zubereitete Mahlzeiten aus der eigenen Küche Mitten im Leben: Zentrale Lage im Ortszentrum Zuhause in christlicher Geborgenheit · In der über 100-jährigen Tradition des Hessischen Diakonievereins In Trägerschaft der HDV gemeinnützige GmbH, Darmstadt. Im Verbund der AGAPLESION gAG. Stationäre Pflege, Kurzzeitpflege, Tagespflege Vielfältige Freizeit- und Betreuungsangebote Aktivierende, ganzheitliche Versorgung AGAPLESION MARTIN LUTHER HAUS Odenwaldstraße 1, 67551 Worms T (06247) 90 45 00 - 0 AGAPLESION SOPHIENSTIFT Römerstraße 18-22, 67547 Worms T (06241) 904 - 0 AGAPLESION DIETRICH BONHOEFFER HAUS Hospitalstraße 1, 68623 Lampertheim T (06206) 955 - 0 Hausseelsorge, Gottesdienste und Andachten (ev. kath.) Täglich frisch zubereitete Mahlzeiten aus der eigenen Küche Mitten im Leben: Zentrale Lage im Ortszentrum Zuhause in christlicher Geborgenheit · In der über 100-jährigen Tradition des Hessischen Diakonievereins In Trägerschaft der HDV gemeinnützige GmbH, Darmstadt. Im Verbund der AGAPLESION gAG. www.hdv.agaplesion.dewww.hdv.agaplesion.de Stationäre Pflege, Kurzzeitpflege, Tagespflege • Vielfältige Freizeit- und Betreuungsangebote Aktivierende, ganzheitliche Versorgung AGAPLESION MARTIN LUTHER HAUS Odenwaldstraße 1, 67551 Worms T (06247) 90 45 00 - 0 AGAPLESION SOPHIENSTIFT Römerstraße 18-22, 67547 Worms T (06241) 904 - 0 AGAPLESION DIETRICH BONHOEFFER HAUS Hospitalstraße 1, 68623 Lampertheim T (06206) 955 - 0 Hausseelsorge, Gottesdienste und Andachten (ev. kath.) • Täglich frisch zubereitete Mahlzeiten aus der eigenen Küche Mitten im Leben: Zentrale Lage im Ortszentrum Zuhause in christlicher Geborgenheit · In der über 100-jährigen Tradition des Hessischen Diakonievereins In Trägerschaft der HDV gemeinnützige GmbH, Darmstadt. Im Verbund der AGAPLESION gAG. Stationäre Pflege, Kurzzeitpflege, Tagespflege • Vielfältige Freizeit- und Betreuungsangebote Aktivierende, ganzheitliche Versorgung AGAPLESION MARTIN LUTHER HAUS Odenwaldstraße 1, 67551 Worms T (06247) 90 45 00 - 0 AGAPLESION SOPHIENSTIFT Römerstraße 18-22, 67547 Worms T (06241) 904 - 0 AGAPLESION DIETRICH BONHOEFFER HAUS Hospitalstraße 1, 68623 Lampertheim T (06206) 955 - 0 Hausseelsorge, Gottesdienste und Andachten (ev. kath.) • Täglich frisch zubereitete Mahlzeiten aus der eigenen Küche Mitten im Leben: Zentrale Lage im Ortszentrum Zuhause in christlicher Geborgenheit · In der über 100-jährigen Tradition des Hessischen Diakonievereins In Trägerschaft der HDV gemeinnützige GmbH, Darmstadt. Im Verbund der AGAPLESION gAG. Stationäre Pflege, Kurzzeitpflege, Tagespflege Vielfältige Freizeit- und Betreuungsangebote Aktivierende, ganzheitliche Versorgung AGAPLESION MARTIN LUTHER HAUS Odenwaldstraße 1, 67551 Worms 90 45 00 - 0 AGAPLESION SOPHIENSTIFT Römerstraße 18-22, 67547 Worms T (06241) 904 - 0 AGAPLESION DIETRICH BONHOEFFER HAUS Hospitalstraße 1, 68623 Lampertheim T (06206) 955 - 0 Hausseelsorge, Gottesdienste und Andachten (ev. kath.) Täglich frisch zubereitete Mahlzeiten aus der eigenen Küche Mitten im Leben: Zentrale Lage im Ortszentrum Zuhause in christlicher Geborgenheit · In der über 100-jährigen Tradition des Hessischen Diakonievereins In Trägerschaft der HDV gemeinnützige GmbH, Darmstadt. Im Verbund der AGAPLESION gAG. AGAPLESION DIETRICH BONHOEFFER HAUS WOHNEN & PFLEGEN Hospitalstraße 1 68623 Lampertheim T (06206) 955 - 0 AGAPLESION SOPHIENSTIFT WOHNEN & PFLEGEN Römerstr. 18-22, 67547 Worms (06241) 904 - 0 KRANKENFAHRDIENST MOVING www.moving-krankenfahrdienst.de info@moving-krankenfahrdienst.de Montag 06:00 bis - Tragestuhlbeförderung • - Rollstuhlbeförderung • - Liegendbeförderung • Pflege persönlich Persönliche Betreuung daheim Betreuung zu Hause (sog. 24-h-Pflege) und stundenweise Entlastung / Hilfe im Haushalt Wir sind für Sie da! 06241 - 48 28 908 Georg Leder - Siegfriedstraße 14 - 67547 Worms info@pflege-persoenlich.de - www.pflege-persoenlich.de Anze gensonde veröf entlichung
Telefon 06241 / 9 79 79-39 Landgrafenstraße 49 67549 Worms-Pfiffligheim Qualifizierte Pflege in familiärer Atmosphäre ausH Alten- und Pflegeheim Ihr Wohl liegt uns am Herzen andgraf
AGAPLESIONSOPHIENSTIFT: Theaterstückverzauberte BewohnerundGäste
Engel,ChristkindundWeihnachtsmannverzaubertendieBewohnerunddie Gäste. Foto:AGAPLESIONSophienstift
ApothekerinhilfteinemälterenKunden.
Foto:CecilieArcurs/gettyimages.com/akz-o
UnsereInserenten empfehlensich
MEDIAMARKTWORMS: GoodbyeWeihnachtsstress
ANZEIGE
SpezialitätenausdemOstenEuropas zumFestderLiebe
neuhinzugekommenundhabendasvielfältigeAngebotfür sichentdeckt–mitbekannten MarkenundProduktenausder Ukraine,dieeinStückHeimat vermitteln.Grundsätzlichfindet sichinderbreitenProduktpalettedesinternationalenSortimentsfürjedenKundendas Richtige.
FürHaarundBartwirdetwasgeboten
VonBenjaminKloos› WeihnachtenalsFestderLiebeistzugleicheinFestderSinne–kulinarischeKöstlichkeitengehören dazu.DamitauchIhrFeiertagsmenüzueinemgenussvollen Erlebniswird,bietetderMIX MarktWormseineriesigeAuswahlanosteuropäischenSpezialitäten–imSortimentfinden sichauchvieleneueProdukte ausOsteuropa,beispielsweise ausRumänienunddenBalkanstaaten.HoheQualitätzumerschwinglichenPreismachtdas EinkaufenbeimMIXMarkt WormszumVergnügen.
DieVielfaltkennthierkeine Grenzen,gerademitBlickauf WeihnachtenundSilvester–ob echterrussischerKaviar,Sekt oderdiepolnischeGansoderfrischesObstundGemüsevon vorwiegendregionalenErzeugernoderalsImportausSpanien,HollandundFrankreich.
WertaufdieHerkunftder ProduktelegtdasTeamdesMIX MarktesWormsauchbeiden Fleisch-undWurstwaren.Diese stammenvomregionalenMetzgerundSchlachthofMehlaus Bensheimundwerdenebenfalls direktundfrischandenMIX MarktWormsgeliefert.
NebendergroßenFleischthekeliegteinSchwerpunktim Fischangebot.DieFischtheke bietetdasganzeJahrüberund geradezuWeihnachtenzum BeispielfrischenKarpfenaus hiesigerAufzucht,Lachsund Forellen.DiereichhaltigeAuswahlangeräuchertem,gedörrtemundgesalzenemFischdürfteindernäherenUmgebung einzigartigsein–osteuropäischeSpezialitäteninDeutschlandproduziert.Dastrifftauch aufvieleWurstspezialitätenzu, dienachoriginalosteuropäischenRezeptureninDeutschlandhergestelltwerden.
AusdenbekanntenWeinanbaugebietenOsteuropasführt derMIXMarktWormseinegroßeAuswahl,ebensoanSektpassendfürdasFest.DieAngebotspaletteimMIX-MarktWorms reichtvoneinerriesigenAuswahlanBonbonsundweiteren süßenKöstlichkeitenbishinzu einemumfangreichenSortimentanWein-undWodkaspezialitäten.Hierbeifindensich immerauchRaritätenundSpezialitäten,diesosonstinanderenMärktennichtzufinden sind. IndiesemJahrsindsehr vieleKundenausderUkraine
Modern,hellundfreundlich wirkendieGeschäftsräume,in denendiestetsfrischenWaren alleSinneerfreuen.DavonprofitierenbesondersdieKunden: Aufetwa500m²gibtesbeim MIXMarktWorms–einervon 181Mix-MärkteninDeutschlandundweiteren172inEuropa –mit3.700Artikelnjetztnoch mehrAuswahlundallesfürden täglichenBedarfsowiebesonderekulinarischeAugenblicke. AufdieKundenwartendarüber hinausbesondereAngebote zumJahresende:InderKalenderwoche51abdem19.DezembererhältjederKundeabeinem Einkaufswertvon70Euroeine FlascheSektalsGeschenk.Zum Jahresabschlussgibteszuden gleichenBedingungeneineWochespäterPralinenalsGeschenkhinzu.
DasgesamteTeamdesMix MarktWormsfreutsichauf IhrenBesuch.„Wirbedanken unsbeiallenKundenfürdas unsentgegengebrachteVertrauensowieihreTreueundwünschenIhneneinfriedliches Weihnachtfestundeinenguten RutschinsneueJahr.GernebegrüßenwirauchSiealsneuen KundeninunseremMarkt“.

WeitereInformationenbei:


MIXMarktWorms
Theodor-Heuss-Straße41a 67549Worms-Neuhausen Telefon06241/2088144 www.mixmarkt.eu









Öffnungszeiten: Mo.–Fr.,8–20Uhr,Sa.,8–20Uhr
MitdemreinenHerrensalon, wodenHerrenallesrundum HaarundBartgebotenwird, erweitertMehmetTur,bereits Inhaberder3CoiffureVelly-SalonsinOsthofen,Oppenheim undMonsheim,nunseinAngebotfürdieHerren:„MitBartek undDenizhabenwir2tolleHerrenfriseuregefunden,diedieses füreinensolchenSalonerforderlicheHandwerkglänzendbeherrschen“,soTur.Angeboten werdenHaarschnittefürdie HerrenalsEinzeldienstleistungenoderinKomplettpaketen–auchgleichmitBartpflege.Auch BartrasurenwerdeninverschiedenenFormenangeboten.GesichtsmaskenundKinderhaarschnitterundendasAngebotab. BeiMenStylebyVellywerden

teverwendet.„UnsereKunden verdienenes,dasswirnurmit denbestenProduktenarbeiten“, sagtTur.
Durchgehendgeöffnet,auch montags,dieswirdbeiMenStyle byVellyalsselbstverständliche ServiceleistungfürdieKunden angesehen.

EinenTerminbrauchtman nicht,beiMenStylebyVellyarbeitetmanohneVoranmeldung. Alsoeinfachhingehen,hinsetzenundgenießen.
PünktlichzumNikolaustag am6.DezemberöffneteMen StylebyVellyseinePforten.Ob derNikolausdannauchgleich derallerersteKundefüreine Bartpflegewar,wollteunsMehmetTurabernichtverraten.
PERRONEGRO: MitLiebezubereiteterKaffeegenussindenElefantenhöfen
DenbestenKaffeegibteshintermDom

GegenüberdemDomplatzverläuftdieDechaneigasse,dieam Weckerlingplatzendet(oderwie dieWomsersagen„amWeckerlingsplatz“).Hierfindetsich nichtnurdashistorischeMuseumAndeasstift,sondernauchdie Elefantenhöfen,dieimSommer 2021eröffneten.MehrereFirmen teilensichdenschönen,neugestaltetetHofunddieRäumlichkeitendesehemaligenWeingutes Valckenberg.Auchdie2013in EichgegründeteKaffeerösterei „PerroNegro“hathierihren Hauptsitz.
ImvergangenenJahrgabeseinigeÄnderungenbei„PerroNegro“,sohatmansicheinwenig vergrößert.Zudemwurdenam ZehnthofinEichalleZelteabgebrochenunddieFirmenabläufe undStandorteneugestaltet.NebenderHauptstelleindenElefantenhöfenbestehtweiterhineine kleineVerkaufsstelleimEicher WeingutMenger,Hauptstraße12. DerRösterhatineinerProduktionsstätteinWorms-PfeddersheimseinneuesZuhausegefundenundGeschäftsführerinStephanieGerberistauchprivatmit nachWormsgezogen.
„AlsKindhabeichhierZeitung ausgetragen“,erinnertsiesich, wennmansieaufdieEntstehung derElefantenhöfenanspricht.„Es isteinesoschöneLocationgeworden.Manistmitteninder Stadtundhörtdennochnichts davon.WieeinkleinesFleckchen Urlaub!“,schwärmtdieKaffeeliebhaberin.
AußerdenStandortenunddem neugewonnenenFachpersonal habesichimGrundenichtsgeändert,erläutertdieGeschäftsinhaberin:„Wirröstenweiterhinselbst inManufakturqualität,verwendenbiologischangebautenRohkaffeeundachtenauffairenHandel.“ImletztenJahrhattensich StephanieGerberundihreProkuristinundProduktionsleiterin HeikeMahlerselbsteinBilddes
KaffeeanbausundderErntein Kolumbiengemachtundvondort zweigroßartigeProjektkaffees mitgebracht.Rund25verschiedeneKaffeesortenwerdeninden Elefantenhöfenangeboten.PassendzumWeihnachtsfestergänztdieKaffee-Mischung„Café Festiva“fürkurzeZeitdasSortiment.GernestehenStephanie GerberundihreMitarbeitermit fundiertemWissenundErfahrungenbeiderAuswahlzurSeite.
„EinenleckerenKaffee,CappuccinooderEspressoausderextra fürdieElefantenhöfeentwickelten HausmischungW1solltemansich nichtentgehenlassen“,weißdie Kaffeegnießerin.Samstagskann inderKaffeerösterei„PerroNegro“dasWochenendemiteinem französischenFrühstückeingeläutetwerden.DergenussvolleStart indenTagbestehtauseinem MilchkaffeeundeinemCroissant nachWahlvonderBäckereiBlaser.
PerroNegro–dieEicher Kaffeerösterei Weckerlingplatz1,67547Worms Telefon06241/3025523
















Öffnungszeiten:,Di.–Fr.,10–18Uhr, Samstag,9–16Uhr

12 AUSWIRTSCHAFTUNDGESCHÄFTSWELT NIBELUNGENKURIER| Samstag,17.Dezember2022 Auchin IhrerNähe! DieAngebotesindnurinunserenAbholmärkten erhältlich.NursolangederVorratreicht. AbgabenurinhaushaltsüblichenMengen. ZENTRALE BESTELLANNAHME+ HEIMSERVICE Tel.06241/49585·Fax06241/44385 E-Mail:post@gegros.de AUSLIEFERUNG+ ABHOLMARKT Körnerstraße4–6 67547Worms Tel.06241/49585 ABHOLMARKT AlzeyerStraße191–193·67549Worms Tel.06241/205194 ONLINE-SHOP PRIVATBETRIEBBÜROPARTY https://worms.wir-liefern-getraenke.de KennenSieschonunseren ? Angebotegültig: 14.12.bis24.12.2022 22_50m GegroswünschtfröhlicheWeihnachten 4.29 1/0,75l €5,72/1 10% GÜNSTIGER trocken halbtrocken 4.95 12/0,7lGlas €0,59/1 zzgl.€3,30Pfand Classicoder Medium 10% GÜNSTIGER 4.99 12/0,75lGlas €0,50/1 zzgl.€3,30Pfand 17% GÜNSTIGER KlassischoderMedium 6.99 6/1,0l €1,17/1 zzgl.€2,40Pfand Bio-Mineralwasser NurinderAlzeyerStraße Légère 12.99 20/0,5l €1,30/1l zzgl.€3,00Pfand €1,–GÜNSTIGER Pilsoder Export 14.79 20/0,5l €1,48/1l zzgl.€3,00Pfand Bitburger Pils €1,20 GÜNSTIGER 13.50 6/1,0l €2,25/1l zzgl.€2,40Pfand €1,–GÜNSTIGER Premium-Orange 0.88 1/0,75l €1,17/1l zzgl.€0,15Pfand Limonaden verschiedeneSorten Nurinder AlzeyerStraße 20% GÜNSTIGER 12/1,0lPET zzgl.€3,30Pfand 5.50 €0,46/1l Classicoder Medium€2,–GÜNSTIGER Anze gensonderverö en lichung
nurhochwertigeMarkenproduk-
MIXMARKTWORMS: AngebotaninternationalenundosteuropäischenGenüssen vonKaviarüberfrischenKarpfenbiszuSekt/DankandieKundenfürVertrauenundTreue
MENSTYLEBYVELLY: NeuerHerren-FriseursalonabsofortinOsthofen
inderSickingenstraße1nebender VolksbankeinFriseursalonfürHerren: MenStylebyVelly.
SpeziellzumWeihnachtsfestbietetderMIXMarktWormseinegroßartigeAuswahl–soauchbeimfrischenFisch,unteranderemmitKarpfenfürsFest. Foto:BenjaminKloos AmNikolaustageröffneteinOsthofen
MESCHERT Elektro-Technik
ElektronikundElektrotechnik sindallgegenwärtig,–siemachendasLebenwesentlichsichererunddenAlltagerheblich komfortabler.
Daheristeswichtig,dasssich allesaufeinemgutenStandder Technikbefindetundvorallem funktioniert!Vondereinfachen InstallationüberkomplexeSystemeimBereichderAnlagensteuerung,Gebäudetechnikund KommunikationbietetdieMeschertElektro-TechnikGbRaus


Worms-PfeddersheimumfassendeBeratungundtechnisch hoheFachkompetenz.
Auchim75.JahrihresBestehensgenießtdieFirmaElektrotechnikRolfundThomasMeschertüberdieGrenzenvon WormshinauseinenhervorragendenRufalszuverlässiger undkompetenterAnsprechpartnerundFachbetriebfürGebäudetechnik.KommunaleAuftraggeber,privateHaushalte,aber auchIndustrieundKleingewer-



beschätzendasFamilienunternehmen,dasderzeitvonden beidenElektrotechniker-MeisternundBetriebswirtenHWK RolfundThomasMeschertin dritterGenerationgeführtwird.
KundendienstundService werdenbeiMeschertElektrotechnikgroßgeschrieben.Die treueKundschaftschätztdieBeständigkeithinsichtlichhandwerklicherQualitätgenausowie dieerfahrenePlanungundBeratung.SämtlicheAufträgewerdenmitdergefordertenPräzision,handwerklichemGeschick undausgewähltenMaterialien erfüllt.
DieBelegschaftnimmtan Fortbildungsmaßnahmenteil undbesuchtSeminare,umdadurchimmeraufdenneusten StandderTechnikzusein.ZurzeitbeschäftigtdieFirmaMeschert10Mitarbeiter,darunter1 Meister,4ElektronikerderFachrichtungEnergie-undGebäudetechnik,3Auszubildendeund2 kaufmännischeAngestellte.
BreitesAngebotsportfolio
BreitgefächertistdieLeistungspalettedesFachbetriebes fürGebäudetechnik.Sieumfasstnebenderklassischen ElektrotechnikmitInstallation
undWartunginNeu-undAltbaudieBereichederFernmeldetechnik,denAufbauvonEDVDatennetzensowiedenBauvon FunkalarmanlagenundSatellitenanlagen.Zudemverfügt ElektrotechnikMeschertüber mehrjährigeErfahrunginWärmepumpen-undKlimaanlagen, FotovoltaikundbeiElektro-Speicherheizungen.Auchwerden Schwachstromanlagen,ElektroSpeicherheizungenundAnlagenfürerneuerbareEnergien
installiertundgewartet.Wenn esumSicherheitinHausund Wohnunggeht,istderMeisterbetriebebenfallsSpezialistfür Einbruch-Meldeanlagenund SprechanlagenmitVideoübertragung. ZudemhabenRolfMeschertundseinSohnThomas anderE-AkademiedesZentralverbandesderDeutschenElektro-undInformationstechnischenHandwerkeaneinerQualifizierungsmaßnahmezurEMobilitätteilgenommen.
Ausbildungsplätzfrei
SeitihrerGründungbildetdie FirmaMeschertimgewerblichenundtechnischenBeruf aus.





InübersiebenJahrzehnten absolviertenhierzahlreiche LehrlingeeinequalifizierteAusbildung.Auchheutenochträgt derMeisterbetriebdafürSorge, dassesinZukunftbestausgebildetenNachwuchsgibt.



WernochimmeraufderSuchenacheinerAusbildungsstättefürdaskommendeJahrist, kannsichgernebeiElektrotechnikRolfundThomasMeschert bewerben.„Aktuellsindwir nochaufderSuchenachAzubis für2023“,erläutertRolfMeschertundergänzt,dassesihm sehrwichtigsei,dieKunden darüberzuinformieren,dasses auchbeiderFirmaMeschert durchcoronabedingteAusfälle sowiefehlendesFachpersonal undderaktuellschwierigenMaterialbeschaffungmitlangen LieferzeitenleiderzuTerminproblemenkommenkann.
„DieungünstigenUmstände, mitdenenvieleBetriebederzeit zukämpfenhaben,treffenauch uns.Wirbedauern,wennes hierdurchzuVerzögerungen kommt“.

Kaminöfen
Edelstahlschornsteine
Kaminöfen







Edelstahlschornsteine
Kaminöfen Edelstahlschornsteine
Schornsteinfegermeister Gebäudeenergieberater im Handwerk Ausstellung nach Absprache geöffnet
Schornsteinfegermeister Gebäudeenergieberater im Handwerk Ausstellung nach Absprache geöffnet
Schornsteinfegermeister Gebäudeenergieberater im Handwerk Ausstellung nach Absprache geöffnet
Schornsteinfegermeister Gebäudeenergieberater im Handwerk Ausstellung nach Absprache geöffnet




Weinbergstraße 31 67592 Flörsheim-Dalsheim Tel: 0 62 43 / 900 53 73 www.ralf-bock.de
Weinbergstraße 31 67592 Flörsheim-Dalsheim Tel: 0 62 43 / 900 53 73 www.ralf-bock.de
Weinbergstraße 31 67592 Flörsheim-Dalsheim Tel: 0 62 43 / 900 53 73 www.ralf-bock.de
Weinbergstraße 31 67592 Flörsheim-Dalsheim Tel: 0 62 43 / 900 53 73 www.ralf-bock.de

Samstag,17.Dezember2022| NIBELUNGENKURIER QUALITÄTAUSMEISTERHAND 13 Anzeigensonderveröffentlichung … kompetent, preiswert & schnell Mainzer Straße 1 · 67547 Worms Tel. 0 62 41/97 71 71 www.glasermeister-wollentin.de Glaserei Wollentin Meisterbetrieb Notfall-Service Tag & Nacht Glas-Reparaturen jeder Art, Einbau von Ganzglasduschen, Ganzglastüren, Brandschutzverglasung, Schaufenster-Reparaturen, Glasmöbelbau, Spiegel, Montage von Fliegengitterfenstern, Montage von Türen und Fenstern u.v.m. rh27sa20 SEIT ÜBER15 JAHREN 22_47s Ihr Partner füranspruchsvolleElektro-Technik MESCHERT Elektro-Technik GbR FachbetriebfürGebäudetechnik Antennenanlagen Elektro-Speicheröfen Alarmanlagen/Kommunikationstechnik TorantriebeundSteuerungen Telekommunikation/EDV-Datennetze ErneuerbareEnergien/Fotovoltaik
Jahre 75 Telefon Telefax info@schreinerei-mar tin.de 0 62 41 97 52 97 0 62 41 97 52 98 Konventstraße 4 - 8 675 49 Worms (Hochheim) f - Fer tigung - Lieferung - Montage Schreinerei Mar - das passt! die schreinerei m a r t i n Meisterbetrieb im Tischler- und Parkettlegerhandwerk gegründet 876 Möbel auf Maß, Innenausbau Möbelteile, Zuschnitt- u. Kantenservice Fenster, Türen, Bauelemente Reparaturen Dielenböden, Parkett, Treppen Verlegen und Renovieren Verleih von Parkettschleifmaschinen cf.31sa19 Telefon Telefax info@schr ei-mar tin.de 0 62 41 - 97 52 97 0 62 41 - 97 52 98 Konventstraße 4 - 8 675 49 Worms (Hochheim) Beratung - Entwur f - Fer tigung Schreinerei Martin - das passt! Möbel auf Maß, Möbelteile, Fenster, Türen, Reparaturen Dielenböden, Verlegen und Verleih von Telefon Telefax info@schreinerei-mar tin.de 0 62 41 97 52 97 0 62 41 97 52 98 Konventstraße 4 - 8 675 49 Worms (Hochheim) Beratung - Entwur f - Fer tigung - Lieferung - Montage Martin die schreinerei m a r t i n Meisterbetrieb im Tischler- und Parkettlegerhandwerk gegründet 1 876 Möbel auf Maß, Innenausbau Möbelteile, Zuschnitt- u. Kantenservice Fenster, Türen, Bauelemente Reparaturen Dielenböden, Parkett, Treppen Verlegen und Renovieren Verleih von Parkettschleifmaschinen Schreinerei Martin - das passt! die schreinerei martin Meisterbetrieb im Tischler- und Parkettlegerhandwerk gegründet 1876 Telefon Telefax info@schreinerei-martin.de 0 62 41 - 97 52 97 0 62 41 - 97 52 98 Konventstraße 4 - 8 67549 Worms (Hochheim) Beratung - Entwurf - Fertigung - Lieferung - Montage Schreinerei Martin - das passt! die schreinerei martin Meisterbetrieb im Tischler- und Parkettlegerhandwerk gegründet 1876 Telefon Telefax info@schreinerei-martin.de 0 62 41 - 97 52 97 0 62 41 - 97 52 98 Konventstraße 4 - 8 67549 Worms (Hochheim) Beratung - Entwurf - Fertigung - Lieferung - Montage Schreinerei Martin - das passt! die schreinerei martin Me sterbetrieb im Tischler- und Parkettlegerhandwerk gegründet 1876 Telefon Telefax info@schreinerei-martin.de 0 62 41 - 97 52 97 0 62 41 - 97 52 98 Konventstraße 4 8 67549 Worms (Hochheim) Beratung - Entwurf - Fertigung - Lieferung - Montage Schreinerei Martin - das passt! die schreinerei martin Meisterbetrieb im Tischler- und Parkettlegerhandwerk gegründet 1876 Möbel auf Maß, Innenausbau Möbelteile, Zuschnitt- u. Kantenservice Fenster, Türen, Bauelemente Reparaturen Dielenböden, Parkett, Treppen Verlegen und Renovieren Insektenschutz DACHDECKER-MEISTERBETRIEB Ausführungsämtlicher Dacharbeiten Gerüstbau • Montage • PV-Anlagen Zollhausstraße30A• 67551Worms-Horchheim Handy(0179)8018325• Tel.(06241)789349 www.dachdeckerei-neubecker.de 22_50s vorm Haus Es freut sich auf Ihren Besuch Ihre Friseurmeisterin Elke Pritsch & Team Öffnungszeiten: Di. bis Do., 8.30 bis 18 Uhr Fr., 8 bis 18 Uhr durchgehend · Sa., 8 bis 13 Uhr Alzeyer Straße 43 · 67549 Worms · Tel. 0 62 41 / 5 74 00 22_11s cf.31sa19 Traditionsunternehmen seit mehr als 100 Jahren hk07sa21 Holz-, Alu- und Kunststoffbearbeitung www.schreinerei-sperb.de Fenster und Türen Insekten-, Sonnen-, Einbruchschutz Rollläden, Klappläden Innenausbau Möbelanfertigung Haustüranlagen Neubau, Umbau, Reparatur u. Renovierung und vieles mehr Mitglied der Tischler-Innung Rheinhessen Inh. Felix Sperb Gewerbestraße 8 67591 Mörstadt Tel. 06247-77 80 Fax 06247-65 41
Leuchten/Geräte Planung Kundendienst ImPennweg7·Worms-Pfeddersheim·Tel.(06247)5058 Meschert-Elektrotechnik@t-online.de
Cs43sa18
Kaminöfen Edelstahlschornsteine
22_15s Kfz-Meisterbetrieb für alle Kfz-Marken und KIA Service Am Ringofen 1 · 67574 Osthofen • Telefon: 0 62 42/61 48 www.autohaus-weiler.de 67547 Worms · Heidenhainstraße 21 · vorndran.worms@t-online.de Telefon (0 62 41) 42 24 · Fax 4 50 67 Badrenovierung auseinerHand cf.31sa19 Schlossergasse 15 • 67227 Frankenthal (0 62 33) 2 80 11 • www.sk-hoerakustik.de rh31sa21 GUT HÖREN MACHT GLÜCKLICH! Mitglied der BaugewerksInnung Alzey-Worms 64 Jahre Meisterbetrieb Fachberater für Wärmedämmung (TÜV zertifiziert) Nahestraße 10 · 67550 Wo.-Rheindürkheim · www.pech-boesing.de (0 62 42) 14 17 · Handy (01 77) 6 58 70 45 Wärmedämmung Innen- und Außenputz Altbaurenovierung Farbliche Gestaltung Trockenbau
Jahre 75 Ihr Partner füranspruchsvolleElektro-Technik
22_35s
GbR
JUBILÄUM: FirmaElektrotechnikRolfundThomasMeschertfeiert75.Jahrestag HandwerklicheQualitätunderfahrenePlanungseitübersiebenJahrzehnten
DieFachleuteumFirmeninhaberRolfMeschertnehmenregelmäßiganQualifizierungsmaßnahmenteil.
ThomasMeschert(imBild)undseinVaterRolfführendenBetriebindritter Generation.
Wir bieten




HEILTEES



HilfeausderNatur




DieWinterzeitistauchdie ZeitfürwärmendeTees.Die Auswahlistenorm–fürjede Situationgibtesdiepassende Mischung.DieeineversprichtinnereKraft,dieandereschenktJoggernneue FrischenachdemLaufen.Ist diesallesnurMarketing? OderstecktimTeegarheilendeKraft?InteressiertekönnensichaufderHomepage derLandeszentralefürGesundheitsförderungRLPunter www.gesundheitstelefon-rlp. de informieren–auchals Podcast.

WORMS: Ab19.DezemberkönnenBürgerstädtische DienstleistungeninneuenRäumeninderFolzstraßenutzen
„Bürgerrathaus“ eröffnetdemnächst
DerUmzugvonTeilendes städtischenBereichs„ÖffentlicheSicherheitundOrdnung“ vomAdenauerring1indieFolzstraße5gehtmiteinemneuen Nameneinher:AbMontag,dem 19.Dezember,begrüßendie VerwaltungsmitarbeiterdieBürgerschaftimneugeschaffenen „Bürgerrathaus“.
Dannkanndiesediedringend benötigtenstädtischenDienstleistungenwiederimvollen UmfangundinneuenRäumen nutzen.
DasehemaligeVerwaltungsgebäudeimAdenauerring1beheimatetinzwischenkeinestädtischeAbteilungmehr.Fastalle dortansässigenstädtischenMitarbeitersindindieFolztsraße5 umgezogen.Dazugehörendie Abteilungen:„Gewerbe-,Gaststättenrecht/Messenund Märkte“,„Ausländerwesen“, „Straßenverkehrsangelegenheiten“,„Bürgerservicebüro“sowie dasstädtische„Fundbüro“.Nur dieAbteilung„Allgemeines Ordnungsrecht“befindetsich absofortinderPrinz-Carl-Anlage3.Dorthatauchder„Kontroll-undVollzugsdienst“seine Räume.


sindwiedermöglich.ZurVorsprachekönnenBürgernurmit einemTerminkommen.
InderAnfangszeitkannes möglicherweisenochzuEinschränkungenkommen,da nichtalleArbeitsplätzekompletteingerichtetundaufgebaut sind.Kostensteigerungen,LieferengpässeundhoheKrankenständebeiLieferantenund HandwerkernhabendenEinzugbereitsverzögertunddazu geführt,dassderAußen-und BesucherbereichimneuenGebäudenochnichtabschließend gestaltetsind.
Mit Kompetenz und Gefühl stehen wir Ihnen zur Seite • Bestattungen aller Art • Bestattungsvorsorge • Erledigung aller Formalitäten • Auf Wunsch: Frauen in Frauenhände
BESTATTUNG & TRAUERBEGLEITUNG




(0 62 41) 97 32 90




Friedrich-Ebert-Straße 28 · 67549 Worms Tag und Nacht erreichbar · www.bestattungen-best.de
cf.04sa21
Erscheinungstermin
Weihnachtsausgabe,23./24.Dezember2022
Anzeigen-undRedaktionsschluss: Dienstag,20.Dezember2022,17Uhr
Erscheinungstermin Mittwochsausgabe,28.Dezember2022
Anzeigen-undRedaktionsschluss: Freitag,23.Dezember2022,14Uhr
Erscheinungstermin Silvesterausgabe,30./31.Dezember2022
Anzeigen-undRedaktionsschluss: Mittwoch,28.Dezember2022,14Uhr
DieMitarbeiterdieserAbteilungenstehendenBürgernvon nunanwiedervollumfänglich telefonischundperE-Mailzur Verfügung.Termineerhalten dieBürgernachtelefonischer Vereinbarung.Auchdigitale TerminbuchungenfürdieLeistungendesBürgerservicebüros












„ErstePrioritätwarfüruns, dasswirdenAdenauerringvereinbarungsgemäßräumenund schnellwiederleistungsfähig sind.WirwerdenindenkommendenMonatenimRahmen unsererfinanziellenMittelbei deroptischenGestaltungSchritt fürSchrittnacharbeiten“,bittet AngelikaZezyk,Leiterindes Bereichs„ÖffentlicheSicherheit undOrdnung“,umGeduldund Verständnis.DieoffizielleEröffnungdesneuenVerwaltungsgebäudeserfolgt,sobalddierestlichenUmzugs-,Aufbau-und Einrichtungsarbeitenabgeschlossensind.

DiestädtischenMitarbeiter bittenhierfürumVerständnis undfreuensich,dieWormser im„Bürgerrathaus“inderFolzstraße5undindenneuen RäumlichkeiteninderPrinzCarl-Anlage3begrüßenzudürfen.
WORMS: SchließzeitenanWeihnachtenund„zwischenden Jahren“inderStadt
GeänderteÖffnungszeiten
WormserFriedhöfeinklusive Hauptfriedhof„Hochheimer Höhe“: MontagbisSamstagsowiean Sonn-undFeiertagengeöffnet (8UhrbisEinbruchderDunkelheit)
Donnerstag,9–16Uhr Freitag,9–14Uhr

BittebeachtenSiediegeänderten Anzeigen-undRedaktionsschlusstermine Montag,9–18Uhr Dienstag,9–17Uhr Mittwoch,9–15Uhr
BüroderFriedhofsverwaltung imEingangsbereichdesHauptfriedhofes„HochheimerHöhe“: Samstag,24.Dezember,bis Montag,26.Dezember,sowie Samstag,31.Dezember,und Sonntag,1.Januar,geschlossen; Dienstag,27.Dezember,bisFreitag,30.Dezember,(8bis12 Uhr)sowiezusätzlichDonnerstag,28.Dezember,(14bis15.30 Uhr)geöffnet
JüdischesMuseumimRaschiHaus: Samstag,24.Dezember,bis Montag,2.Januar,geschlossen Synagoge: Samstag,24.Dezember,bis Sonntag,1.Januar,geschlossen JüdischerFriedhof„Heiliger Sand“: Samstag,24.Dezember,bis Montag,26.Dezember,sowie Samstag,31.Dezember,und Sonntag,1.Januar,geschlossen Stadtarchiv: Samstag,24.Dezember,bis Montag,2.Januar,geschlossen MuseumderStadtWormsim Andreasstift: Samstag,24.Dezember,und Sonntag,25.Dezember,sowie vonSamstag,31.Dezember,bis Montag,2.Januar,geschlossen; Montag,26.Dezember,bisFreitag,30.Dezember,(11bis17 Uhr)geöffnet
Nibelungenmuseum: Samstag,24.Dezember,und Sonntag,25.Dezember,sowie vonSamstag,31.Dezember,bis Montag,2.Januar,geschlossen;
Montag,26.Dezember,(10bis 18Uhr)sowieDienstag,27.Dezember,bisFreitag,30.Dezember,(10bis17Uhr)geöffnet KunstmuseumimHeylshof: Samstag,24.Dezember,und Sonntag,25.Dezember,sowie vonSamstag,31.Dezember,bis Dienstag,28.Februar,(Winterschließzeit)geschlossen;Montag,26.Dezember,bisFreitag, 30.Dezember,geöffnet Stadtbibliothekundöffentliche Büchereien: Samstag,24.Dezember,bis Montag,26.Dezember,sowie Samstag,31.Dezember,und Sonntag,1.Januar,geschlossen; Dienstag,27.Dezember,bisFreitag,30.Dezember,geöffnet Entsorgungs-undBaubetrieb undBauschuttdeponieWorms Nord:
Samstag,24.Dezember,bis Montag,26.Dezember,sowie Samstag,31.Dezember,und Sonntag,1.Januar,geschlossen; Dienstag,27.Dezember,bis Donnerstag,29.Dezember,(8 bis16Uhr)sowieFreitag,30. Dezember,(8bis15Uhr)geöffnet





Grünabfallkompostanlage: Samstag,24.Dezember,bis Montag,26.Dezember,sowie Samstag,31.Dezember,und Sonntag,1.Januar,geschlossen; Dienstag,27.Dezember,bis Donnerstag,29.Dezember,(8 bis16Uhr)sowieFreitag,30. Dezember,(8bis15Uhr)geöffnet
HausderJugend: Samstag,17.Dezember,bis Sonntag,1.Januar,geschlossen SeniorenbegegnungsstätteKleineWeide: Montag,19.Dezember,bis Dienstag,3.Januar,geschlossen
14 STADTNACHRICHTEN NIBELUNGENKURIER| Samstag,17.Dezember2022 FREUDIGERANLASS
22_50s OHNMOBILPARK AM W EURA MOBIL Ihr Spezialist für Wohnmobile & Wohnwagen Fiat- & Citroën-Service-Werkstatt Neue Modelle 2023 von Eura Mobil & Forster, Reparaturen und Anbauten aller Art (Sat-Anlagen/TV, Solar, Klimaanlagen, Lithium-Batterien etc.) 55234 Biebelnheim/Alzey www.wohnmobilpark-petersberg.com Telefon (0 67 33) 92 11-0 SPENDENKONTO SparkasseWorms-Alzey-Ried IBAN:DE86553500100021706504
JETZT SPENDEN! DankefürdieUnterstützungbeiderSchaltungderAnzeige LieberUgur, zuDeinem 50.Geburtstag gratulierenwirDir vonganzemHerzen. DeineFrauNicole, DeineTöchter SelinundAylin 22_50s Aktuelle Tagesmenüs online! Wir liefern Ihnen unseren Mittagstisch! Bestellung bis 10:30 Uhr unter (06241) 24300 www. METZGEREI-KALTENBORN .de WILHELM-LEUSCHNER-STRASSE 27 67547 WORMS/CITY • NÄHE BAHNHOF Aktuelle Tagesmenüs online! Wir liefern Ihnen unseren Mittagstisch! Bestellung bis 10:30 Uhr unter (06241) 24300 www. METZGEREI-KALTENBORN .de WILHELM-LEUSCHNER-STRASSE 27 67547 WORMS/CITY • NÄHE BAHNHOF Aktuelle Tagesmenüs online! Wir liefern Ihnen unseren Mittagstisch! Bestellung bis 10:30 Uhr unter (06241) 24300 www. METZGEREI-KALTENBORN .de WILHELM-LEUSCHNER-STRASSE 27 67547 WORMS/CITY • NÄHE BAHNHOF 22_50s Dienstag,20.Dezember JägerschnitzelvomSchwein Bratkartoffeln,Salat– €8,60
BIC:MALADE51WOR Förderverein ÖkumenischeHospizhilfeWormse.V. Willi-Bradt-Ring11|67547Worms Telefon06241/911695 info@fv-hospiz-worms.de www.fv-hospiz-worms.de HelfenSieuns, denHospizgedankenweiterzutragen.
WirbittenumfreundlicheBeachtung. UnsereÖffnungszeiten19.–30.Dezember2022
22_50m EsbegrüßenSie
HAARSTUDIOAMBAHNHOF ·PfiffligheimerStr.1 67551Worms-Pfeddersheim·Telefon(06247)900174
WirwünschenallenunserenKundeneingesegnetes WeihnachtsfestundeinengutenRutschinsneueJahr! 22_50s 22_16s
BärbelMetz,NadineHerbundTanjaBottelberger
Öffnungszeiten:Mo.–Fr.,9–18Uhr
Ihnen IHRE LÖSUNG für: individuelle und rentable Photovoltaik-Projekte für Privat und Gewerbe Solardachziegel Windkraft für’s Eigenheim innovative und wirtschaftliche Speichertechnik hochwertige Infrarotheizungen hauseigenes Montageteam Wir freuen uns auf Sie: EIN-STEIN-KOMPETENZZENTRUM
Bedachungen Isolierungen Speyerer Straße 128 – 67547 Worms – Tel. 06241/37 415 SCHILLING GmbH Dachdeckermeisterbetrieb ck44sa16 KANAL-REINIGUNG Bobenheimer Straße 8 67547 Worms 24 Std.-Telefon: (0 62 41) 97 20 11 GUTSCHEINüber20,–EUR 21_52s Is de Abfluss widder zu, hilft de im Nu! einzulösen bis 31.12.2022 Keine Barauszahlungmöglich. EinGutscheinpro Auftrag! vom 19.12.21 bis 8.1.22 machen wir Urlaub. Ab dem 09.01. sind wir wieder für Sie da. WIR WÜNSCHEN IHNEN EIN FROHES WEIHNACHTSFEST UND ALLES GUTE IM NEUEN JAHR! August-Horch-Straße 14 · 67547 Worms (auf dem TÜV-Gelände) Tel./Fax: 0 62 41 / 30 41 96 ❆ ❆ ❆ ❆ ❆ ❆ ❆ ❆ 22_50s
GmbH & Co. KG Grabenstraße 1a, 67578 Gimbsheim www.einstein-kompetenz.de Telefon: 06249 8067520
ÖPNV:


BussestattZügezwischen WormsundBensheim

WiedieDBRegioMitte kurzfristigmitteilt,müssen wegeneinesaktuellüberdurchschnittlichhohenAnteilsanKrankmeldungen amWochenendevomheutigenSamstag,dem17.Dezember,unddemmorgigen Sonntag,dem18.Dezember, alleZügezwischenBensheimundWorms(RB63) entfallen.
MöglichstalleZüge sollenersetztwerden
Derzeitbefindetsichein ErsatzverkehrimAufbau,um möglichstallebetreffenden ZügedurchBusseersetzenzu können.
Reisendewerdengebeten, sichvorFahrtantrittüberdie aktuellenFahrtmöglichkeiten überdieReiseauskunftunter
www.bahn.de oderindenApps DBNavigatorundDBStreckenagentzuinformieren.
AuskunftüberaktuelleEinschränkungenfindenReisendeauchunter www.bahn.de/ aktuell

BitteumVerständnisund entsprechendePlanung
DieDBRegiobittetihre FahrgästefürdieEinschränkungenaufgrundderweiterhinangespanntenLagebeim PersonalumVerständnissowiemehrReisezeiteinzuplanenundzubeachten,dassdie HaltestellendesErsatzverkehrsnichtimmerdirektan denjeweiligenBahnhöfenliegen.
EineFahrradmitnahmein denBussenistamWochenendeleidernichtmöglich.
NeuerRekordwertinRheinland-Pfalz
DiePolizeiRheinland-Pfalz hatmitdemWinter-Versetzungstermineinenneuen HöchststandbeiderZahlder PolizistinnenundPolizistenerreicht.Siezähltaktuell9.685PolizeibeamteundwächstimPersonalkörperweiteran.
„EsisteinneuerRekordwert. SovielePolizistenhatesin Rheinland-Pfalznochniegegeben.Mit9.685Polizeibeamtinnenund-beamtenhabenwireinenneuenHöchststanderreicht undnähernunsder10.000erMarkebeiderPolizeiingroßen Schritten“,soInnenminister MichaelEbling.Auchmitdem nächstenVersetzungsterminim Mai2023werdedierheinlandpfälzischePolizeiweiterwachsen,kündigtederMinisteran.
DieZahlderPolizeibeamten darfinderPolizeinichtisoliert betrachtetwerden,weilPolizistinnenundPolizisteninerheblichemUmfangauchdurchTarifundVerwaltungskräfteentlastet
werden.„VerbrechensbekämpfungundderSchutzvonunsallengelingtnurgemeinsammit denen,diewirnichtinUniform
Freudund Leidinder Familie,

seinenVerwandten undBekanntender engerenundweiteren Umgebungmitzuteilen, isteinalterBrauch.

EineFamilienanzeige im NibelungenKurier erfülltdieseAufgabe.
aufderStraßetreffen.Auchder Gesamtpersonalkörperhatmit 14.070MitarbeiternerneuteinenRekordwertgeknackt“,sag-
teEbling.ZumGesamtpersonalkörperzähltenauchdieAnwärterundAuszubildendenund damitdieZukunftderLandespolizei.
Die9.685Polizeibeamten (sog.Kopfzahl)entsprechen 9.219Vollzeitäquivalenten (VZÄ).DievonderLandesregierungangestrebteZielzahlvon 9.160VZÄwarbereitsimMai 2022überschrittenworden.
EineAbwanderungs-oder KündigungswelleistindenZahlenkeineswegserkennbar.In denvergangenenJahrenwaren imDurchschnittrund30Wechselfällezuverzeichnen,inder RegelauspersönlichenGründenwiederWohnortnäheoder derZusammenführungmitder Familie.AuchdieZahlderEntlassungenaufeigenenWunsch liegtbeidurchschnittlichrund 20proJahr.DieZahlbewegt sichmitBlickaufdie9.685PolizeibeamtenaufäußerstniedrigemNiveau.
Siegfried Grießer

Verstorben am 18. Dezember 2009
Du wirst immer ein Teil von uns sein! In lieber Erinnerung Firma Ronnie Schrinner Sanitär-Heizung-Klimatechnik cf.02mi17
Samstag,17.Dezember2022| NIBELUNGENKURIER NIBELUNGENKURIER 15
Die Trauerfeier mit anschließender Urnenbeisetzung findet am Mittwoch, den 28.12.2022 um 14:00 Uhr auf dem Friedhof Wo rms Hochheimer Höhe statt. Deine Frau Anita In stiller Trauer * 11. August 1941 † 2. Dezember 2022
Hendrich Und ob ich schon wanderte im finstern Tal, fürchte ich kein Unglück; denn du bist bei mir, dein Stecken und dein Stab trösten mich. Deine Kinder, Enkel und Urenkel Psalm 23 Von Beileidsbekundungen bitten wir am Grab abzusehen. Worms, den 17.12.2022 Wir nehmen Abschied von InliebevollerErinnerung FrankBorngässer *8.September1970 †23.Dezember2017 5JahreohneDich. Dufehlst. WirvermissenDich. InLiebe DeineFamilie 22_50s InLiebeundDankbarkeitnehmenwirAbschiedvon meinergeliebtenEhefrau,unsererherzensgutenMutter, SchwiegermutterundfürsorglichenOma InstillerTrauer Klaus HaikeundRainer,RalfundSilke,MartinundMiri, MarkusundCarosowiealleAngehörigen DieUrnenbeisetzungfindetimengstenFamilienkreisstatt. IngeHiller *7.Dezember1939†4.Dezember2022 22_50s 22_50s HansStelzer *29.12.1946†5.11.2022 HerzlichenDank
TRAUERUNDGEDENKEN
Klaus
allen,diesich instillerTrauermitunsverbundenfühlten undihreAnteilnahmeaufsovielfältigeund liebevolleWeisezumAusdruckbrachten. BesondererDankgiltHerrnPfarrerRiedl. ImNamenallerAngehörigen IngridStelzer Westhofen,imDezember2022
Nibelungentee trauert Robert Frödtert * 19.7.40 † 29.11.22
MINISTEREBLING: „Nähernunsden10.000PolizistinnenundPolizistenimLand“
MassiverPersonalmangelamWochenende
Foto:Fotolia.com/Monuta/akz-o Trauerund Gedenken AnzeigenschlussfürTraueranzeigen: Dienstag,12UhrfürdieMittwochsausgabe, Freitag,12UhrfürdieSamstagsausgabe Trauerund Gedenken F ot ixab om 22_50s SchlichtundeinfachwarDeinLeben,treuundfleißigDeineHand. SovieleshastDuunsgegeben,ruhesanftundhabeDank. InLiebeundDankbarkeitnehmenwirAbschiedvon HildeNeugebauer verw.Hendrichgeb.Wendel
InstillerTrauer Karl-Heinz RitaundPeter Uwe Enkel sowiealleAngehörigen Traueranschrift:RitaMeyer,HintermZiegelofen13,67547Worms DieTrauerfeiermitanschließenderUrnenbeisetzungfindetamDonnerstag,
InnnenministerMichaelEbling.Foto:StaatskanzleiRLP/Dinges
*13.Dezember1935†8.Dezember2022
dem22.Dezember2022,um14UhraufdemFriedhofHochheimerHöhestatt.
Unfassbarfürunsalleverstarb unserlieberMitarbeiterundKollege
PaulGolowin
SeinerFamilieundseinenAngehörigen giltunsereAnteilnahmeundunser aufrichtigesMitgefühl
Niederlassungsleitung,Betriebsrat undMitarbeiter/innender FiegeLogistikStiftung&Co.KG ZweigniederlassungIDCWorms Worms,imDezember2022
DANKSAGUNG

DankbardurftenwirinderStunde desAbschiedserfahren, wievielFreundschaft,Zuneigung undAnerkennungunseremlieben Verstorbenen
MichaelChollewig
geb.Scherrer entgegengebrachtwurde.
Wirdankenallen,dieihnaufseinemletztenWegbegleitet habenundinWort,SchriftundGeldspendenihreAnteilnahmezumAusdruckbrachten.
BesondersdankenwirFrauDoktorKohlmannunddem PflegezentrumLange+Gülcher,dieihnwährendseiner Krankheitbegleitethaben.
ImNamenallerAngehörigen GertrudScherrer
DasSchönste,was einMensch hinterlassenkann, isteinLächelnim Gesichtderjenigen, dieanihndenken.
Johann Korb
†8.Dezember2022
Gimbsheim,imDezember2023
22_50s
Gimbsheim, imDezember2022
HerzlichenDank
sagenwirallenfürdie ZeichenderAnteilnahme, Verbundenheitund Freundschaft,diewirnach demTodunseresVaters erfahrendurftenunddie mitunsgemeinsamAbschied nahmen.
Besondersbedankenwiruns beiHerrnPfarrerMarkus Kuhntfürdiebewegenden Worte,demBestattungsinstitutBrandundAnnette Reichfürdiepersönliche undeinfühlsameGestaltung derTrauerfeier.
DeineKinder Anita,ArminundAnja mitFamilien
TrauerundGedenken TrauerundGedenken

BegrenztistdasLeben,dochunendlichdieErinnerung. EsgibtTageundStundenimLeben,diejederdurchstehenmuss.
KarlheinzRenner
†15.11.2022
Ausdruckbrachten. BesonderenDankHerrnPfarrerFaberfürdietrostreichenWorte beiderTrauerfeierundimGottesdienstsowieBlumenund BestattungenSchmittfürdiewürdevolleAusgestaltungderTrauerfeier. GiselaOrtstadt HeikeundBerndBohn Pfiffligheim,imDezember2022
Danke füreinestummeUmarmung,fürtröstendeWortegesprochen odergeschriebenundfürdieBlumenundGabenzurGrabgestaltung.

BesondererDankanPfarrerMettfürseinepersönlichePredigt,dem BestattungsinstitutKreiderundvorallemanHelga,dieimmerfürunsdawar. Hofheim,imDezember2022 SonjaRennerundAngehörige
MansiehtdieSonnelangsamuntergehen underschricktdoch,wennesplötzlichdunkelist.
InLiebeundDankbarkeitnehmenwirAbschiedvon
geb.Gernsheimer *23.September1950†20.November2022

InstillerTrauer Alfred NataschaundDan ThomasundNicole Astrid,Hüseyin,DenizundPauline

DieTrauerfeierfindetamDienstag,dem20.Dezember2022,um14Uhraufdem FriedhofHochheimerHöheinWormsstatt.DieUrnenbeisetzungistzueinem späterenZeitpunktimKreisederFamilie. 22_50s
DieTrauerfeiermitanschließenderUrnenbeisetzungfindetamMittwoch, dem21.Dezember,um11UhraufdemFriedhofHochheimerHöheinWormsstatt.
22_50s
LudwigKerth

*29.Juni1933†2.Dezember2022
InliebevollerErinnerung ImNamenderFamilieundAngehörigen
DieTrauerfeiermitanschließenderUrnenbeisetzungfindetamMittwoch, dem21.Dezember2022,um12UhraufdemFriedhofHochheimerHöhestatt.
SeingroßesundgutesHerzhataufgehörtzuschlagen.
MathiasKelter
*24.April1954†3.Dezember2022
UnsereHerzensindunendlichtraurig. Wasbleibt,sinddankbareErinnerungen, dieniemandnehmenkann.
InLiebeundDankbarkeit DeineEhefrauKatharina DeinSohnUwemitAnja,NiklasundNele sowiealleAngehörigen
DieTrauerfeiermitanschließenderUrnenbeisetzungfindetamMontag, dem19.Dezember2022,um11.30UhraufdemFriedhofinHorchheimstatt. VonBeileidsbekundungenamGrabbittenwirabzusehen.EineKondolenzlisteliegtaus.
16 TRAUERUNDGEDENKEN NIBELUNGENKURIER| Samstag,17.Dezember2022
22_50s
©UweWagschal/www.PIXELIO.de
22_50s
denken. UrsulaFritz
22_50s DANKSAGUNG Karl-HeinzOrtstadt †14.11.2022 HerzlichenDanksagenwirallen,diesichinstillerTrauermituns verbundenfühltenundihreAnteilnahmeaufvielfältigeWeisezum
DasSchönste,waseinMenschhinterlassenkann, isteinLächelnimGesichtderjenigen,dieanihn
geb.Paetsch *1.Februar1934†2.Dezember2022 InLiebeundDankbarkeit TöchterMarianneundKarin EnkelKatja,Kai,KimundMelvin
EdeltraudPartosa
o to :© orne rs on e/ ww w P .de 22_50s
22_50m AlsdieKraftzuEndeging,war´skeinSterben,war´sErlösung. Nachlanger,schwererKrankheitnehmenwirAbschiedvonunseremliebenVater, Schwiegervater,Opa,Uropa,BruderundOnkel
HaraldKerth
InLiebeundDankbarkeitnehmenwirAbschied vonmeinemliebenMann, Vater,Schwiegervater,OpaundUropa.

HelmutJakobZinke




Helga
In stiller Trauer Hans-JürgenNethe Andreasund ChristianeKrebs StephanieKrebs Philip und Alexander Die Trauerfeier mit anschließender Urnenbeisetzung findet am 21 12 2022 um 13 30 Uhr auf dem Friedhof in Worms-Rheindürkheim statt Ein Kondolenzbuch liegt aus Worms-Rheindürkheim,im Dezember2022

DusiehstdenGartennichtmehrgrünen,indemDueinstsofrohgeschafft.
SiehstDeineBlumennichtmehrblühen,weilDirderTodnahmDeineKraft.

WasDuausLiebeunsgegeben,dafüristjederDankzuklein.
WaswiranDirverlorenhaben,daswissennichtnurwirallein.
InLiebenehmenwirAbschiedvonunsererliebenFrau,Schwester,Schwägerin

AngelaTabeni-Frey
DieBestattungfandimengstenFamilienkreisstatt. Worms,imDezember2022

Samstag,17.Dezember2022| NIBELUNGENKURIER TRAUERUNDGEDENKEN 17 22_50s 22_19s|Foto©RainerSturm/pixelio.de DaseinzigWichtigeimLebensindSpurenvonLiebe, diewirhinterlassen,wennwirungefragtweggehen undAbschiednehmenmüssen.
AlbertSchweitzer
*4.August1934†14.Dezember2022
AlbertSchweitzer ot o :© Jen s/ IX L IO. de
InstillerTrauer ChristelZinke ElkeundAlbertDinges StefanundMaliZinke mitFamilie Gundersheim,imDezember2022 DieBeerdigungfindetam22.Dezember2022um14UhraufdemFriedhofinGundersheimstatt.
Wasbleibt,sinddankbareErinnerungen,dieniemandnehmenkann. Reiner SilvanamitUdo
BertholdCebulla †9.November2022
22_50s Ichblickezurückaufeinzufriedenes, glücklichesLebenundDankedem HerrgottundeuchAllen,dennihrhabt
ausKlothildesGedicht
Weißbach geb. Orth * 18 2.1960 †
In Liebe und Dankbarkeit: Dirk Jan und Melanie mit Luisa und Laura Tim und Isabel mit Johanna und Charlotte Max Pit Wilfried Orth und Familie Astrid Furch und Familie Die
2022 um 13 30 Uhr
Blumenspenden
DuwarsteinEngelaufErdenundwirstimmerbeiunssein InLiebeundDankbarkeitnehmenwir Abschiedvonunsererherzensguten, liebevollenMutter,Schwiegermutter, Oma,Uroma,Tante LieselotteTalaska geb.Krause *15.Mai1929†12.Dezember2022 InstillerTrauer Karl-HeinzundJolanta WernerundChristel Klaus-Dieter VolkerundElke Enkel:Mirko,Alexander,Sascha,Jens,Lisa, Laeticia Urenkel:Celina,Leon,Joel,Mila,Mia sowiealleAngehörigen,FreundeundBekannte DieBeisetzungmitanschließenderTrauerfeierfindetamDienstag, dem20.Dezember2022,um13UhraufdemHauptfriedhofHochheimerHöhestatt. 22_50s 22_50s AlsGottsah,dassderWegzulang,derHügelzusteilundderAtemzuschwer wurde,legteerseinenArmumsieundschenkteihrseinenFrieden. WirnehmenAbschiedvonunserergeliebten HeidiKnierim geb.Gertel *7.August1943†27.November2022 InLiebeundDankbarkeit RalfmitMichaela FunnyundOskar
22_19s|Foto©RainerSturm/pixelio.de Eine Stimme die uns vertraut war schweigt Ein Mensch, der immer für uns da war, ist nicht mehr Er fehlt uns Was bleibt, sind dankbare Erinnerungen, die uns niemand nehmen kann
BegrenztistdasLeben, dochunendlichdieErinnerung. Danke Allen,diesichinstillerTrauermituns verbundenfühltenundihreliebevolle AnteilnahmeaufsovielfältigeArt zumAusdruckbrachten,dankenwirvon Herzen. ImNamenallerAngehörigen ChristineCebulla Susanne,StefanundRaphael
mirdasgegeben.
Klothilde
12.12.2022
Trauerfeier findet am Dienstag, 20 Dezember
, auf dem Friedhof in Mettenheim statt. Von Kranz- und
sowie Beileidsbekundungen bitten wir Abstand zu nehmen. Eine Kondolenzliste liegt aus. Die Urnenbeisetzung erfolgt zu einem späteren Zeitpunkt im engsten Familienkreis.
DieUrnenbeisetzungfindetamMittwoch,dem21.Dezember2022,um13Uhrauf demFriedhofHochheimerHöhestatt. (TreffpunktEingangDr.-Carl-Sonnenschein-Straße,nichtanderKapelle)
In Liebe und Dankbarkeit nehmen wir Abschied von meiner Frau, unserer Mutter, Schwiegermutterund Oma
Nethe geb. Klein * 25. Dezember1936 † 28. November2022
Samstag,17.Dezember
FürdieSanierungder Bergkirche
AmSamstag,dem17.Dezember,um17Uhr,gibtder Chor„JazzAffair"einweihnachtlichesBenefizkonzertin derBergkircheimStadtteil Hochheim.DerEintrittistfrei, umeineSpendewirdgebeten.
Konzertder Versöhnungsgemeinde
DieEvangelischeVersöhnungsgemeindeWorms-NeuhausenlädteinzuMusikam 17.Dezember,um18Uhr,in dieEv.KircheinderStiftstraße.DerEintrittistfrei;Spende erbeten.
MitneuemProgramm


MathiasRichlingistam17. Dezember,um20Uhr,zuGast imWORMSER.Kartengibtes beimTicketServiceWormssowiebeiallenbekanntenTicketRegional-Vorverkaufsstellen. DerEintrittspreisbeträgtzwischen29Euro(anderAbendkasse31Euro).DiesistderErsatzterminfürdieam11.Dezember2020pandemiebedingt entfalleneVeranstaltung.
Sonntag,18.Dezember
EinstimmenaufWeihnachten inKriegsheim DieAbteilungGesangTG Kriegsheime.V.lädtrechtherzlicheinzumvorweihnachtlichenKonzertam18.Dezember um17Uhrindieevangelische KircheKriegsheim.DerEintritt istfrei;Spendenerbeten.
„OHeilandreißdieHimmel auf“

DerKirchenchorSt.Cäcilia RoxheimlädtamviertenAdventssonntag,dem18.Dezember,um17Uhr,zumvorweihnachtlichenKonzertindieKath. PfarrkircheSt.MariaMagdalenainRoxheimein.DerEintritt istfrei,umeineSpendewird gebeten.
Dienstag,20.Dezember
KinderbildersollenAusflug ermöglichen ImRahmeneinesKunstprojektsmitgeflüchtetenKindern ausderUkrainesindzahlreiche Bilderentstanden,dieamDienstag,dem20.Dezember,aufdem WormserWeihnachtsmarkterworbenwerdenkönnen.HöhepunktderVeranstaltungwird eineVersteigerungsein,die vom‚WormserOriginal‘undInhaberderhiesigenKunsthandlungHelmutSteuerdurchgeführtwird.Losgehtesum18 UhramGlühweinstandvom „KlooseHelmut“amRömischenKaiser.DerErlöswirdfür einenbesonderenAusflugmit denKindernverwendet.
EinSommernachtstraum Am20.DezemberwirdWilliamShakespearesKomödie „Sommernachtstraum“um20 UhrimWormserTheateraufgeführt.ZudieserAufführung wirdum19.15UhrimOberen Theaterfoyereinekostenlose EinführungzumStückangeboten!Eintrittskartengibtesu.a. beimNibelungenKurierinder Prinz-Carl-Anlage20sowiebei

DASWORMSER: Herrlich-leichterTheaterspaß am28.Dezemberum20Uhr
DieFeuerzangenbowle
EineSchnapsidee:DiegutealteZeitsollauferstehen,undmanholtdas Versäumtenach.Foto:Baraniak
DasAltonaerTheaterHamburgpräsentiertamMittwoch,dem28.Dezember,um 20Uhr„DieFeuerzangenbowle“–eineKomödienach demRomanvonHeinrich SpoerlimWORMSER.„Das SchönsteimLeben“,resümiertdieHerrenrundeum denjungenSchriftstellerDr. Pfeiffer„wardieGymnasiastenzeit“.DochPfeifferhatte Privatunterricht,warnieauf demPennal,kenntweder PaukernochdieStreiche,die manihnenspielt,ist„überhauptkeinMensch,sozusagen“.EineSchnapsidee:Die gutealteZeitsollauferstehen, undmanholtdasVersäumte nach.
Als„Pfeiffermitdreif“wird erinderOberprimavon Babenberg„Schöler“vonPro-

allenweiterenTicket-regionalVorverkaufsstellen.DerEintrittspreisbeträgtzwischen17 und26Euro(anderAbendkasse jeweils2Eurohöher).
Freitag,23.Dezember
Indulcijubilo
Am23.Dezemberfindetum18 UhrinderkatholischenKirche St.MauritiusinGimbsheimwiedereinKonzertmitAdvents-und Weihnachtsliedernstatt.
Samstag,24.Dezember
„WirwartenaufsChristkind“ ImGemeindesaalnebender evangelischenBergkirchein Worms-Hochheimverkürztam 24.Dezembervon13.30bis15
UhreinVor-Bescherungs-ProgrammdieWartezeit.AnmeldungoderRückfragensind möglichunter kirsten.zeiser@ gmx.de
Montag,26.Dezember
WerkeAlterMeistererklingen
AmzweitenWeihnachtstag, dem26.Dezember,ladendas evangelischeStadtkantoratund dieEvangelischeLuthergemeindeWormszueinemdreimalaufgeführtenweihnachtlichenKonzertindieLutherkirche,Karlsplatz5,67549Worms,ein.SowohlzurGottesdienstzeitum10 UhralsauchinzweiWiederholungskonzertenamNachmittag um15sowieum18UhrerklingenweihnachtlicheWerkeAlter Meister.DerEintrittistfrei,es wirdumeineKollektegebeten.
Mittwoch,28.Dezember
„DieFeuerzangenbowle" Herrlich-leichterTheaterspaß am28.Dezember,um20Uhr,im WORMSER.Eintrittskartenfür diesenherrlich-leichtenTheater-
fessorCrey,lerntbeimBömmel,wasesmitder„Dampfmaschin'“aufsichhatund ersinntmitseinenpubertierendenSchulkameradenUnfugallerArt,umdenLehrkörperzufoppen.
Dochbaldhegterauch ernstereAbsichten,dennfür diereizendeTochterdesgestrengenHerrnDirektorsentflammeninihmrechterwachseneGefühle…EintrittskartenfürdiesenherrlichleichtenTheaterspaßgibtes u.a.beimNibelungenKurier, Prinz-Carl-Anlage20,67547 Worms,sowiebeiallenbekanntenTicket-Regional-Vorverkaufsstellen,auchbeimTicketServiceWorms.DerEintrittspreisbeträgtzwischen20 und29Euro(anderAbendkassejeweils2Eurohöher).
spaßgibtesu.a.beimNibelungenKurier,Prinz-Carl-Anlage20, 67547Worms,sowiebeiallenbekanntenTicket-Regional-Vorverkaufsstellen.Eintrittskartengibt esauchbeimTicketService Worms.DerEintrittspreisbeträgt zwischen20und29Euro(ander Abendkassejeweils2Eurohöher).
Freitag,30.Dezember PaganiniundPolka Am30.Dezemberfindetum20 UhrimWormserTheaterdasSilvesterkonzertmitderDeutschen StaatsphilharmonieRheinlandPfalzstatt.Eintrittskartengibtes imVorverkaufu.a.beimNibelungenKurier,Prinz-Carl-Anlage 20,sowiebeiallenweiterenTicket-regional-VVK-Stellen.Der Eintrittspreisbeträgtzwischen27 und36Euro(anderAbendkasse jeweils2Eurohöher).
Shows·Schauspiel·Musikevents·Theater MathiasRichling#2022/23 DASWORMSER.................................... Sa.,17.12.2022
EinSommernachtstraum–KomödievonWilliamShakespeare DASWORMSER..................................... Di.,20.12.2022
DieFeuerzangenbowleKomödie nachHeinrichSpoerl DASWORMSER.................................... Mi.,28.12.2022
Silvesterkonzert–DeutscheStaatsphilharmonie Rheinland-Pfalz DASWORMSER..................................... Fr.,30.12.2022
The12Tenors:Powerof12 DASWORMSER.................................... Mi.,04.01.2023
AngelikaMilsterWinterMomente WORMSDREIFALTIGKEITSKIRCHE.. Do.,05.01.2022
SWR3LiveLyrix–mitLizBaffoe: Staffel2020 DASWORMSER..................................... Di.,07.02.2023

WinterRevueWorms DASWORMSER............................. bisSo.,08.01.2023
LEO-EineShowjenseitsderSchwerkraft DASWORMSER.................................... Fr..,13.01.2023
DieJoeCockerStory DASWORMSER.................................... Sa.,14.01.2023
JENSWAWRCZECKliest–DieVögel LINCOLN................................................ So.,15.01.2023
DieReisederVerlorenen–SchauspielvonDaniel Kehlmann DASWORMSER..................................... Di., 17.01.2023
Hexenjagd(TheCrucible)–Schauspielvon ArthurMiller DASWORMSER................................... Do.,19.01.2023
DieMagier-DieFreakshowTour DASWORMSER..................................... Fr.,20.01.2023
DiegroßeRobert-Stolz-Gala DASWORMSER.................................... So.,22.01.2023
DerKleinePrinz–DasMusical DASWORMSER................................... Do.,26.01.2023
Once–MusicalnachdemFilmv.JohnCarney DASWORMSER................................... Do.,26.01.2023 SöhneMannheims–Piano–live

DASWORMSER..................................... Fr.,27.01.2023
AlteSorten–ChawwerruschTheater LINCOLN................................................ So.,05.02.2023

MarenKroymann&Band–InmySixties DASWORMSER.................................... So.,05.02.2023
TAO–TheLight–DieJapanischeTrommel-Sensation DASWORMSER................................... Do.,12.02.2023

Fastnachtsamstag EWR-KESSELHAUS............................... Sa.,18.02.2023
OneNightwithABBA–NobleComposition DASWORMSER.................................... Sa.,18.02.2023
DeutscheStaatsphilharmonieRheinland-Pfalz DASWORMSER.................................... Sa.,25.02.2023
SixxPaxx:AnfassbarTour2022/2023 DASWORMSER..................................... Di.,28.02.2023
Kinder DerKleinePrinz–DasMusical vonDeborahSasson&JochenSautter DASWORMSER.................................... Mi.,25.01.2023
ZwergNase–MärchenmusicalnachWilhelmHauff DASWORMSER..................................... Fr.,10.02.2023
Kabarett,Comedy,Kleinkunst MathiasRichling:DasneueProgramm DASWORMSER.................................... Sa.,17.12.2022
DuoMimikry:TastyBiscuits LINCOLN................................................. Fr.,06.01.2023
SarahHakenberg–Wiederda! LINCOLN................................................ Sa.,07.01.2023
AndreasWeber–Femannismus LINCOLN................................................ Sa.,28.01.2023
BarbaraRuscher–MutteristdieBestie LINCOLN............................................... Do.,02.02.2023
DerGottdesGemetzels–Komödie vonYasminaReza DASWORMSER.................................... Sa.,11.02.2023

ChristineEixenberger:Einbildungsfreiheit LINCOLN................................................ So.,05.03.2023

18 TERMINKALENDER NIBELUNGENKURIER| Samstag,17.Dezember2022 Claire Huangci Foto: M. Zahora Lucie Leguay / Foto: Agentur INFOS UND KARTEN TELEFON (06241) 2000-450 WWW.DAS-WORMSER.DE MI 28.12. / 20.00 UHR DIE FEUERZANGENBOWLE Komödie nach dem Roman von Heinrich Spoerl FR 30.12. / 20.00 UHR SILVESTERKONZERT PAGANINI UND POLKA Deutsche Staatsphilharmonie Rheinland-Pfalz Leitung: Lucie Leguay Solistin: Claire Huangci, Klavier Mit Werken von Brahms, Rachmaninow, Lehár, J. Strauß II und Lanner RZ01 DW.2179 Anzeige Veranstaltungen — NK 94x150.indd 1 13.12.22 12:36 5€ Gutschein auf allen Plätzen, gültig für 1 Person in den 15:00 Uhr Vorstellungen außer an Familientagen. Diese Karte bitte an der Circuskasse einlösen. Worms Festplatz vom 22.12.2022 bis 08.01.2023 www.circus-cristallo.de Ticket-Hotline: 0176 32307374 Ab 01.12.2022 ist die Circuskasse von 12:00 bis 19:00 Uhr geöffnet. ✂ Prinz-Carl-Anlage20·67547Worms Tel.(06241)9578-0 NibelungenKurier TICKETSHOP AlleKartenkönnenSiebequemauchonlineüberunserenTicketshopkaufen: www.nibelungen-kurier.de BittebeachtenSie,dasseineReservierungvonTicketsNICHTMÖGLICHist.
bis8.Januar2023 Ticketsunteranderembeim NibelungenKurieroderunter
ZweiJahrelangmusstedas traditionelleSchauturnendes TVHorchheimpandemiebedingtausfallen.IndiesemJahr konntedergrößteVereindesOrtesendlichwiederseineLeistungeninsportlicherHinsichtpräsentieren.KulisseamvergangenenSonntagwardiesesMalder „ZirkusPurzelbaum“.

AlsZirkusdirektorinnenfungiertenAnnikaFreyundKlara Holl.Diebeidenkonntenneben EhrenpräsidentGeorgMink, StadtentwicklungsdezernentTimoHorstundderOrtsspitze auchdenEhrenpräsidentendes SportbundesRheinhessen,HerbertW.Hofmannbegrüßen. DannwurdeesZeitfürdieAkteure.
Affen,Robben,Zirkuspferde, GroßkatzenundTierbabysbevölkertendieManege.DieÄffchen vollführtenihrenTanz,während dieRobbenmitWeltkugelnauf
dieProblematik'SauberesWasser'hinwiesen.Aberauchwas sonstnochzueinerZirkusvorstellunggehört,wargeboten. ZaubererundClownswaren ebensovertretenwieJumper,die eineRiesenseifenblaseproduziertenundsogarBlümchenan dieZuschauerverteilten.Warum
diegelenkigenTrampolinkünstlerjeweilsnureineRingelsocke trugen,darüberrätseltensogar dieModeratorinnen.
DiePowerfrauendesVereins bildetendensportlichenundviel umjubeltenAbschluss.

UnddannwardanochdieSachemitdemverschwundenen Hasen.DerwareinemZauberer ausdemHutentwischtund währendderganzenVorstellung verschwunden.AllesSuchen undLockenseitensderPräsentatorinnennutztenichts.Erstdem Nikolaus,deramEndeerschien, umdieKinderzubeschenken, gelanges,dasHäsleinwieder hervorzulocken.
GroßesLobginganallebeteiligtenKinderundderen Übungsleiterfürdiesefastschon professionellenDarbietungen. EngagementundZusammenhaltgehörenbeimTurnvereinin Horchheimfast schonzumMarkenkern.


TrainerBjörnDingerhatteim letztenHeimspielderTGOsthofeninderRheinhessenliga einpaarPersonalprobleme.EinigeSpielerinnenmusstenwegenVerletzungoderKrankheit passen.Aushelfendurftendrei Spielerinnenausderzweiten Mannschaft,diekurzdavorihre Partiebestrittenhaben.Diese fügtensichnahtlosindasSpielgeschehenmiteinundwaren beim27:22Heimsieggegendie SFBudenheimIIImehralsnur beteiligt.
BeimStartindieBegegnung hattendieTGOihreProbleme mitdenGästen,diebesserindie Partiehineinfanden.Biszum 6:6wardiePartiemehralsausgeglichen.DieTGOarbeitete
Medizin

sichindasSpielhinein,gehen mit7:6inFührung,diesiebis zumSchlussnichtmehrhergaben.
NacheinemFünf-Tore-Lauf standesnacheinerViertelstundeSpielzeit11:6fürdieTGO.Bis zurPausewurdeein16:12herausgespielt.SehrzurZufriedenheitvonTrainerDinger:„Erfreulichwar,dasswirheutewesentlichwenigertechnischeFehler imSpielhatten.“

GleichzuBeginnderzweiten HälftekonntendieGästedas ErgebnisaufdreiToreverkürzen.NäherkamendieBudenheimerinnenabernichtmehr.Es entwickeltesicheinePartieauf Augenhöhe.Diesspiegeltesich amResultatnieder.Diezweite
Hälftegehtmit11:10andieTGO. DieTGOMädelshattenversäumt,imAngriffdasSpiel deutlicherzugestalten.DieAbwehrundbeideTorhüterinnen agiertenüberweiteStreckenauf einemgutenNiveauundsehr konsequent.SokonntendieGästeunterihrenimDurchschnitt erzielten27Trefferngehalten werden.TrainerDinger:„ImAngriffhättenwirvielzielstrebiger seinmüssenundkönnen.
DieswerdenwirindennächstenEinheitenversuchenzuverbessern,umdennächstenweiterenSchrittnachvornezumachen“.DasletzteSpielvorWeihnachtenfindetam18.Dezember um14UhrbeiderSGSaulheim statt.
ARTHROSE natürlich und






Essenzielle Mikro-Nährstoffe für Herz und Gefäße
Erhöhte Cholesterinwerte sind der Hauptauslöser für Bluthochdruck. Der Grund: Verstopft Cholesterin die Gefäße, muss das Herz stärker pumpen, damit alle Organe ausreichend versorgt werden. Die gute Nachricht: Forscher haben einen natürlichen CholesterinSenker namens Beta-Glucan identifiziert, der nachweislich den Cholesteringehalt im Blut reduziert! Dieser ist in einem besonderen Mikro-NährstoffDrink enthalten: Mindalin Komplex 26 (Apotheke). Zudem enthält der Drink weitere ausgewählte Inhaltsstoffe für Herz und Gefäße, z. B. Vitamin C, das zu einer normalen Kollagenbildung für eine normale Funktion der Blutgefäße und Vitamin B1, das zu einer normalen Herzfunktion beiträgt. Unsere Experten empfehlen täglich ein Glas Mindalin Komplex 26.


wirksam behandeln
Ein spezielles Arzneimittel namens Rubaxx Arthro bekämpft Gelenkverschleiß (Arthrose) mit der Kra einer besonderen Arthrose-P anze.
Unsere Lebenserwartung steigt, wir werden immer älter – einerseits gute Nachrichten. Doch für unsere Gelenke bedeutet diese Entwicklung jahrelange zusätzliche Belastung. Spätestens ab Ende 50 treten bei fast allen Deutschen Verschleißerscheinungen in den Gelenken auf. Unbehandelt kann die Abnutzung der Gelenkknorpel ungebremst voranschreiten und Entzündungen zur Folge haben. Dies führt meist zu dauerha en Schmerzen und eingeschränkter Beweglichkeit.
Die Kniearthrose
Schmerzlindernd und entzündungshemmend Der Wirkstoff, der in Rubaxx Arthro hochkonzentriert enthalten ist, wird aus der Weißbeerigen Mistel gewonnen. Diese ist überwiegend in Südskandinavien beheimatet und gilt als wahre „Arthrose- Pflanze“. Denn ihr Wirkstoff hat nicht nur eine schmerzlindernde, sondern auch eine entzündungshemmende Wirkung.

*Beta- Glucane tragen zur Aufrechterhaltung eines normalen Cholesterinspiegels im Blut bei. Beta- Glucan aus Hafer reduziert nachweislich den Cholesteringehalt im Blut. Ein hoher Cholesterinwert gehört zu den Risikofaktoren für die koronare Herzerkrankung. Die koronare Herzerkrankung ist durch mehrere Risikofaktoren bedingt; die Veränderung eines Risikofaktors kann eine positive Wirkung haben oder auch nicht. Die positive Wirkung stellt sich bei einer täglichen Aufnahme von 3 g ein. • **Mindalin Komplex 26 enthält pro Portion 1 g Beta- Glucane aus Hafer.


Hochkonzentrierter Wirksto für die Gelenke Deutsche Forscher haben die Weißbeerige Mistel,
eine besondere ArthrosePflanze, hochkonzentriert in Rubaxx Arthro au ereitet. Ihr Arznei sto bekämp speziell Arthrose und wirkt dabei schmerz lindernd und entzündungshemmend. Mehr noch: Der Wirkstoff kann laut In-vitro- Studien sogar bestimmte Körperzellen stoppen, die den Gelenkknorpel bei Arthrose angreifen.1 Somit wird der Knorpel geschützt und die bei Arthrose typischen
Anlauf- und Belastungsschmerzen werden bekämp .
Rubaxx Arthro ist gut verträglich: Nebenwirkungen oder Wechselwirkungen mit anderen Arzneimitteln sind nicht bekannt. Dank der Tropfenform ist Rubaxx Arthro je nach Stärke der Beschwerden individuell dosierbar.
Fazit: Mit Rubaxx Arthro kann Gelenkverschleiß wirksam
Experten raten daher, schon bei ersten Anzeichen einer Arthrose aktiv zu werden. Ihre Empfehlung: Eine wirksame Therapie sollte speziell bei Arthrose helfen und dabei nicht nur schmerzlindernd und entzündungshemmend wirken, sondern vor allem den Knorpel schützen. Hier setzt das rezeptfreie Arzneimittel Rubaxx Arthro (Apotheke) an! 1Lavastre et al. (2004) Anti- inflammatory effect of Viscum album. Clin Exp Immunol. 2004 Aug; 137(2):272- 8 • *Bei Verschleißkrankheiten der Gelenke; Absatz nach Packungen, Quelle: Insight Health, MAT 03/22 • Abbildung Betroffenen nachempfunden RUBAXX ARTHRO. Wirkstoff: Viscum album Ø. Homöopathisches Arzneimittel bei Verschleißkrankheiten der Gelenke. www.rubaxx.de • Zu Risiken und Nebenwirkungen lesen Sie die Packungsbeilage und fragen Sie Ihren Arzt

behandelt und die Beweglichkeit so wieder verbessert werden. Überzeugen auch Sie sich von den Nr. 1* Arzneitropfen bei Arthrose: Rubaxx Arthro, rezeptfrei in jeder Apotheke erhältlich!



Samstag,17.Dezember2022| NIBELUNGENKURIER LOKAL-SPORT 19
oder Apotheker. • PharmaSGP GmbH, 82166 Gräfelfing
ist die häufigste Form Die Hüfte ist nach dem Knie das am meisten von Arthrose betroffene Gelenk
Ebenfalls weit verbreitet ist Arthrose in den Finger- und Handgelenken
www.rubaxx.de
Für Ihre Apotheke: Rubaxx Arthro (PZN 15617516)
www.mindalin.de ANZEIGE
Für Ihre Apotheke: Mindalin Komplex 26 (PZN 13169019)
221130_HP1235_L_TZWOB-F03_V003_kh.indd 1 30.11.22 14:37
TVHORCHHEIM: EndlichkonntedastraditionelleSchauturnenwiederstattfinden FastschonprofessionelleDarbietungen ZirkusPurzelbaumbegeistertZuschauer HANDBALL: KlarerErfolgimletztenHeimspiel2022
DieClownsbrachtenvielSpaßundStimmungindieHalle. ÜberdielinkeAußenpositionwarEmmaZimmermannmitdreiTorenamHeimsiegbeteiligt.Foto:FelixDiehl DerSprungdurchdenFeuerreifendurftenichtfehlen.Fotos:FelixDiehl WeitereBilderin derOnline-Galerie www.nibelungen-kurier.de
TGODamenbleibenimRennen
DienachCoronaerstmalswiederdurchgeführteSVHorchheim-Veranstaltungfandsehr großenZuspruchundderSVHHofwargutgefüllt.
ImVorfeldwurdeneinige WeihnachtshüttenundStände imHofdesSVHorchheimaufgebautundmitvielLiebeweihnachtlichgeschmückt.Die SVH-Aktiven-MannschaftenorganisiertendieStände.Esgab nebenverschiedenenSortenvon Winzer-GlühweinenauchoriginalWinzerKinderpunschund einigeKaltgetränke.DasGetränkeangebotwurdeanderBarmit weiterenheißenCocktailsergänzt.
Bratwürste,Pommes,hausgemachteGulaschsuppesowie
Waffeln,KuchenundCrêpes fandensehrschnellihreAbnahme.
EinegroßeFeuerschalewurde fürdasZubereitendesStockbrotesgenutzt.HierhattendievielenKinderdesSVHgroßen SpaßundFreude.Zusätzlich konntendiejungenSVH-Kicker dasSoccer-Spielfeldundden KunstrasenplatzfüretlicheSpielenutzen.
FürweitereUnterhaltung sorgtemittollerLivemusikTom Bola.DieAnwesendenverweiltenbisindiefrühenMorgenstundenbeimSVH.
DerVorstandbedanktsichmit einemgroßenDankebeiallen Helfenden,Spendendenund Unterstützenden.
MinisterpräsidentinMalu DreyerhatsechsaktiveSpitzensportlerinnenund-sportlersowievierehrenamtlichEngagierte mitderSportplaketteausgezeichnet.EsistdiehöchsteAuszeichnungdesLandesRheinland-PfalzfürdenSport.DarunteristauchManfredPfeiffer,der SportkreisvorsitzendedesSportkreisesWormsimSportbund Rheinhessen.Pfeiffer,derbereitsTrägerdergoldenenEhrennadeldesSportbundesRheinhessenist,wurdeimFestsaalder MainzerStaatskanzleinun durchdieMinisterpräsidentin persönlicham13.Dezember ausgezeichnet.
„Sportistfüralleda.IntegrationundInklusionwerdenganz praktischgelebt.DieSportplakettestehtnichtnurfürdieEhrungderBesten.InersterLinie drücktsiedenDankunddieAnerkennungandiejenigenaus, diesichumdenSport,umunser LandunddamitumdieMenschenverdientgemachthaben“, soMaluDreyeranlässlichder Verleihung.

ManfredPfeifferistbereitsseit 1996undsomitseitüber25Jah-

reninverschiedenenehrenamtlichenPositionendesrheinhessischenSportstätig.Als2.und 1.Vorsitzenderdes1.Wormser SchwimmclubsPoseidonwirkte erindenJahren2000bis2017.
Vereinsehrenamtwurdeund wirddabeistetsvomEhrenamt imSportkreisundim Schwimm-sowieStadtsportver-
bandbegleitet.DerSportkreis Wormswirdseit2018vonihm geführt,alsstellvertretender Sportkreisvorsitzenderagierteer bereitsvon2014bis2018.Teildes HauptausschussesistPfeiffer ebenfallsbereitsseit2014.
DieGeschickedesWormser Stadtsportverbandesleiteterdarüberhinausseitmehralsdrei
JahrenalsstellvertretenderVorsitzender.„WirbeglückwünschenManfredPfeifferzurerhaltenenSportplakette.Erhat sichinübereinemVierteljahrhundertumdenrheinhessischenSportverdientgemacht undübtweiterhinvieleEhrenämteraus.MitdieserAuszeichnungerhälterdiewohlverdiente AnerkennungfürseinaußerordentlichesEngagement“,so SportbundRheinhessenPräsidentKlausKuhnundGeschäftsführerThorstenRichterunisono,diebeidedenPreisträgervor Ortbereitsbeglückwünschthaben.„Zunächstwarichüberrascht,alsichdasSchreibender Staatskanzleibekam.Alsiches danndurchgelesenhatte,war ichstolzundhabegleichzeitig andievielenEhrenamtlichenin meinemSportkreisundmeinem Heimatvereingedacht.
OhneihrMitwirkenhätteich dasnichterreicht.Deshalbgebe ichdieEhrunggerneanalleEhrenamtlichenweiter,diemich überdieselangeZeitimSportbund,SportkreisundVereinbegleitethaben“,soderglückliche PreisträgerManfredPfeiffer.
Am10.Dezembertrafendie Basketball-Herrender2.TGWMannschaftaufdieTSGHeidesheim3.FürdasSpielinderA2KlassesinddieWormserhierbei miteiner8-köpfigenDelegation nachHeidesheimgefahren.Das ZielsollteeinSiegsein,umdie HinrundemiteinemgutenGefühlzubeendenundindie wohlverdienteWinterpausezu gehen.
so,möglichstschnellunterden gegnerischenKorbzukommen, umdanndiegroßenTGW-SpielermithohenPässenzubedienenundeinfachKörbezuerzielen.
dieWormserVerteidigungarbeitete.DieTGW-Herrenhielten dieHeidesheim-Hurricanes fernvomKorbundkonntendie FehlwürfederGegneramBrett abstauben
AmSonntagfanddieSportlerehrungdesADACMittelrhein inderKulturhalleinOchtendungstatt.
Ineinemüberdreistündigen Programmwurdenüber160 SportlerfürihreErfolgerund umdenMotorsportgeehrt.

IndieEhrungslistedesMSC AlzeybelegteMaxWeberaus WormsdenzweitenPlatzim WagensportderDMSB-SlalomMeisterschaft.Ebenfallseinen zweitenPlatzbelegteMoritzFischerausEichundzwarinder Deutschen-Meisterschaftim Kart-RennsportderWAKC2022 KlasseX30Junior.InderLan-
desmeisterschaftRheinlandPfalz2022desMVRPbelegte MarekBöckmannausLautersheimimAutomobilsporteinen hervorragendenviertenPlatzbei 74Teilnehmern.InderClubwertungerhieltSportleiterKaiBucherdenPokalfürdenfünften Platzvoninsgesamt14Vereinen.WeitergingesmitderVerleihungderEwald-Kroth-Medaille.Fürüber30JahreununterbrocheneSportwarttätigkeit inverantwortlicherPositionbei Motorsportveranstaltungendes ADACMittelrheine.V.erhielt GernotGräfausAlzeydiehöchsteAuszeichnung.
DievermeintlicheSchwäche desGegnerswarvomWormser Trainerschnellausgemacht:Die WormserHerrenhatteneinen Größenvorteil.DieVorgabevon CoachSebastianCaesarwaral-
DieseVorgabegingvonBeginnanauf.Bereitsnachden ersten10Minutenstandes23:7 fürdieWormserHerren.Im nächstenViertelkonntederVorsprungweiterausgebautwerdenunddieErgebnistafelstand zurHalbzeitpausebei44:13.
DieErgebnissezeigennicht nur,dassdieoffensiveTaktik aufging,sondernbeweistauch eindrucksvoll,wiediszipliniert
Unberechenbarfürdie gegnerischeMannschaft
TopscorerbeidenWormser HerrenwarNiklasWenderholm, dermitseinenschnellenFastbreaksundseinensouveränen3Punkt-Würfenunberechenbar fürdiegegnerischeMannschaft war.Außerdemfreutensichdie WormserüberdieRückkehrvon

MarcBorlinghaus,derseineaktiveBasketballkarrierewiederauflebenließunddiezweitenTGWHerrenmitseinemunaufgeregtenunderfahrenenSpielaufbau zumSiegdirigierte.ZusammenfassendistaberdiegesamteLeistungderMannschafthervorzuheben:StarkeDefensivleistung, Vorteilegutausgespieltund7 von8SpielernmitPunktenauf demScoreboard.
AmEndegehendieTGWler miteinemkomfortablen81:35AuswärtssiegindieWinterpause. MotiviertinderRückrundedort anzuknüpfen,wosieinihrem letztenSpielaufgehörthaben.

DieHockeyherrenunterliegendemSC80FrankfurtII denkbarknappmit6:5undbeendendasJahrpunktlosauf demletztenPlatz.

ErneutmusstendieWormser aufgrundderGrippewellemit JohannesSteuer,JanisHeyne undPascalKrämeraufdrei Stammspielerverzichten.Trotz allemerwischtendieWormser denbesserenStartundwaren denGästenausFrankfurtim erstenViertelklarüberlegen. NachetwazehnMinutenbrachteChristianDeckerdieTGWler mit1:0inFührungundnur wenigeMinutenspätererhöhte ThorbenFreyperStrafeckeauf 2:0.
DerBallliefgutindeneigenenReihenunddieWormser dominiertenbisdahindiePartie.ImzweitenViertelkamen dieGästenunbesserinsSpiel undbereitetendenWormsern zunehmendProbleme.Immer wiederfandendieFrankfurter einenWegdurchdieWormser Abwehr,sodasssiedenRückstandbiszurHalbzeitpausein eine4:2-Führungdrehenkonnten.ImdrittenViertelstellten dieTGWlernunaufeineManndeckungumundsetztenden GegnerfrühunterDruck.Die Taktikgingzunächstauf,Fabian BentzerzielteperStrafeckeden
Anschlusstrefferzum3:4.Die Wormserdrücktenweiter, musstenallerdingsdurcheinen schnellenKonterderGästedas 3:5inKaufnehmen.
KurzvorEndedesdritten ViertelsverkürzteChristianDeckererneutperStrafeckezum 4:5.
ImletztenundentscheidendenViertelversuchtendie WormserdiePartienunnochzu ihrenGunstenzuentscheiden. Dochwiederwareneszunächst dieFrankfurter,diemiteinem SolounddemTrefferzum4:6 diezweiToreFührungwieder
herstellenkonnten.ErneutkamendieTGWlerdurcheinen TreffervonFabianBentzauf5:6 heran.
WenigeMinutenvorEnde nahmendieWormserdannden TorhütervomPlatzundbrachteneinenzusätzlichenFeldspieler.EtwadreißigSekundenvor AbpfifferspieltensichdieGastgebernocheinmaleineStrafeckeundsomitdieletzteAktion derPartie.
ZunächstwurdeeinSchuss vonThorbenFreyregelwidrig abgewehrt,waszueinerWiederholungseckeführte.
DiezweiteEckewurdenun miteinerVarianteperfektausgeführt,sodassTobiasKrafczyckfreizumSchusskam.
DenindiesemMomentsichergeglaubtenPunktgewinn machteallerdingseinFrankfurterSpieleraufderTorliniestehendzunichte,indemerden hartenundplatziertenSchuss mitseinemSchlägerabwehren konnte.
GanzbitterfürdieWormser, dieessomitauchnachdem viertenSpielnichtschaffen,die erstenwichtigenPunkteeinzufahren.
20 LOKAL-SPORT NIBELUNGENKURIER| Samstag,17.Dezember2022 Wir haben Batterien für jedes Fahrzeug! - Sehr lange Lebensdauer - Erstausrüster-Qualität - Extrem leistungsfähig - Absolut wartungsfrei - Neueste Technik - Hohe Startkraft Professioneller Partner für Autoteile und Autozubehör 67547 Worms /Cornelius - Heyl -Str. 54/ Tel. 06241-91100 67227Frankenthal/Schraderstraße 36/ Tel. 06233-44045 www.atv-autoteile.de besten Angeboten rund ums Auto. Der Autofahrerfachmarkt mit den
SPORTPLAKETTEDESLANDES: MaluDreyerehrtmitManfredPfeifferdenVorsitzendendesSportkreisesWorms IntegrationundInklusionwerdenimSportgelebt TGWORMSHOCKEY: HerrenlandenpunktlosaufdemletztenPlatz KnappeHeimpleite TGWBASKETBALL: 2.MannschaftderHerrensiegtgegendieTSGHeidenheimmitdeutlichen81:35 MitklaremSiegindieWinterpause SVHORCHHEIM: StimmungsvollerGlühweinabend imWeihnachtsdorf MitCrêpes,Gulaschsuppe undWeihnachtstüten MOTORSPORT: SportlerundSportleiterausAlzey,Eichund Wormsausgezeichnet MSC-lerbeiSportlerehrung desADACMittelrhein DiehöchsteAuszeichnungfürdenSportinRheinland-Pfalz,dieSportplakette, wurdeManfredPfeiffer,SportkreisvorsitzenderderStadtWormsvonMinisterpräsidentinMaluDreyerüberreicht.Foto:StaatskanzleiRLP/Silz BegeisterteMotorsportlerausderRegionsindjüngstausgezeichnetworden.
TypischfüreineMannschaftimTabellenkellerist,dassdannmanchmalauchnochdasQuäntchenGlückfehlt,umeinSpiel fürsichzuentscheiden.
„BewegterAdvent–Verein(t)inderSchule“

DieAktion„BewegterAdvent –Verein(t)inderSchule“,eine Gemeinschaftsproduktionder Landesinitiative„LandinBewegung“unddemorganisierten SportmitdemSportbund Rheinhessenalseinregionaler VertreterbringtKinder,SportvereineundSchulenzusammen.Spielerischsollendie KleinsteninderVorweihnachtszeitanSportartenundVereinslebenherangeführtwerden.Wie dasfunktioniert,zeigtesichbestensmitdemAktionstagder Diesterweg-Grundschuleund demTV1863Worms-Leiselheim.

IneinemactionreichenAirTrack-Parkourkonntensichdie 180SchülerinnenundSchüler der1.bis3.KlassevomvielseitigenVereinsangebotdesTurnvereinsüberzeugen.Unterstützt wirdderVereindabeimiteiner finanziellenFörderungausder Mitgliedergewinnungskampagne#Comebackder#Bewegung desSportbundesRheinhessen unddesLandessportbundes Rheinland-Pfalz(LSB)sowieder SportbündeRheinlandund Pfalz.
DerSportbundRheinhessen hatgemeinsammitderLandesinitiative„LandinBewegung“ sowiedemLSBunddenSportbündenRheinlandundPfalz rheinland-pfälzischeVereine undSchulenaufgerufen,SportangeboteimSchulalltagzupräsentierenunddieSchüler/innenfürdenVereinssportzugewinnen.„Wirfreuenuns,dass

vieleSchulenundVereineunseremAufrufgefolgtsindundim RahmenderAktion„Bewegter Advent–Verein(t)inderSchule“einzusätzlichesBewegungsangebotaufdieBeinestellen“, sagtJochenBorchert,ProjektadministratorderInitiative„Land inBewegung“.
„Seitdem28.NovemberwerdeninzahlreichenSchulenim ganzenLandSchüler/innenin Bewegunggebrachtundhaben imRahmenderAktiondieeinzigartigeMöglichkeit,unterschiedlicheAngebotederbeteiligtenSportvereinekennenzulernen.“
EinedieserSchulenistdie Diesterweg-Grundschulein
Worms.SportlehrerUliBottelbergerwardemAufrufgefolgt undhattemitdemTVLeiselheimumÜbungsleiterFrank Schembsschnelldaspassende Vereinssportangebotgefunden.
Am13.Dezemberwaresso weit,dieSchülerinnenund Schülerdererstenbisdritten KlassedurftensichinderTurnhallederDiesterweg-Grundschuleaneinemactionreichen AirTrack-Parkourausprobieren. FrankSchembsundsein TeamhattennebeneinermeterlangenAirTrack-Matte,die durchAirBagseinezusätzliche Sprungkraftverleihtundeine sichereLandunggarantiert, auchAirRolls,Airboard-Boos-
tersundanderesVereinsequipmentmitgebracht.DenKindern solltensospielerischdiegrundspezifischenBewegungsabläufe wieLaufen,SpringenoderKletternnähergebrachtwerden. AuchdiefürdenTurnsportrelevantenVoraussetzungenwieKoordination,Gleichgewichtoder Reaktionsfähigkeitwurden durchdasvierköpfigeÜbungsleiter-Teamvermittelt.






„Wirfreuenuns,dasswirden SchülerinnenundSchülerunserVereinsangebotvorstellen könnenundhoffen,dasssievon unserenAirTracksbegeistertwarenundsofürdenSportimVereingewonnenwerdenkönnen“, sagtder20-jährigeÜbungsleiter
PaulKoob,derfrüherselbstdie DiesterwegGrundschulebesuchthatte.
„Wichtigist,dasswirdieKindernachderbewegungsarmen PandemiezeitmitdenAktionen indenSchulenwiederzurückin dierheinhessischenSportvereinebringen“,sagtKlausKuhn, PräsidentdesSportbundes Rheinhessen.„MitderfinanziellenFörderungimRahmender Mitgliedergewinnungskampagne#Comebackder#Bewegung unterstützenwirdieVereinein derAnschaffungvonprofessionellemTrainingsequipmentwie etwadenAirTrack-Matten“,ergänztThorstenRichter,SportbundRheinhessenGeschäftsführer.
500EuroFörderung
WeitereAktionenvonSchulen undSportvereinenfindenim Rahmenvon„BewegterAdvent –Verein(t)inderSchule“noch biszum18.Dezemberstatt.Die finanzielleFörderungbeträgt biszu500EuroundsolldieVereinebeidenÜbungsleiter-,Material-oderAnfahrtskostenunterstützen.
MittelgebersindimRahmen derMitgliedergewinnungskampagnedasMinisteriumdesInnernundfürSportundimRahmenderganzjährigbestehendenFörderung„Sportfinder“für KooperationsaktioneninGanztagsschulen,dasMinisterium fürBildung.
SCIBERSHEIM
Unser Tipp zur Unterstützung des Immunsystems












Forscher haben herausgefunden: Der Darm ist nicht nur für die Verdauung zuständig. Rund 70 % aller Immunzellen sind im Darm beheimatet. Daher kann es in der kalten Jahreshäl e sinnvoll sein, den Darm zu unterstützen. Unser Tipp: das Nahrungsergänzungsmittel Kijimea Immun (Apotheke). Es enthält hochdosierte Mikrokulturen – ein Sachet entspricht in etwa 3 kg Joghurt. Darüber hinaus enthält Kijimea Immun Vitamin D zur Unterstützung der normalen Funktion des Immunsystems. Das enthaltene Riboflavin trägt zum Schutz der Zellen vor oxidativem Stress und zur Reduktion von Müdigkeit und Abgeschlagenheit bei.
BeimSCIbersheimfandendie Dart-Vereinsmeisterschaftenstatt.
AnfangDezemberveranstaltetedieAbteilungDartdes SportClubIbersheimihre diesjährigenVereinsmeisterschaften.

ZumTurnierhattensich16 Dartereingefunden,um ihrenMeisterherauszu spielen.
InzweiGruppenmitanschließenderK.O.-RundeerreichtenStevenBeckergegenBastiElbsundChristian OttgegenThomasBayerdie Halbfinals.ImFinalesetzt sichThomasBayergegen BastiElbsdurchundsichertesichdamitdenTitel. ChristianOttwurdeDritter. AlleSpielerkonnteninneuenTrikotsspielen,diese wurdengesponsortvonder FirmaSOLWIGsmartsolar solution.Hierfürbedanken sichdieSpielerbeiAndres HermannvonderFirmaSolwig.
TrainingistimmerdonnerstagsimKellerderOrtsverwaltung,Spielesindmontagsjeweilsab19Uhr.Neue undinteressierteSpieler sindherzlichwillkommen.
Immer wieder Durchfall, Bauchschmerzen, Blähungen
Forscher entdecken häufige Ursache von wiederkehrenden Darmbeschwerden

kommt zu wiederkehrendem Durchfall, o gepaart mit Bauchschmerzen, Blähungen, teilweise Verstopfung. 2
Innovatives Medizinprodukt aus der Apotheke Das von deutschen Forschern entwickelte Medizinprodukt Kijimea Reizdarm PRO (rezeptfrei, Apotheke) setzt genau dort an. Die darin enthaltenen einzigartigen Bi do-Bakterien vom Stamm B. bifidum HI-MIMBb75 lagern sich an die Darmbarriere an – sinnbildlich wie ein P aster über einer Wunde. Die












Kijimea Reizdarm PRO


besondere Idee: Unter diesem P aster kann sich die Darmbarriere regenerieren, die Darmbeschwerden können abklingen.
Klinisch belegte Wirksamkeit bei Reizdarm In der weltweit größten OTC-Studie zum Reizdarmsyndrom 3 konnte die Wirksamkeit von Kijimea Reizdarm PRO bei Reizdarmbeschwerden eindrucksvoll belegt werden.4 Das Entscheidende: Auch die Lebensqualität der Betro enen verbesserte sich.

Wiederkehrende Darmbeschwerden wie Durchfall, Bauchschmerzen und Blähungen belasten den Alltag Millionen Deutscher.1 Lange Zeit waren die ReizdarmUrsachen unklar – doch aktuelle Studienergebnisse haben nun eine geschädigte Darmbarriere als einen
Auslöser erkannt. Ein innovatives Medizinprodukt (Kijimea Reizdarm PRO, Apotheke) setzt hier an und verspricht so wirksame Hilfe.
Geschädigte Darmbarriere als häu ge Ursache Wissenschaftler konnten zeigen, dass in der Regel eine
geschädigte Darmbarriere die Ursache wiederkehrender Darmbeschwerden ist. Schon kleinste Schädigungen (sogenannte Mikroläsionen) reichen aus, um Erreger und Schadsto e in die Darmwand eindringen zu lassen. In der Folge wird das enterische Nervensystem gereizt, es
658-666. • Abbildung Betroffenen nachempfunden.
Samstag,17.Dezember2022| NIBELUNGENKURIER LOKAL-SPORT 21
Wie ein
für
Mit
4 Für Ihre Apotheke: Kijimea Reizdarm PRO (PZN 15999676) www.kijimea.de 1Straub C. et al. Arztreport 2019 – Pressemappe. 2019. • 2 Wood J.D. (2007). Effects of bacteria on the enteric nervous system: implications for the irritable bowel syndrome. Journal of clinical gastroenterology, May-Jun 2007; 41 Suppl 1, 7-19. doi: 10.1097/MCG. 0b013e31802f1331. PMID: 17438418. • 3 Vergleich berücksichtigt ausschließlich Studien mit probiotischen Stämmen. • 4Andresen V. et al. (2020). Heat-inactivated Bifidobacterium bifidum MIMBb75 (SYN-HI-001) in the treatment of irritable bowel syndrome: a multicentre, randomised, double-blind, placebo-controlled clinical trial. Lancet Gastroenterol Hepatol. 2020 Jul; 5(7),
Pflaster
den gereizten Darm
dem einzigartigen Bakterienstamm B. bifidum HI-MIMBb75
Wirksamkeit bei Reizdarm klinisch belegt
(Abbildung Betroffenen nachempfunden.) Für Ihre Apotheke: Kijimea Immun (PZN 05351052) www.kijimea.de
221129_HP1232_L_TZWOB-F03_V2_cz.indd 1 29.11.22 15:00
Medizin ANZEIGE
SPORTBUNDRHEINHESSEN: Aktionbringtrheinland-pfälzischeSchülerinnenundSchülerinBewegung
DieAktionanderDiesterweg-GrundschulewarfüralleBeteiligteneinganzbesonderesErlebnis.
ThomasBayersichert sichdenTitel
KnappesRennenumAufstieg
ZumAbschlussderHinrunde fandinderJahnturnhalleein Doppelspieltagstatt.Zunächst startetedieTGWormsimAufstiegsrennengegenTVMainzZahlbach,deren3.Mannschaft zuGastwar.
DieMainzerstartetendiesmal mitihrerstärkstenAufstellung, dochauchdieWormserkonnten ausdemVollenschöpfen.
DieHerrendoppelmitTecklenburg/ReimanngegenDilg/ BarthundLohmann/BraamgegenWieland/Knauppwarenjeweilstemporeichundspielten sichaufeinemhohenNiveau ab.Währendesdem1.HDmit 18:21-21:12:21:11gelang,die Punkteeinzufahren,wurdedas 2.HDmit18:21-20:22denkbar knappwegeneinigervermeidbarerFehlerabgegeben.


DieDamenA.Knaub/Tran kämpftenbeherztgegendas starkeDoppelK.Roh/Lehmann, konntensichjedochinsbesondereim2.Satznichtdurchsetzen(21:23-12:21).
DasMixedmitA.Knaub/ BraamgegenA.Roh/Löbigfand erstim2.SatzinsSpiel,musste sichjedochauchhiermit12:2117:21geschlagengeben,wobei durchausmehrdringewesen wäre.ImEinzelwarensowohl TranimDEgegenLehmann (11:21-13:21)alsauchW.Knaub
im3.HEgegenWieland(12:2116:21)klarunterlegen,womit dieNiederlagefeststand.DennocherkämpftesichTecklenburgim1.HEgegenBarthmit einemweiterenPunkt.Reimannunterlagim2.HEDilgim 1.Satzunglücklichmit19:21 undfandim2.keinenrechten Zugriffmehr(12:21),sodassdieserzum2:6-Endstandpunkten konnte.
MitdiesemSiegleistetendie Gästesowohlihrer4.MannschaftSchützenhilfe,sodassdiesesichinderTabellemit10 PunktenvordieWormser(9 Punkte)schiebenkonnten,klettertenaberauchselbstaufgrund einerbesserenPunktedifferenz
vom3.Platzaufden2.Platzvor dieTGW.Inder2.PartiedesTageszeigtendieWormsergegen TSVMommenheimallerdings einebeeindruckendeReaktion. Ohnesichlangemitder1.NiederlagederSaisonzubeschäftigen,zeigtendieTGWler,dass derKampfumdenAufstieg nochnichtentschiedenist.
Im2.HDstartetenW.Knaub/ LohmanngegenSpengt/Knaus undwehrteninbeidenSätzen mehrereSatzbällederGegner ab,ummit23:21-22:20letztlich verdientden1.Punkteinzutüten.ImDDgelangesA.Knaub/ IhrckegegenGürtler/Seemann nachverlorenem2.Satznoch malalleKräftezumobilisieren undklarmit(21:17-17:21-21:13) zugewinnen.
Das1.HDmitTecklenburg/ Reimannverlorunnötigerweise zwarden1.Satzmit18:21,gewanndannabermit21:12deutlich.
Durchdiekrankheitsbedingte AufgabevonSchmahlgingdas Spieldannebensowiedas2.HE zugunstenderWormseraus.Im 1.HEmachteesTecklenburg zwarmit21:18-21:23-21:10spannend.DieübrigenzweiEinzel vonTranundW.Knaub,aber auchdasMixedmitBraam/ A.KnaubgingenjedochklarzugunstenderTGWaus,sodass ein8:0-Siegverbuchtwerden konnte.
NeuePräventionsangebote
GleichimneuenJahrstartet dieTurngemeindeWormswiedermitihremerstenPräventionsangebot„Bewegenstattschonen–einGanzkörper-Kräftigungsprogramm“.
NebenderSchulungeinernatürlichenundgesundenHaltungundBewegungstellenvor allemderEinsatzkomplexer funktionellerDehn-,Kräftigungs-undStabilisationsübungendieSchwerpunktedesKursesdar.DerKursrichtetsichan Personen,diegezieltetwasgegendenBewegungsmangelund

diedamitverbundenenRisikofaktorenundBeschwerdentun wollenundistbesondersfür Einsteigerund/oderUngeübte geeignet.Der10-wöchigeKurs findetab11.Januarjeweilsmittwochsvon9bis10.30Uhrinder NeuenJahnturnhalle,Philosophenstraße12(Jahnwiese)in Wormsstatt.DieKursgebühr beträgt90Euro.
Ab20.Märzheißtesdannwiederjeweilsmontagsvon17.30bis 19Uhr„AndieStöcke–fertig–los“mitdembeliebtenNordicWalking-KursunterderLeitung

vonTanjaHauzeneder.Der KursistidealfürAnfänger,um diegesundeundempfohlene Lauftechnikzuerlernen,aber auchfürTeilnehmer,welche schoneinenKursgemachthabenundIhreTechnikauffrischenwollen.Beimaximal8 Kursteilnehmernkannindividuellaufjedeneinzelneneingegangenwerden.DieKursgebührbeträgt85Euro.DieAnmeldung fürbeideKurseerfolgtüberdie HomepagederTGWunterwww .tgworms.de.WeitereInformationenunterTelefon06241/25717.
FürdieSchwimmerderSG WormsgingeszumerstenWettkampfaufderLangbahnindieserSaisonnachKarlsruhezu den55.ISTKA(Internationale Schwimmsport-Tage).

EinWettkampfaufderLangbahnbedeutetauchimmereine UmstellungfürdieSchwimmer. „FürdieAktivenistessehrgut
gelaufen“,sodasTrainergespannderSGWormsKyraWiegandundMaximilianRehberg. „AlleSchwimmerkonntenBestzeitenschwimmen.
EintollerLohnfürdengezeigtenTrainingsfleiß“.
FünfSchwimmer(DafneStibenz,LenaUmland,LuisPflug, GeorgianMocanuundAndrii
Yankovenko)durftensichininsgesamt11Streckenineinem jahrgangsübergreifendenFinale mitdenBestenmessen.
MitinsgesamtfünfPodestplätzenhabensichAndriiYankovenkoundDafneStibenzbesondersbelohnt,daruntereine GoldmedaillefürDafneüber50 mKraul
Online-Kanäleunterstützen.
•SieerhalteneinFestgehaltplusErfolgsprämie.
EinesorgfältigeundgewissenhafteArbeitsweiseistebensowichtigwieFreundlichkeitundkundenorientiertes DenkenundHandeln sowiesehrguteDeutschkenntnisseinWortundSchrift.
Wirbieteneinenabwechslungsreichenund vielseitigenJobineinemfreundlichenTeam. BittesendenSieIhreBewerbungmitallen UnterlagenausschließlichperE-Mailan anzeigen@nibelungen-kurier.de GebenSiebitteIhreGehaltsvorstellung undIhrenfrühestmöglichenEintrittsterminan.

STELLENMARKT 22 LOKAL-SPORT NIBELUNGENKURIER| Samstag,17.Dezember2022 Zuverlässige Reinigungskraft (m/w/d) fürZahnarztpraxisinWorms Horchheimgesucht.Mo,Di,Do ab18Uhr,Miu.FrNachmittags Bewerbungenbittean: PraxisDr.Rolf Gerkhardt ObereHauptstraße12, 67551Worms-Horchheim 22_50s REINIGUNGSKRAFT WIR SUCHEN! (M/W/D) Alzeyer Str. 121 67549 Worms 0170 94 75 937 c.werschke@blackandwhite.de TEILZEIT - FLEXIBLE ARBEITSZEITEN Fitness, Wellness, Health Schöfer Mainzer Straße 23 67577 Alsheim T +49 (0) 6249 4948 info@euronics-Schoefer.de REINIGUNGSKRAFT für Geschäftsräume GESUCHT (m,w,d) Wöchentlich ca. 4 Stunden als Minijob Wirsuchenabsoforteinen MITARBEITER KUNDENBERATUNGUNDVERKAUF (m/w/d)inVollzeit(40Std./Woche) SieunterstützenaktivnachderEinarbeitungunsereKundenbetreuungperTelefonundE-Mail. •EntsprechendeErfahrunginderBestandskundenpflegehabenSiebereitserworben. •Siesindkommunikationsstark-perTelefonundperE-mail. •WennSieSocial-Media-Affinsind,könnenSieunsnebendemPrintbereichauchbeimVerkaufunserer
22_50m jobs.nibelungen-kurier.de Verkäuferin (m/w/d), inVoll-oderTeilzeitsowie Fahrer
inTeilzeitoder520-Euro-Basis
reinstadlergmbh@t-online.de 22_50s DerregionaleStellenmarkt: jobs.nibelungen-kurier.de DieaktuellenStellen-AngeboteausdemNKonlineabrufbar BADMINTON-VERBANDSLIGANORDOST: TGWorms–TVMainz-ZahlbachIII2:6/TG Worms–TSVMommenheim8:0
(m/w/d)
abSOFORT gesucht. BäckereiReinstadler Winzerstraße16·Worms-Leiselheim, Tel.(06241)75151
TURNGEMEINDEWORMS: "BewegenstattSchonen“und„NordicWalking“
einmalgewinnen,mussteaberaucheinmalverlieren.Foto:FelixDiehl DieSchwimmerderSGWormswarenzufriedenmitihrenLeistungen. Die1.MannschaftderTGWorms. SGWORMS: TeilnahmeamSchwimmwettkampfinKarlsruhe
WiedasgesamteTeamamDoppelspieltagkonnteWaldemarKnauppimEinzel
Trainingsfleißwurde mitBestzeitenbelohnt
Erzieher
und Teilzeit
Wir erwarten neben einer abgeschlossene Ausbildung zur Erzieherin / zum Erzieher ein hohes Maß an sozialer Kompetenz und fundiertes pädagogisches Fachwissen. Wir bieten einen abwechslungsreichen Arbeitsplatz mit Gestaltungspielraum und Entwicklungs- und Fortbildungsmöglichkeiten, eine tarifliche Vergütung nach dem TVöD inkl. Jahressonderzahlung + zusätzliche Altersversorgung, ein offenes Team und einen engagierten Träger.
Bei Fragen zur ausgeschriebenen Stelle steht Ihnen der Ortsbürgermeister der Ortsgemeinde Flörsheim-Dalsheim, Herr Rohrwick unter Tel. 0170 / 801 02 16 oder die Kita-Leitung, Frau Bauer unter der Tel. 0 62 43 / 64 42 als Ansprechpartner zur Verfügung. Vollständige Ausschreibung unter www.kitakunterbunt.com Ortsgemeinde Flörsheim-Dalsheim, Kita Kunterbunt, Rödlerstraße 3 in 67592 Flörsheim-Dalsheim oder per E-Mail info@floersheimdalsheim.de

2023–StartenSiedurch inWormsbeiuns
2TT-FahrerabsofortzurAuslieferungvonTK-geführten LebensmittelninSüddeutschland
VoraussetzungFührerscheinklasseC/CEsowiegültige Fahrer-undModulkarte Kontakt:06242-91302-16–Hr.Wüstner 22_50s
ZumnächstmöglichenZeitpunktsuchenwirSieals Steuerassistent/Steuerfachangestellter/ Steuerfachwirt/Bilanzbuchhalter (m/w/d)
IhrProfil:•gutesFachwissendesSteuerrechts
•idealerweiseErfahrungausderSteuerpraxis
•Datev-undMS-Office-Kenntnisse
•teamfähig,engagiertundflexibel
•offenfüreinenaktivenKontaktmitdemMandanten
HabenwirIhrInteressegeweckt? DannschickenSieunsIhreBewerbungsunterlagen perMailan kanzlei@killundbloch.de
Kill&Bloch WirtschaftsprüferSteuerberater Sedanstraße14,68623Lampertheim, 06206-9291-0,www.killundbloch.de

SUCHENSIEEINENNEBENJOB?
ArbeitenanderfrischenLuftundjede MengeBewegung. Zeitungsausträger (m/w/d) fürdieZustellungdesNibelungenKuriers absofort mitfestemGebietin:
•Herrnsheim (Großgebiet)
•Weinsheim (ab1.Januar2023)
Egal,obSieSchüleroderRentnersind, Hausfrau,berufstätigoderarbeitslos–wennSiegutzuFuß,zuverlässigund gewissenhaftsind,bewerbenSiesich.
FreieZeiteinteilung(dieZustellungmussmittwochs bis18Uhrundsamstagsbis16Uhrerfolgtsein)
BittekontaktierenSieunseren VertriebsleiterHerrnKuball unter Telefon(0176)60181040 (Di.undFr.,von9bis17Uhr) oder jederzeitperWhatsApp. IhrWohnortistnichtdabei?Dannschreiben Sieunsundlassensichvormerken, wenneinBezirkinIhrerNäheneuzuvergebenist.

• PersonalsteuerungundLeitungdesBereichsder ambulantenPflege
• SieübernehmendiepflegerischeVerantwortung
• EffizientePersonaleinsatz-undTourenplanung, aktiveKundenakquiseundPflegedesKundenstamms
• MitarbeiterorientierteFührungeinesmotivierten PflegeteamsausPflegehilfs-undPflegefachkräften
• SicherstellungunsererPflege-undQualitätsstandards sowiederZufriedenheitunsererKunden
• UmsetzungderExpertenstandardsnach§113aSGBXI
• Tourenbegleitung,Visiten,Erst-undFolgegespräche IhrProfil:



• EineabgeschlosseneBerufsausbildungalsAltenpfleger, Gesundheits-undKrankenpflegeroderGesundheits-& Kinderkrankenpfleger
• AnerkennungzurPflegedienstleitungnach§71SGBXI
• BerufserfahrungalsPflegedienstleitungeines ambulantenPflegedienstes
• KenntnisseambulanterPflegesoftware
• DieFähigkeit,einTeamzuleitenundweiterzuentwickeln
• Kundenorientierte,teamfähige,selbstbewussteund lösungsorientierteArbeitsweise
WirbietenIhnen:
• UnbefristeteFesteinstellung
• DirekteKommunikationmitderGeschäftsführung
• LeistungsgerechteVergütungnachTVAltenpflege Deutschland
• Fort-undWeiterbildungsmöglichkeiten
• tolleArbeitsatmosphäreundgroßartigeKollegen
MehrInfoszumJob?LassenSieunstelefonieren: BeateBiegi-Franz/UweFranzTel.06247/2713379
IhreBewerbungsendenSiegerneauchperE-Mailan: MarBeaPflegedienstGmbH·Zellertalstraße8,67551Worms uwe.franz@marbea-pflege.de·www.marbea-pflege.de

Samstag,17.Dezember2022| NIBELUNGENKURIER STELLENMARKT 23
2023–StartenSiedurch inWormsbeiuns FahrerimNahverkehr–TagestourabsofortzurAuslieferung vonTK-geführtenLebensmittelninSüddeutschland VoraussetzungFührerscheinklasseC/CEsowiegültige Fahrer-undModulkarte Kontakt:06242-91302-16–Hr.Wüstner 22_50s UnserprivatgeführterambulanterPflegedienstbestehtseit12Jahrenundhat sichstetigpositivweiterentwickelt.WegenEintrittderbisherigen StelleninhaberinindasRentenalterstellenwireinzum01.04.2023oderfrüher Pflegedienstleitung/PDLAmbulantePflege(m/w/d) Aufgabengebiet:
22_50s
22_41s REINIGUNGSKRÄFTE WIR SUCHEN! (M/W/D) Alzeyer Str. 121 . 67549 Worms 0170 94 75 937 c.werschke@blackandwhite.de MINIJOB - MEHRERE STELLEN Fitness, Wellness, Health Die Ortsgemeinde Flörsheim-Dalsheim sucht zum nächstmöglichen Zeitpunkt für die kommunale Kindertagesstätte Kunterbunt mehrere
(m / w / d) in Voll-
(unbefristet)
22_50m N I BE L U N G E N LA N D VertriebsgesellschaftmbH ImmeranderfrischenLuft: IST DAS IHR NEUER TEILZEITJOB? Wirsuchenabsofort Zeitungszusteller (m/w/d) InwechselndenBezirkeninnerhalbdesNK-Verbreitungsgebiets Wirbieten: •20bis30Stunden/Woche•FlexibleZeiteinteilung•Kilometergeld •Quereinstiegmöglich•UnbefristeterArbeitsvertrag •SozialversicherungspflichtigesAnstellungsverhältnis Anforderungen: •Körperlichbelastbar/wetterfest•PKWundPKW-Führerscheinerforderlich IhreHauptaufgabeistes,mittwochsundsamstags(inAusnahmefällenzusätzlich
BittekontaktierenSieunserenVertriebsleiterHerrnKuball unter Telefon(0176)60181040
LANGE+GÜLCHER AmbulantesPflegezentrumLange+Gülchersucht: •Pflegefachkräfte (m/w/d) •Pflegekräfte miteinjährigemExamen(m/w/d) •Pflegehilfskräfte (m/w/d) mitPKW-Führerschein,inVollzeit,TeilzeitoderaufAushilfsbasis. Wirbieten: Einfreundliches,kompetentesTeam,übertariflicheBezahlung, familienfreundlicheDienstplanung,6WochenUrlaub,Urlaubsgeld, 38,5Std.Woche,ZuschlägeanSonn-undFeiertagen, VWL/betrieblicheAltersvorsorge,Fort-undWeiterbildungen. WirfreuenunsaufIhrenAnrufoderIhreschriftlicheBewerbung: Wirzahlen übertariflich! Hauptstraße97,67583Guntersblum,Tel.:06249-8045330 oderperE-Mailaninfo@pflegezentrum-lange-guelcher.de 22_47s DA GUGGSTE: AUGENOPTIK, GESELLE:IN oder MEISTER:IN IN VOLLZEIT GESUCHT! Jetzt bewerben! Wir freuen uns über Deine Bewerbung und stehen bei Rückfragen gerne zur Verfügung. 0 62 45-75 85, j.graetz@optik-akustik-graetz.de (m,w,d) Biblis – Bensheim – Lampertheim Wir freuen uns auf Ihre Bewerbung! Fon 06241.76066 E-Mail: arbeiten@truschel-worms.de www.truschel-worms.de Ab sofort suchen wir einen Technischen Zeichner (m/w/d) auf Mini-Job-Basis oder auf Basis freiberuflicher Mitarbeit Nachhilfelehrer Selbstbewusstsein! Subunternehmer
22_33s
Ortsgemeinde Flörsheim-Dalsheim
donnerstagsundsonntags)denNibelungenKurierinverschiedenenGebietenzuzustellen. DieseAufgabeübtsichselbstverständlichinEigenverantwortungausundSiehabendaher flexibleMöglichkeiten,sichIhreZeiteinzuteilen.
(Di.undFr.,von9bis17Uhr) oder jederzeitperWhatsApp.
miteigenemTransporter fürdie AuslieferungvonZeitungen inWormsundUmland,Freitagnachtund gelegentlichDienstagnachtgesucht. Tel.(0172)9796323
MIETGESUCHE 2200
AN-UNDVERKÄUFE 7100
SIESUCHTIHN 70SI
IchbineinealleinstehendeRentnerin undsucheeine2-Zimmer-Wohnung, wennmöglichmitBalkon,kannauch eine1-Zimmer-Wohnungsein.WMbis 650,-EUR. Tel.(0171)54001605
MeinWeihnachtswunsch:Kleinehelle Wohnung inruhigerLagein/um Worms.Binzuverlässig,pünktlich. Schufa-Auskunftvorh. gerne.wohnen1@gmail.com Tel.(0179)7824929
GEWERBE 4000
Timo sucht Pelze aller Art, Zinn, Silber Korallen, Teppiche, Möbel, Flohmarktsachen, Modeschmuck, Münzen, def. Uhren, Militär Zahle bar und fair 06181-3029629

TIEREVERMISST 75EF KatzeLilliseit19.10.22inWesthofen vermisst!
IMMOBILIENGESUCHE 1200
IMMOBILIENSERVICE DENSCHLAG Tel. (0 Seit 1974 Ihr Makler für Worms und ganz Rheinhessen 22_16s Baufinanzierung ohne Eigenkapital Ratenkredite Finanzplus Silcherstraße 12 · 67591 Mölsheim Mobil (01 79) 2 01 70 90 info@finanzplus-online.de auch am Wochenende erreichbar 22_49s „Irgendwann ist irgendwann zu spät!“ JETZT Immobilie diskret und direkt verkaufen. Bitte alles anbieten! Immobilien Kiesewetter GmbH Tel. (01 78) 7 10 07 30
Suche2ZKBzukaufen,bis95.000,–EUR,ohneMakler,Worms+Umgebung,Frankenthal,BadDürkheim. Telefon(0179)3476888




GEWERBERÄUME 23GR/24GR Gewerberäume/Wohnungzvm., 2½ ZKB,EBK,50m²,Wo.-Wiesoppenheim,KM450,–EUR+NK. Telefon(06241)37698






GARAGE/STELLPLATZ 37/38GA Pkw-Stellplatz, 67547Wormsinder Mittelstraße,40,–EUR/Monatzvm. Telefon(0176)20939124
SucheGarageoderTG-Stellplatzin Worms oderNahbereichzukaufen. Telefon(01520)5418592
MIETANGEBOTE 2100
ZurMiete:Gimbsheim,EFH84m², 4 ZimmermitjeDusche/WC+WZu. Küche,Hofnutzung,KM700,–EUR+ NK+2MMKT,ab1.1.23.
Telefon(0163)2949626
Ständig1Zi.inWG, möbliert,mitKüche&BadinWormsoderOsthofen zvm.WM450,–EUR(inkl.NK). Telefon(0171)1987003
Worms,Valckenbergstraße:2ZKB, EBK, Gas-Hzg.,Bodenkpl.gefliest,EG links,zum1.1.23zvm.,KM700,–EUR +NK300,–EUR+3MMKT/Provision.
Telefon(0179)1983888 od.(06241)9772177 Anrufezw.12u.20Uhr
Worms,NäheStadion,toprenovierte 1½ZB,EBK,35m²,KM400,–EUR+ NK+KT.




































Telefon(0173)3485482
MIETGESUCHE 2200
Suchezum1.4.2023oder1.5.2023eine Wohnung,68–75m²,2–3ZKBm.Dusche,Parterreoder1.StockinOsthofen2Personen(Rentnerehepaar). ZuschriftenerbetenanVerlagNibelungenKurierGmbH,Prinz-Carl-Anlage20, 67547WormsoderperE-Mailanverlag@nibelungen-kurier.deunter: Chiffre7413
Suche1ZimmermitKücheundBad in Worms. Tel.(0170)7806432









STELLENANGEBOTE 001NE
ERSUCHTSIE 70ES
Er,23J.,afrikanischerHerkunft,sucht Sie fürfesteBeziehung(bis25J.). Gehegernespazieren,Essengehen. BittenurernstgemeinteZuschriften. ZuschriftenerbetenanVerlagNibelungenKurierGmbH,Prinz-Carl-Anlage20, 67547WormsoderperE-Mailanverlag@nibelungen-kurier.deunter: Chiffre7405
Er,63J.,171cm,NR, ld.,m.Hausu. Garten,möchtenetteSIEkennenlernen.
SucheHaushaltshilfeinWorms-West, 2xwöchentlich(Minijob). Telefon(06241)77442


SuchezuverlässigePflegekraft, FührerscheinBedingung,MinijoboderTZ. Tel.(06241)9798330



WirsucheneinetierliebePutzfeefür2 Haunshalte inOsthofen(je2Pers. und2Kater).Whg.1:70m²,2Std./Woche.Whg.2:100m²,ca.3Std./Woche. Nachmittagsab14Uhr. ZuschriftenerbetenanVerlagNibelungenKurierGmbH,Prinz-Carl-Anlage20, 67547WormsoderperE-Mailanverlag@nibelungen-kurier.deunter: Chiffre7417



STELLENGESUCHE 020G
AltenpflegerinsuchtStellealsBetreuerin/Hilfe beiEinkaufenetc.(Minijob). Telefon(0152)10175263

SucheArbeitalsMaler,Lackierer, Spachtelarbeit,Fassaden,Bodenlegen (Minijob). Telefon(0152)11369758
SucheArbeitzurUnterstützungbeiComputer,Internet,Smartphone,App,EMail.RufenSiemichan.IchhelfeIhnen inallenPunktenundbringeesIhnenbei. Telefon(0157)85100696
AN-UNDVERKÄUFE 7100
MaineCoon,Weiblich.TransponderID:276099200452539.Finderlohn!Bittemeldenunter Telefon(0176)34909740


Hachiko
ZuschriftenerbetenanVerlagNibelungenKurierGmbH,Prinz-Carl-Anlage20, 67547WormsoderperE-Mailanverlag@nibelungen-kurier.deunter: Chiffre7414
Er,62J.,1,90m,ehrl., zuverl.,suchtliebe,sympathischeFrau(bis64J.)für eineernsthafteBeziehung. ZuschriftenerbetenanVerlagNibelungenKurierGmbH,Prinz-Carl-Anlage20, 67547WormsoderperE-Mailanverlag@nibelungen-kurier.deunter: Chiffre7415
FREIZEIT-/URLAUBSAKTIVITÄTEN 70FU
Rommé-,Rummikub-,Kniffel-Freundin,fußläufigNäheWEPgesucht ZuschriftenerbetenanVerlagNibelungenKurierGmbH,Prinz-Carl-Anlage20, 67547WormsoderperE-Mailanverlag@nibelungen-kurier.deunter: Chiffre7416
KFZ-MARKT 3000/3200
Vermisstseit4.9.2021inAlsheim.Ich bindankbarumjedeMithilfe,bittehaltetdieAugenoffenundschautgenau hin.Finderlohn! Telefon(0179)2999950

TIERMARKT 71TI 3reinrassigeChihuahuaWelpen
BARANKAUF VORORT von allen Kfz-Arten sowie Unfallwagen, Motorschaden, viel km u. ohne TÜV Albert Automobile 24 Std. a. Sa/So Tel. 0611-3608877 · 0151-16546717

WerhatInter.an24LPsOpernu.Operetten aus3Jahrhu.,nochnichtbesp., gegenGebotzvk. Telefon(06241)37491
LLauf:NEU:Ski187cm,S-light-crown, Atomic451/3,Leki-carbon150–160 cm,VHS220,–EUR. Telefon(0175)5277903


3xAkkordeonMarkeDeLuxAlantic, Hohner,günstigzvk. Telefon(06241)88499 oder(0176)28807154
(schwarzgestromt),sucheneinliebevollesZuhause.Geboren05.09.2022, geimpftundgesund.Absofortabholbereit,VHB600,–EUR. Telefon(0172)9198827
ZweiKaninchen,2Jahre,kastriert und geimpft,mitStallanliebeTierfreunde wegenUmzugsabzugeben. Telefon(06241)51328

VERSCHIEDENES 7500
Geschenk,
Der Auftraggeber erklärt sich bereit, für Rückfragen und Leserservice vom Nibelungen
angerufen zu werden. Ihr Widerrufsrecht erlischt , nach dem jeweiligen Ablauf des Anzeigenschlusstermins der gebuchten Ausgabe. Gemäß Art. 6 DSGVO werden die Daten für den Geschäftszweck elektronisch verarbeitet und gespeichert. Es gelten unsere allgemeinen Geschäftsbedingungen (https://nibelungen-kurier. de/impressum/) sowie unsere Datenschutzerklärung (https:// nibelungen-kurier.de/datenschutzerklaerung/)
Miteinander (nur mit Chiffre möglich)






Täglich 24 Stunden erreichbar! Auch sonn- & feiertags
22_11s Autopark Gernsheim Ankauf aller Fahrzeuge! Auch nach Unfall & ohne TÜV! (0 62 58) 37 73 (01 74) 2 02 77 29 22_09s GebrauchtwaGenanKauF Auch mit vielen Kilometern, Unfallwagen &sonstigen Mängeln, mit &ohne TÜV! MZ-Automobile Robert-Koch-Str. 16 55129 Mainz-Hechtsheim Tel.06131.40405 0171.4284331

Genießer aufgepasst! 2x genießen, 1x sparen! VMG, Vertriebs-Marketing-Gesellschaft mbH, Niedesheimer Str. 18, 67547 Worms
Jetzt zugreifen auf gutscheinbuch.de Nibelungen Kurier, Prinz-Carl-Anlage 20, Worms, Tel.: 06241-95780, Mo, Do: 12:00-18:00 Uhr • Di, Fr 09:00-12:00 Sonderpreis 16 ,€ 90 statt 39 ,€ 90
VerlagNibelungenKurierGmbH·67547Worms·Prinz-Carl-Anlage20 ZugleichauchladungsfähigeAnschriftfürdieimImpressumgenanntenVerantwortlichen) 062419578-0·Fax062419578-78·www.nibelungen-kurier.de·info@nibelungen-kurier.de Auflage51.545(mittwochs)59.225(samstags)verteilteExemplare Kombi-PreislisteNr.21/01.10.2022

DruckreiffzeitungsdruckGmbH·Offenburg VerteilungNibelungenlandVertriebsgesellschaftmbH Prinz-Carl-Anlage20·67547Worms·info@nvg-worms.de

RedaktionAndieserAusgabehabenmitgewirkt: RobertLehr,VeraBeiersdörfer,InaPohl,FlorianHelfert 062419578-25redaktion@nibelungen-kurier.de
VerantwortlichfürdenAnzeigenteilunddenredaktionellenInhaltFrankL.Meinel PrivateAnzeigen-Info062419578-0
FallsSiedenNibelungenKuriernichtmehrerhaltenmöchten,bittenwirSie,einenAufklebermitdem Hinweis„KeinekostenlosenZeitungen“anIhremBriefkastenanzubringen.WeitereInformationen findenSieaufdemVerbraucherportalwww.werbung-im-briefkasten.de
Coupon für private Kleinanzeigen Fotoanzeige nur 5,– EUR zusätzlich! ! Coupon ausschneiden und in Briefumschlag an den Verlag Nibelungen Kurier GmbH, Prinz-Carl-Anlage 20, 67547 Worms, schicken. Ihre Anzeige erscheint kostenfrei auch in unserer Online-Ausgabe! Wie oft soll Ihre Anzeige erscheinen? Anzeige soll x erscheinen Mi. Sa. oder aufeinanderfolgend + Foto € 5,– + Chiffre € 5,–Gesamtbetrag € Betrag liegt bar bei Bild liegt bei Bild per E-Mail gesendet an: verlag@nibelungen-kurier.de Name, Vorname
PLZ/Ort
Straße
Telefon
Datum Unterschrift
Kurier
Bitte gewünschte Rubrik ankreuzen
Mietangebote Mietgesuche Immobilien Garage/Stellplatz Verschiedenes Garten Stellenangebote Stellengesuche Verkäufe Suche Hobby Tiere Unterricht Auto Verschenken & Tauschen 1 x kostenlos* Coupon per Post schicken oder Anzeige online aufgeben (nur für Kunden mit Online-Banking): www.nibelungen-kurier.de 5,–10,– Für interne Bearbeitung bitte frei lassen: Geben Sie am Ende Ihres Textes bitte Ihre Telefon-Nummer an oder vermerken Sie „Chiffre“, falls gewünscht. * Kein Tausch gegen Wertgutscheine 24 FLOHMARKT NIBELUNGENKURIER| Samstag,17.Dezember2022 IMPRESSUM
KFZ-MARKT 3000/3200 KFZ BAR ANKAUF Alle Fahrzeuge PKW‘s, Busse, Geländewagen, Wohnmobile, Wohnwagen, Oldtimer, Traktoren, Bagger. Alles anbieten! (Baujahr, km, Zustand egal). Sofort Bargeld! Jederzeit erreichbar. 06158 - 6086988 0173 - 3087449 KAUFE AUTOS PKW, Busse, LKW, Geländewagen, Wohnwagen/mobile, Traktoren, Bagger, auch mit Mängeln. Zustand egal. Bitte alles anbieten, zahle bar und fair. 24 Stunden erreichbar! 06157/9168006 0177/3105303 SUCHE FAHRZEUGE PKW´s, Busse, Geländewagen, Wohnmobilie etc. für Export, Zustand egal, zahle Höchstpreisesofort Bargeld, bitte alles anbieten, jederzeit erreichbar. 0151/71872306 Tel.: 06258/5089921 Aktion: WirkaufenIhrAutoegal,ob Motorschaden,hoherKilometerstand odersonstigeMängel.WirsindanjedemFahrzeuginteressiert!EinAnruf schadetnicht. Telefon(0163)7940925 WOHNWAGEN/CARAVAN 36/37WW Wir kaufen Wohnmobile + Wohnwagen. Tel. (0 39 44) 3 61 60 www.wm-aw.de Fa. rh22mi19 Sie haben ein Auto und wissen nicht wohin? Dann rufen Sie mich an! Ihre Partnerin kauft Ihr Fahrzeug von Top bis Schrott. Lisa Rathmacher Tel. (01 76) 89 10 21 30 www.lr-automobile.de 22_02s WOHNWAGEN/CARAVAN 36/37WW Wir kaufen Wohnmobile + Wohnwagen. Tel. (0 39 44) 3 61 60 www.wm-aw.de Fa. rh22mi19 IMMOBILIENANGEBOTE 1100
MitsubishiGalloperV64x4 Bj.99,179tkm,VHB3.900,-EUR. Telefon(06243)5651 Trapezbleche 1. Wahl und Sonderposten aus eigener Produktion, TOP-Preise, cm-genau 98646 Eishausen, Straße in der Neustadt 107 bundesweite Lieferung, ☎ 03685/40914-0 5% Online-Rabatt sichern www.dachbleche24.de Trödelmarkt JEDER KANN MITMACHEN AUCH OHNE ANMELDUNG! Tel.: 02401 - 80 488 50 www.melan.de 3 Meter Trödel 15€ & 3 Meter Neuware 30€ JEDEN SAMSTAG - VON 14 - 19 UHR! Biete fachgerechte Baumfällung und Heckenschnitt an. Tel: 0171-188 41 49
orig. Zeitung von jedem Tag, Jahrgangs-Weine von jedem Jahr 1900-2022.HISTORIA Tel. 0761-79027900 www.historia.net
Margit, 72 J., gesunde Witwe, gutauss. u. aus Einsamkeit oft ganz traurig. Zu gerne hätte ich noch einmal einen vertrauensvollen Partner um dem Alleinsein zu entrinnen. In wenigen Tagen ist Weihnachten. Rufen Sie üb. pv an u. lassen Sie uns alles Weitere persönl. besprechen. Tel. 0176-34498648 62 41) 69 61 Sachverständige für Immobilienbewertung D2 Mitglied im Immobilienverband Deutschland